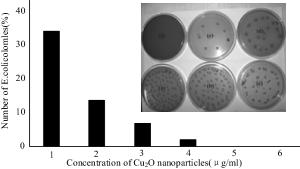

2022 Vol.35
Display Mode: |
2022, 35: 1.
doi: 10.1186/s10033-021-00666-0
Abstract:
It is a striking fact that the path tracking accuracy of autonomous vehicles based on active front wheel steering is poor under high-speed and large-curvature conditions. In this study, an adaptive path tracking control strategy that coordinates active front wheel steering and direct yaw moment is proposed based on model predictive control algorithm. The recursive least square method with a forgetting factor is used to identify the rear tire cornering stiffness and update the path tracking system prediction model. To adaptively adjust the priorities of path tracking accuracy and vehicle stability, an adaptive strategy based on fuzzy rules is applied to change the weight coefficients in the cost function. An adaptive control strategy for coordinating active front steering and direct yaw moment is proposed to improve the path tracking accuracy under high-speed and large-curvature conditions. To ensure vehicle stability, the sideslip angle, yaw rate and zero moment methods are used to construct optimization constraints based on the model predictive control frame. It is verified through simulation experiments that the proposed adaptive coordinated control strategy can improve the path tracking accuracy and ensure vehicle stability under high-speed and large-curvature conditions.
It is a striking fact that the path tracking accuracy of autonomous vehicles based on active front wheel steering is poor under high-speed and large-curvature conditions. In this study, an adaptive path tracking control strategy that coordinates active front wheel steering and direct yaw moment is proposed based on model predictive control algorithm. The recursive least square method with a forgetting factor is used to identify the rear tire cornering stiffness and update the path tracking system prediction model. To adaptively adjust the priorities of path tracking accuracy and vehicle stability, an adaptive strategy based on fuzzy rules is applied to change the weight coefficients in the cost function. An adaptive control strategy for coordinating active front steering and direct yaw moment is proposed to improve the path tracking accuracy under high-speed and large-curvature conditions. To ensure vehicle stability, the sideslip angle, yaw rate and zero moment methods are used to construct optimization constraints based on the model predictive control frame. It is verified through simulation experiments that the proposed adaptive coordinated control strategy can improve the path tracking accuracy and ensure vehicle stability under high-speed and large-curvature conditions.
2022, 35: 4.
doi: 10.1186/s10033-021-00668-y
Abstract:
Aging diagnosis of batteries is essential to ensure that the energy storage systems operate within a safe region. This paper proposes a novel cell to pack health and lifetime prognostics method based on the combination of transferred deep learning and Gaussian process regression. General health indicators are extracted from the partial discharge process. The sequential degradation model of the health indicator is developed based on a deep learning framework and is migrated for the battery pack degradation prediction. The future degraded capacities of both battery pack and each battery cell are probabilistically predicted to provide a comprehensive lifetime prognostic. Besides, only a few separate battery cells in the source domain and early data of battery packs in the target domain are needed for model construction. Experimental results show that the lifetime prediction errors are less than 25 cycles for the battery pack, even with only 50 cycles for model fine-tuning, which can save about 90% time for the aging experiment. Thus, it largely reduces the time and labor for battery pack investigation. The predicted capacity trends of the battery cells connected in the battery pack accurately reflect the actual degradation of each battery cell, which can reveal the weakest cell for maintenance in advance.
Aging diagnosis of batteries is essential to ensure that the energy storage systems operate within a safe region. This paper proposes a novel cell to pack health and lifetime prognostics method based on the combination of transferred deep learning and Gaussian process regression. General health indicators are extracted from the partial discharge process. The sequential degradation model of the health indicator is developed based on a deep learning framework and is migrated for the battery pack degradation prediction. The future degraded capacities of both battery pack and each battery cell are probabilistically predicted to provide a comprehensive lifetime prognostic. Besides, only a few separate battery cells in the source domain and early data of battery packs in the target domain are needed for model construction. Experimental results show that the lifetime prediction errors are less than 25 cycles for the battery pack, even with only 50 cycles for model fine-tuning, which can save about 90% time for the aging experiment. Thus, it largely reduces the time and labor for battery pack investigation. The predicted capacity trends of the battery cells connected in the battery pack accurately reflect the actual degradation of each battery cell, which can reveal the weakest cell for maintenance in advance.
2022, 35: 8.
doi: 10.1186/s10033-021-00670-4
Abstract:
Electric load simulator (ELS) systems are employed for electric power steering (EPS) test benches to load rack force by precise control. Precise ELS control is strongly influenced by nonlinear factors. When the steering motor rapidly rotates, extra force is directly superimposed on the original static loading error, which becomes one of the main sources of the final error. It is key to achieve ELS precise loading control for the entire EPS test bench. Therefore, a three-part compound control algorithm is proposed to improve the loading accuracy. First, a fuzzy proportional–integral plus feedforward controller with force feedback is presented. Second, a friction compensation algorithm is established to reduce the influence of friction. Then, the relationships between each quantity and the extra force are analyzed when the steering motor rapidly rotates, and a net torque feedforward compensation algorithm is proposed to eliminate the extra force. The compound control algorithm was verified through simulations and experiments. The results show that the tracking performance of the compound control algorithm satisfies the demands of engineering practice, and the extra force in the ELS system can be suppressed by the net torque corresponding to the actuator's acceleration.
Electric load simulator (ELS) systems are employed for electric power steering (EPS) test benches to load rack force by precise control. Precise ELS control is strongly influenced by nonlinear factors. When the steering motor rapidly rotates, extra force is directly superimposed on the original static loading error, which becomes one of the main sources of the final error. It is key to achieve ELS precise loading control for the entire EPS test bench. Therefore, a three-part compound control algorithm is proposed to improve the loading accuracy. First, a fuzzy proportional–integral plus feedforward controller with force feedback is presented. Second, a friction compensation algorithm is established to reduce the influence of friction. Then, the relationships between each quantity and the extra force are analyzed when the steering motor rapidly rotates, and a net torque feedforward compensation algorithm is proposed to eliminate the extra force. The compound control algorithm was verified through simulations and experiments. The results show that the tracking performance of the compound control algorithm satisfies the demands of engineering practice, and the extra force in the ELS system can be suppressed by the net torque corresponding to the actuator's acceleration.
2022, 35: 9.
doi: 10.1186/s10033-022-00676-6
Abstract:
To integrate driver experience and heterogeneous vehicle platform characteristics in a motion-planning algorithm, based on the driver-behavior-based transferable motion primitives (MPs), a general motion-planning framework for offline generation and online selection of MPs is proposed. Optimal control theory is applied to solve the boundary value problems in the process of generating MPs, where the driver behaviors and the vehicle motion characteristics are integrated into the optimization in the form of constraints. Moreover, a layered, unequal-weighted MP selection framework is proposed that utilizes a combination of environmental constraints, nonholonomic vehicle constraints, trajectory smoothness, and collision risk as the single-step extension evaluation index. The library of MPs generated offline demonstrates that the proposed generation method realizes the effective expansion of MP types and achieves diverse generation of MPs with various velocity attributes and platform types. We also present how the MP selection algorithm utilizes a unique MP library to achieve online extension of MP sequences. The results show that the proposed motion-planning framework can not only improve the efficiency and rationality of the algorithm based on driving experience but can also transfer between heterogeneous vehicle platforms and highlight the unique motion characteristics of the platform.
To integrate driver experience and heterogeneous vehicle platform characteristics in a motion-planning algorithm, based on the driver-behavior-based transferable motion primitives (MPs), a general motion-planning framework for offline generation and online selection of MPs is proposed. Optimal control theory is applied to solve the boundary value problems in the process of generating MPs, where the driver behaviors and the vehicle motion characteristics are integrated into the optimization in the form of constraints. Moreover, a layered, unequal-weighted MP selection framework is proposed that utilizes a combination of environmental constraints, nonholonomic vehicle constraints, trajectory smoothness, and collision risk as the single-step extension evaluation index. The library of MPs generated offline demonstrates that the proposed generation method realizes the effective expansion of MP types and achieves diverse generation of MPs with various velocity attributes and platform types. We also present how the MP selection algorithm utilizes a unique MP library to achieve online extension of MP sequences. The results show that the proposed motion-planning framework can not only improve the efficiency and rationality of the algorithm based on driving experience but can also transfer between heterogeneous vehicle platforms and highlight the unique motion characteristics of the platform.
2022, 35: 20.
doi: 10.1186/s10033-022-00690-8
Abstract:
The synchronizer is a key component of automatic mechanical transmission (AMT) equipped in electric vehicles, but the inertial lock-ring synchronizer (ILRS) commonly used there is not suitable especially for pure electric vehicles without a clutch because of big shift impact. To make the shifting process rapid and smooth, a new synchronizer named pressure-controllable friction ring synchronizer (PCFRS) was designed. Initially, the inevitable shortcoming of ILRS was verified by simulation and test. Furthermore, the mechanical characteristics and advantages of the new synchronizer over ILRS were analyzed. Then, the formulations describing the dynamic transmission based on the working mechanism of the PCFRS were established. Finally, the shifting simulation results with PCFRS and ILRS based on the same operating conditions were compared and analyzed. The research shows that the PCFRS can meet the main shifting evaluation index of an AMT without complex control methods, as well as it takes only 0.2406 s to finish the comfortable and zero-speed-difference shifting. The shifting quality of PCFRS is better than that of the ILRS. It lays a foundation for using the new synchronizer as a part of clutchless AMTs equipped in pure electric vehicles.
The synchronizer is a key component of automatic mechanical transmission (AMT) equipped in electric vehicles, but the inertial lock-ring synchronizer (ILRS) commonly used there is not suitable especially for pure electric vehicles without a clutch because of big shift impact. To make the shifting process rapid and smooth, a new synchronizer named pressure-controllable friction ring synchronizer (PCFRS) was designed. Initially, the inevitable shortcoming of ILRS was verified by simulation and test. Furthermore, the mechanical characteristics and advantages of the new synchronizer over ILRS were analyzed. Then, the formulations describing the dynamic transmission based on the working mechanism of the PCFRS were established. Finally, the shifting simulation results with PCFRS and ILRS based on the same operating conditions were compared and analyzed. The research shows that the PCFRS can meet the main shifting evaluation index of an AMT without complex control methods, as well as it takes only 0.2406 s to finish the comfortable and zero-speed-difference shifting. The shifting quality of PCFRS is better than that of the ILRS. It lays a foundation for using the new synchronizer as a part of clutchless AMTs equipped in pure electric vehicles.
2022, 35: 23.
doi: 10.1186/s10033-022-00692-6
Abstract:
Operational transfer path analysis (OTPA) is an advanced vibration and noise transfer path identification and contribution evaluation method. However, the application of OTPA to rail transit vehicles considers only the excitation amplitude and ignores the influence of the excitation phase. This study considers the influence of the excitation amplitude and phase, and analyzes the contribution of the secondary suspension path to the floor vibration when the metro vehicle runs at 60 km/h, using an analysis based on the OTPA method. The results show that the vertical direction of the anti-rolling torsion bar area provides the maximum contribution to the floor vibration, with a contribution of 22.1%, followed by the longitudinal vibration of the air spring area, with a contribution of 17.1%. Based on the contribution analysis, a transfer path optimization scheme is proposed, which may provide a reference for the optimization of the transfer path of metro vehicles in the future.
Operational transfer path analysis (OTPA) is an advanced vibration and noise transfer path identification and contribution evaluation method. However, the application of OTPA to rail transit vehicles considers only the excitation amplitude and ignores the influence of the excitation phase. This study considers the influence of the excitation amplitude and phase, and analyzes the contribution of the secondary suspension path to the floor vibration when the metro vehicle runs at 60 km/h, using an analysis based on the OTPA method. The results show that the vertical direction of the anti-rolling torsion bar area provides the maximum contribution to the floor vibration, with a contribution of 22.1%, followed by the longitudinal vibration of the air spring area, with a contribution of 17.1%. Based on the contribution analysis, a transfer path optimization scheme is proposed, which may provide a reference for the optimization of the transfer path of metro vehicles in the future.
2022, 35: 28.
doi: 10.1186/s10033-022-00705-4
Abstract:
In this paper, the unsteady flow around a high-speed train is numerically simulated by detached eddy simulation method (DES), and the far-field noise is predicted using the Ffowcs Williams-Hawkings (FW-H) acoustic model. The reliability of the numerical calculation is verified by wind tunnel experiments. The superposition relationship between the far-field radiated noise of the local aerodynamic noise sources of the high-speed train and the whole noise source is analyzed. Since the aerodynamic noise of high-speed trains is derived from its different components, a stepwise calculation method is proposed to predict the aerodynamic noise of high-speed trains. The results show that the local noise sources of high-speed trains and the whole noise source conform to the principle of sound source energy superposition. Using the head, middle and tail cars of the high-speed train as noise sources, different numerical models are established to obtain the far-field radiated noise of each aerodynamic noise source. The far-field total noise of high-speed trains is predicted using sound source superposition. A step-by-step calculation of each local aerodynamic noise source is used to obtain the superimposed value of the far-field noise. This is consistent with the far-field noise of the whole train model's aerodynamic noise. The averaged sound pressure level of the far-field longitudinal noise measurement points differs by 1.92 dBA. The step-by-step numerical prediction method of aerodynamic noise of high-speed trains can provide a reference for the numerical prediction of aerodynamic noise generated by long marshalling high-speed trains.
In this paper, the unsteady flow around a high-speed train is numerically simulated by detached eddy simulation method (DES), and the far-field noise is predicted using the Ffowcs Williams-Hawkings (FW-H) acoustic model. The reliability of the numerical calculation is verified by wind tunnel experiments. The superposition relationship between the far-field radiated noise of the local aerodynamic noise sources of the high-speed train and the whole noise source is analyzed. Since the aerodynamic noise of high-speed trains is derived from its different components, a stepwise calculation method is proposed to predict the aerodynamic noise of high-speed trains. The results show that the local noise sources of high-speed trains and the whole noise source conform to the principle of sound source energy superposition. Using the head, middle and tail cars of the high-speed train as noise sources, different numerical models are established to obtain the far-field radiated noise of each aerodynamic noise source. The far-field total noise of high-speed trains is predicted using sound source superposition. A step-by-step calculation of each local aerodynamic noise source is used to obtain the superimposed value of the far-field noise. This is consistent with the far-field noise of the whole train model's aerodynamic noise. The averaged sound pressure level of the far-field longitudinal noise measurement points differs by 1.92 dBA. The step-by-step numerical prediction method of aerodynamic noise of high-speed trains can provide a reference for the numerical prediction of aerodynamic noise generated by long marshalling high-speed trains.
2022, 35: 36.
doi: 10.1186/s10033-022-00696-2
Abstract:
Severe rail roughness leads to a series of problems in metro systems, particularly the vehicle noise problem. To ensure a better acoustic environment, rail roughness control is therefore one of the main concerns for the metro operators. But the existing roughness acceptance criteria are not suitable for metro interior noise control. It is an appropriate method to determine the rail roughness limit based on interior noise. A rail roughness acceptance criterion based on metro interior noise is accordingly proposed in this paper. The relationship between rail roughness and interior noise can be derived with wheel-rail noise as link. With this objective, a combined test and simulation method is adopted. A validated wheel-rfigil noise prediction model is thus established to determine the relationship between rail roughness and wheel-rail noise. Moreover, the transfer function of wheel-rail noise to interior noise is developed based on extensive field test. Using this method, the noise sensitivity to roughness wavelength and acceptance criteria at different speeds and track structures are investigated. Finally, an eclectic rail corrugation acceptance criterion on curved track is suggested in consideration of practical application.
Severe rail roughness leads to a series of problems in metro systems, particularly the vehicle noise problem. To ensure a better acoustic environment, rail roughness control is therefore one of the main concerns for the metro operators. But the existing roughness acceptance criteria are not suitable for metro interior noise control. It is an appropriate method to determine the rail roughness limit based on interior noise. A rail roughness acceptance criterion based on metro interior noise is accordingly proposed in this paper. The relationship between rail roughness and interior noise can be derived with wheel-rail noise as link. With this objective, a combined test and simulation method is adopted. A validated wheel-rfigil noise prediction model is thus established to determine the relationship between rail roughness and wheel-rail noise. Moreover, the transfer function of wheel-rail noise to interior noise is developed based on extensive field test. Using this method, the noise sensitivity to roughness wavelength and acceptance criteria at different speeds and track structures are investigated. Finally, an eclectic rail corrugation acceptance criterion on curved track is suggested in consideration of practical application.
2022, 35: 46.
doi: 10.1186/s10033-022-00706-3
Abstract:
The driver-automation shared driving is a transition to fully-autonomous driving, in which human driver and vehicular controller cooperatively share the control authority. This paper investigates the shared steering control of semi-autonomous vehicles with uncertainty from imprecise parameter. By considering driver's lane-keeping behavior on the vehicle system, a driver-automation shared driving model is introduced for control purpose. Based on the interval type-2 (IT2) fuzzy theory, moreover, the driver-automation shared driving model with uncertainty from imprecise parameter is described using an IT2 fuzzy model. After that, the corresponding IT2 fuzzy controller is designed and a direct Lyapunov method is applied to analyze the system stability. In this work, sufficient design conditions in terms of linear matrix inequalities are derived, to guarantee the closed-loop stability of the driver-automation shared control system. In addition, an H∞ performance is studied to ensure the robustness of control system. Finally, simulation-based results are provided to demonstrate the performance of proposed control method. Furthermore, an existing type-1 fuzzy controller is introduced as comparison to verify the superiority of the proposed IT2 fuzzy controller.
The driver-automation shared driving is a transition to fully-autonomous driving, in which human driver and vehicular controller cooperatively share the control authority. This paper investigates the shared steering control of semi-autonomous vehicles with uncertainty from imprecise parameter. By considering driver's lane-keeping behavior on the vehicle system, a driver-automation shared driving model is introduced for control purpose. Based on the interval type-2 (IT2) fuzzy theory, moreover, the driver-automation shared driving model with uncertainty from imprecise parameter is described using an IT2 fuzzy model. After that, the corresponding IT2 fuzzy controller is designed and a direct Lyapunov method is applied to analyze the system stability. In this work, sufficient design conditions in terms of linear matrix inequalities are derived, to guarantee the closed-loop stability of the driver-automation shared control system. In addition, an H∞ performance is studied to ensure the robustness of control system. Finally, simulation-based results are provided to demonstrate the performance of proposed control method. Furthermore, an existing type-1 fuzzy controller is introduced as comparison to verify the superiority of the proposed IT2 fuzzy controller.
2022, 35: 47.
doi: 10.1186/s10033-022-00725-0
Abstract:
In this study, a dynamic model for the bearing rotor system of a high-speed train under variable speed conditions is established. In contrast to previous studies, the contact stress is simplified in the proposed model and the compensation balance excitation caused by the rotor mass eccentricity considered. The angle iteration method is used to overcome the challenge posed by the inability to determine the roller space position during bearing rotation. The simulation results show that the model accurately describes the dynamics of bearings under varying speed profiles that contain acceleration, deceleration, and speed oscillation stages. The order ratio spectrum of the bearing vibration signal indicates that both the single and multiple frequencies in the simulation results are consistent with the theoretical results. Experiments on bearings with outer and inner ring faults under various operating conditions are performed to verify the developed model.
In this study, a dynamic model for the bearing rotor system of a high-speed train under variable speed conditions is established. In contrast to previous studies, the contact stress is simplified in the proposed model and the compensation balance excitation caused by the rotor mass eccentricity considered. The angle iteration method is used to overcome the challenge posed by the inability to determine the roller space position during bearing rotation. The simulation results show that the model accurately describes the dynamics of bearings under varying speed profiles that contain acceleration, deceleration, and speed oscillation stages. The order ratio spectrum of the bearing vibration signal indicates that both the single and multiple frequencies in the simulation results are consistent with the theoretical results. Experiments on bearings with outer and inner ring faults under various operating conditions are performed to verify the developed model.
2022, 35: 54.
doi: 10.1186/s10033-022-00745-w
Abstract:
There is an increasing awareness of the need to reduce traffic accidents and fatality due to vehicle collision. Post-impact hazards can be more serious as the driver may fail to maintain effective control after collisions. To avoid subsequent crash events and to stabilize the vehicle, this paper proposes a post-impact motion planning and stability control method for autonomous vehicles. An enabling motion planning method is proposed for post-impact situations by combining the polynomial curve and artificial potential field while considering obstacle avoidance. A hierarchical controller that consists of an upper and a lower controller is then developed to track the planned motion. In the upper controller, a time-varying linear quadratic regulator is presented to calculate the desired generalized forces. In the lower controller, a nonlinear-optimization-based torque allocation algorithm is proposed to optimally coordinate the actuators to realize the desired generalized forces. The proposed scheme is verified under comprehensive driving scenarios through hardware-in-loop tests.
There is an increasing awareness of the need to reduce traffic accidents and fatality due to vehicle collision. Post-impact hazards can be more serious as the driver may fail to maintain effective control after collisions. To avoid subsequent crash events and to stabilize the vehicle, this paper proposes a post-impact motion planning and stability control method for autonomous vehicles. An enabling motion planning method is proposed for post-impact situations by combining the polynomial curve and artificial potential field while considering obstacle avoidance. A hierarchical controller that consists of an upper and a lower controller is then developed to track the planned motion. In the upper controller, a time-varying linear quadratic regulator is presented to calculate the desired generalized forces. In the lower controller, a nonlinear-optimization-based torque allocation algorithm is proposed to optimally coordinate the actuators to realize the desired generalized forces. The proposed scheme is verified under comprehensive driving scenarios through hardware-in-loop tests.
2022, 35: 59.
doi: 10.1186/s10033-022-00726-z
Abstract:
There may be several internal defects in railway track work that have different shapes and distribution rules, and these defects affect the safety of high-speed trains. Establishing reliable detection models and methods for these internal defects remains a challenging task. To address this challenge, in this study, an intelligent detection method based on a generalization feature cluster is proposed for internal defects of railway tracks. First, the defects are classified and counted according to their shape and location features. Then, generalized features of the internal defects are extracted and formulated based on the maximum difference between different types of defects and the maximum tolerance among same defects' types. Finally, the extracted generalized features are expressed by function constraints, and formulated as generalization feature clusters to classify and identify internal defects in the railway track. Furthermore, to improve the detection reliability and speed, a reduced-dimension method of the generalization feature clusters is presented in this paper. Based on this reduced-dimension feature and strongly constrained generalized features, the K-means clustering algorithm is developed for defect clustering, and good clustering results are achieved. Regarding the defects in the rail head region, the clustering accuracy is over 95%, and the Davies-Bouldin index (DBI) index is negligible, which indicates the validation of the proposed generalization features with strong constraints. Experimental results prove that the accuracy of the proposed method based on generalization feature clusters is up to 97.55%, and the average detection time is 0.12 s/frame, which indicates that it performs well in adaptability, high accuracy, and detection speed under complex working environments. The proposed algorithm can effectively detect internal defects in railway tracks using an established generalization feature cluster model.
There may be several internal defects in railway track work that have different shapes and distribution rules, and these defects affect the safety of high-speed trains. Establishing reliable detection models and methods for these internal defects remains a challenging task. To address this challenge, in this study, an intelligent detection method based on a generalization feature cluster is proposed for internal defects of railway tracks. First, the defects are classified and counted according to their shape and location features. Then, generalized features of the internal defects are extracted and formulated based on the maximum difference between different types of defects and the maximum tolerance among same defects' types. Finally, the extracted generalized features are expressed by function constraints, and formulated as generalization feature clusters to classify and identify internal defects in the railway track. Furthermore, to improve the detection reliability and speed, a reduced-dimension method of the generalization feature clusters is presented in this paper. Based on this reduced-dimension feature and strongly constrained generalized features, the K-means clustering algorithm is developed for defect clustering, and good clustering results are achieved. Regarding the defects in the rail head region, the clustering accuracy is over 95%, and the Davies-Bouldin index (DBI) index is negligible, which indicates the validation of the proposed generalization features with strong constraints. Experimental results prove that the accuracy of the proposed method based on generalization feature clusters is up to 97.55%, and the average detection time is 0.12 s/frame, which indicates that it performs well in adaptability, high accuracy, and detection speed under complex working environments. The proposed algorithm can effectively detect internal defects in railway tracks using an established generalization feature cluster model.
2022, 35: 71.
doi: 10.1186/s10033-022-00748-7
Abstract:
The cooperation between an autonomous vehicle and a nearby vehicle is critical to ensure driving safety in the lane-exchanging scenario. The nearby vehicle trajectory needs to be predicted, from which the autonomous vehicle is controlled to prevent possible collisions. This paper proposes a lane-exchanging driving strategy for the autonomous vehicle to cooperate with the nearby vehicle by integrating vehicle trajectory prediction and motion control. A trajectory prediction method is developed to anticipate the nearby vehicle trajectory. The Gaussian mixture model (GMM), together with the vehicle kinematic model, are synthesized to predict the nearby vehicle trajectory. A potential-field-based model predictive control (MPC) approach is utilized by the autonomous vehicle to conduct the lane-exchanging maneuver. The potential field of the nearby vehicle is considered in the controller design for collision avoidance. On-road driving data verification shows that the nearby vehicle trajectory can be predicted by the proposed method. CarSim® simulations validate that the autonomous vehicle can perform the lane-exchanging maneuver and avoid the nearby vehicle using the proposed driving strategy. The autonomous vehicle can thus safely perform the lane-exchanging maneuver and avoid the nearby vehicle.
The cooperation between an autonomous vehicle and a nearby vehicle is critical to ensure driving safety in the lane-exchanging scenario. The nearby vehicle trajectory needs to be predicted, from which the autonomous vehicle is controlled to prevent possible collisions. This paper proposes a lane-exchanging driving strategy for the autonomous vehicle to cooperate with the nearby vehicle by integrating vehicle trajectory prediction and motion control. A trajectory prediction method is developed to anticipate the nearby vehicle trajectory. The Gaussian mixture model (GMM), together with the vehicle kinematic model, are synthesized to predict the nearby vehicle trajectory. A potential-field-based model predictive control (MPC) approach is utilized by the autonomous vehicle to conduct the lane-exchanging maneuver. The potential field of the nearby vehicle is considered in the controller design for collision avoidance. On-road driving data verification shows that the nearby vehicle trajectory can be predicted by the proposed method. CarSim® simulations validate that the autonomous vehicle can perform the lane-exchanging maneuver and avoid the nearby vehicle using the proposed driving strategy. The autonomous vehicle can thus safely perform the lane-exchanging maneuver and avoid the nearby vehicle.
2022, 35: 72.
doi: 10.1186/s10033-022-00729-w
Abstract:
Due to quick response and large quantity of electric motor torque, the traction wheels of battery electric vehicle are easy to slip during the initial phase of starting. In this paper, a sliding mode control approach of acceleration slip regulation is designed to prevent the slip of the traction wheels. The wheel slip ratio is used as the state variable for the formulation of system dynamics model. The fuzzy algorithm is utilized to adjust the switch function of sliding mode controller. After stability and robustness analysis, the sliding mode control law is transferred into C code and downloaded into vehicle control unit, which is validated under wet and dry road conditions. The experimental results with a small overshoot and a quick response during starting indicate that the sliding mode controller has good control effect on the slip ratio regulation. This article proposes an acceleration slip regulation method that improves the safety during acceleration for battery electric vehicle.
Due to quick response and large quantity of electric motor torque, the traction wheels of battery electric vehicle are easy to slip during the initial phase of starting. In this paper, a sliding mode control approach of acceleration slip regulation is designed to prevent the slip of the traction wheels. The wheel slip ratio is used as the state variable for the formulation of system dynamics model. The fuzzy algorithm is utilized to adjust the switch function of sliding mode controller. After stability and robustness analysis, the sliding mode control law is transferred into C code and downloaded into vehicle control unit, which is validated under wet and dry road conditions. The experimental results with a small overshoot and a quick response during starting indicate that the sliding mode controller has good control effect on the slip ratio regulation. This article proposes an acceleration slip regulation method that improves the safety during acceleration for battery electric vehicle.
2022, 35: 85.
doi: 10.1186/s10033-022-00755-8
Abstract:
To obtain improved comprehensive crashworthiness criteria for a B-type subway train, the influence laws of the vehicle design collision weight M and empty stroke D on the train's collision responses were investigated, and multi-objective optimization and decision-making were performed to minimize TS (total compression displacement along the moving train) and TAMA (the overall mean acceleration along the moving train). Firstly, a one-dimensional train collision dynamics model was established and verified by comparing with the results of the finite element model. Secondly, based on the dynamics model, the influence laws of M and D on the collision responses, such as the energy-absorbing devices' displacements and absorbed energy, vehicles' velocity and acceleration, TS, TAMA and the coupling correlation effect were investigated. Then, surrogate models for TS and TAMA were developed using the optimal Latin hypercube method (OLHD) and response surface method (RSM), and multi-objective optimization was conducted using the particle swarm optimization algorithm method (MPOSO). Finally, the entropy method was used to obtain the weight coefficients for TS and TAMA, and multi-objective decision-making was performed. The results indicate that D and M significantly affect the compression displacements and energy absorption of the first three collision interfaces, but have limited impact on the last three collision interfaces. The velocity versus time curves of vehicle M1 and M2 are shifted and parallel with different D. However, the velocity versus time curves of all the vehicles are shifted but gradually divergent with different M. The maximum collision instantaneous accelerations of the vehicles are directly determined by M, but are only slightly affected by D. Under the coupling effect, all concerned collision responses are strongly correlated with M; however, the responses are weakly correlated with D except for the compression displacement at the M2-M3 collision interface and the maximum collision instantaneous acceleration of vehicle M2. The comprehensive crashworthiness criteria of the B-type subway train were significantly improved after multi-objective optimization and decision-making. The research provides more theoretical and engineering application references for the subway train crashworthiness design.
To obtain improved comprehensive crashworthiness criteria for a B-type subway train, the influence laws of the vehicle design collision weight M and empty stroke D on the train's collision responses were investigated, and multi-objective optimization and decision-making were performed to minimize TS (total compression displacement along the moving train) and TAMA (the overall mean acceleration along the moving train). Firstly, a one-dimensional train collision dynamics model was established and verified by comparing with the results of the finite element model. Secondly, based on the dynamics model, the influence laws of M and D on the collision responses, such as the energy-absorbing devices' displacements and absorbed energy, vehicles' velocity and acceleration, TS, TAMA and the coupling correlation effect were investigated. Then, surrogate models for TS and TAMA were developed using the optimal Latin hypercube method (OLHD) and response surface method (RSM), and multi-objective optimization was conducted using the particle swarm optimization algorithm method (MPOSO). Finally, the entropy method was used to obtain the weight coefficients for TS and TAMA, and multi-objective decision-making was performed. The results indicate that D and M significantly affect the compression displacements and energy absorption of the first three collision interfaces, but have limited impact on the last three collision interfaces. The velocity versus time curves of vehicle M1 and M2 are shifted and parallel with different D. However, the velocity versus time curves of all the vehicles are shifted but gradually divergent with different M. The maximum collision instantaneous accelerations of the vehicles are directly determined by M, but are only slightly affected by D. Under the coupling effect, all concerned collision responses are strongly correlated with M; however, the responses are weakly correlated with D except for the compression displacement at the M2-M3 collision interface and the maximum collision instantaneous acceleration of vehicle M2. The comprehensive crashworthiness criteria of the B-type subway train were significantly improved after multi-objective optimization and decision-making. The research provides more theoretical and engineering application references for the subway train crashworthiness design.
2022, 35: 90.
doi: 10.1186/s10033-022-00762-9
Abstract:
The locomotive traction motor is described as a rotor-bearing system coupling the kinetic equations of the traction shaft and its support bearings with the determination of their elastic deformations in this study. Under the effect of excitations induced by the dynamic rotor eccentric distance and time-varying mesh stiffness, the elastic structure deformations of the shaft and support bearings are formulated in the vibration environment of the locomotive. In addition, the nonlinear contact forces between the components of the rolling bearing, the lubricating oil film, and radial clearance are comprehensively considered in this study. The results indicate that the elastic deformations of the shaft and bearings can change the dynamic responses of the traction motor and its support bearings. There are large differences between the ranges of the rotor motion calculated by the rigid and the flexible traction motor models when the intensified wheel-rail interaction is considered. With the increase of the rotor eccentricity, the results underscore the role of the elasticity of traction shaft and support bearings in dynamic researches of the traction motor. The critical value of the initial eccentric distance for the rub-impact phenomenon decreases from 1.23 mm to 1.15 mm considering the flexible effect of the shaft and bearings. This dynamics model of the traction motor can provide more accurate and reasonable simulation results for correlational dynamic researches.
The locomotive traction motor is described as a rotor-bearing system coupling the kinetic equations of the traction shaft and its support bearings with the determination of their elastic deformations in this study. Under the effect of excitations induced by the dynamic rotor eccentric distance and time-varying mesh stiffness, the elastic structure deformations of the shaft and support bearings are formulated in the vibration environment of the locomotive. In addition, the nonlinear contact forces between the components of the rolling bearing, the lubricating oil film, and radial clearance are comprehensively considered in this study. The results indicate that the elastic deformations of the shaft and bearings can change the dynamic responses of the traction motor and its support bearings. There are large differences between the ranges of the rotor motion calculated by the rigid and the flexible traction motor models when the intensified wheel-rail interaction is considered. With the increase of the rotor eccentricity, the results underscore the role of the elasticity of traction shaft and support bearings in dynamic researches of the traction motor. The critical value of the initial eccentric distance for the rub-impact phenomenon decreases from 1.23 mm to 1.15 mm considering the flexible effect of the shaft and bearings. This dynamics model of the traction motor can provide more accurate and reasonable simulation results for correlational dynamic researches.
2022, 35: 93.
doi: 10.1186/s10033-022-00758-5
Abstract:
To improve the vibration isolation performance of suspensions, various new structural forms of suspensions have been proposed. However, there is uncertainty in these new structure suspensions, so the deterministic research cannot reflect the performance of the suspension under actual operating conditions. In this paper, a quasi-zero stiffness isolator is used in automotive suspensions to form a new suspension−quasi-zero stiffness air suspension (QZSAS). Due to the strong nonlinearity and structural complexity of quasi-zero stiffness suspensions, changes in structural parameters may cause dramatic changes in suspension performance, so it is of practical importance to study the effect of structural parameter uncertainty on the suspension performance. In order to solve this problem, three suspension structural parameters d0, L0 and Pc0 are selected as random variables, and the polynomial chaos expansion (PCE) theory is used to solve the suspension performance parameters. The sensitivity of the performance parameters to different structural parameters was discussed and analyzed in the frequency domain. Furthermore, a multi-objective optimization of the structural parameters d0, L0 and Pc0 of QZSAS was performed with the mean and variance of the root-mean-square (RMS) acceleration values as the optimization objectives. The optimization results show that there is an improvement of about 8%−10% in the mean value and about 40%−55% in the standard deviation of acceleration (RMS) values. This paper verifies the feasibility of the PCE method for solving the uncertainty problem of complex nonlinear systems, which provide a reference for the future structural design and optimization of such suspension systems.
To improve the vibration isolation performance of suspensions, various new structural forms of suspensions have been proposed. However, there is uncertainty in these new structure suspensions, so the deterministic research cannot reflect the performance of the suspension under actual operating conditions. In this paper, a quasi-zero stiffness isolator is used in automotive suspensions to form a new suspension−quasi-zero stiffness air suspension (QZSAS). Due to the strong nonlinearity and structural complexity of quasi-zero stiffness suspensions, changes in structural parameters may cause dramatic changes in suspension performance, so it is of practical importance to study the effect of structural parameter uncertainty on the suspension performance. In order to solve this problem, three suspension structural parameters d0, L0 and Pc0 are selected as random variables, and the polynomial chaos expansion (PCE) theory is used to solve the suspension performance parameters. The sensitivity of the performance parameters to different structural parameters was discussed and analyzed in the frequency domain. Furthermore, a multi-objective optimization of the structural parameters d0, L0 and Pc0 of QZSAS was performed with the mean and variance of the root-mean-square (RMS) acceleration values as the optimization objectives. The optimization results show that there is an improvement of about 8%−10% in the mean value and about 40%−55% in the standard deviation of acceleration (RMS) values. This paper verifies the feasibility of the PCE method for solving the uncertainty problem of complex nonlinear systems, which provide a reference for the future structural design and optimization of such suspension systems.
2022, 35: 99.
doi: 10.1186/s10033-022-00786-1
Abstract:
During the braking process, a large amount of heat energy is generated at the friction surfaces between the brake disc and pads and rapidly dissipates into the disc volume. In this paper, a three-dimensional thermo-mechanical coupling model of high-speed wheel-mounted brake discs containing bolted joints and contact relationships is established. The direct coupling method is used to analyze the temperature and stress of the brake discs during an emergency braking event with an initial speed of 300 km/h. A full-scale bench test is also conducted to monitor the temperatures of the friction ring and bolted joints. The simulation result shows that the surface temperature of the friction ring reaches its peak value of 414 ℃ after 102 s of braking, which agrees well with the bench test result. The maximum alternating thermal stress occurs in the bolt hole where the maximum circumferential compressive stress is −658 MPa and the maximum circumferential tensile stress is 134 MPa. During the braking process, the out-of-plane deformation of the middle part of the friction ring is larger than that of the edge, which increases the axial tensile load of the connecting bolt. This work provides support for the design of brake discs and connecting bolts.
During the braking process, a large amount of heat energy is generated at the friction surfaces between the brake disc and pads and rapidly dissipates into the disc volume. In this paper, a three-dimensional thermo-mechanical coupling model of high-speed wheel-mounted brake discs containing bolted joints and contact relationships is established. The direct coupling method is used to analyze the temperature and stress of the brake discs during an emergency braking event with an initial speed of 300 km/h. A full-scale bench test is also conducted to monitor the temperatures of the friction ring and bolted joints. The simulation result shows that the surface temperature of the friction ring reaches its peak value of 414 ℃ after 102 s of braking, which agrees well with the bench test result. The maximum alternating thermal stress occurs in the bolt hole where the maximum circumferential compressive stress is −658 MPa and the maximum circumferential tensile stress is 134 MPa. During the braking process, the out-of-plane deformation of the middle part of the friction ring is larger than that of the edge, which increases the axial tensile load of the connecting bolt. This work provides support for the design of brake discs and connecting bolts.
2022, 35: 100.
doi: 10.1186/s10033-022-00771-8
Abstract:
With the development of modern technology and economy, environmental protection and sustainable development have become the focus of global attention. The promotion and development of electric vehicles (EVs) have bright prospects. However, many challenges need to be faced seriously. Under different operating conditions, various safety problems of electric vehicles emerge one after another, especially the hidden danger of battery overheating which threatens the performance of electric vehicles. This paper aims to design and optimize a new indirect liquid cooling system for cylindrical lithium-ion batteries. Various design schemes for different cooling channel structures and cooling liquid inlet directions are proposed, and the corresponding solid-fluid coupling model is established. COMSOL Multiphysics simulation software is adopted to simulate and analyze the cooling systems. An approximate model is constructed using the Kriging method, which is considered to optimize the battery cooling system and improve the optimization results. Sensitivity parameter analysis and the optimization design of system structure are performed through a set of influencing factors in the battery thermal management. The results indicate that the method used in this paper can effectively reduce the maximum core temperature and balance the temperature differences of the battery pack. Compared with the original design, the optimized design, which is based on the non-dominated sorting genetic algorithm (NSGA-II), has an excellent ability in the optimized thermal management system to dissipate thermal energy and keep the overall cooling uniformity of the battery and thermal management system. Furthermore, the optimized system can also prevent thermal runaway propagation under thermal abuse conditions. In summary, this research can provide some practical suggestions and ideas for the engineering and production applications and structural optimization design carried by electric vehicles.
With the development of modern technology and economy, environmental protection and sustainable development have become the focus of global attention. The promotion and development of electric vehicles (EVs) have bright prospects. However, many challenges need to be faced seriously. Under different operating conditions, various safety problems of electric vehicles emerge one after another, especially the hidden danger of battery overheating which threatens the performance of electric vehicles. This paper aims to design and optimize a new indirect liquid cooling system for cylindrical lithium-ion batteries. Various design schemes for different cooling channel structures and cooling liquid inlet directions are proposed, and the corresponding solid-fluid coupling model is established. COMSOL Multiphysics simulation software is adopted to simulate and analyze the cooling systems. An approximate model is constructed using the Kriging method, which is considered to optimize the battery cooling system and improve the optimization results. Sensitivity parameter analysis and the optimization design of system structure are performed through a set of influencing factors in the battery thermal management. The results indicate that the method used in this paper can effectively reduce the maximum core temperature and balance the temperature differences of the battery pack. Compared with the original design, the optimized design, which is based on the non-dominated sorting genetic algorithm (NSGA-II), has an excellent ability in the optimized thermal management system to dissipate thermal energy and keep the overall cooling uniformity of the battery and thermal management system. Furthermore, the optimized system can also prevent thermal runaway propagation under thermal abuse conditions. In summary, this research can provide some practical suggestions and ideas for the engineering and production applications and structural optimization design carried by electric vehicles.
2022, 35: 104.
doi: 10.1186/s10033-022-00789-y
Abstract:
High-speed trains often use temperature sensors to monitor the motion state of bearings. However, the temperature of bearings can be affected by factors such as weather and faults. Therefore, it is necessary to analyze in detail the relationship between the bearing temperature and influencing factors. In this study, a dynamics model of the axle box bearing of high-speed trains is established. The model can obtain the contact force between the rollers and raceway and its change law when the bearing contains outer-ring, inner-ring, and rolling-element faults. Based on the model, a thermal network method is introduced to study the temperature field distribution of the axle box bearings of high-speed trains. In this model, the heat generation, conduction, and dispersion of the isothermal nodes can be solved. The results show that the temperature of the contact point between the outer-ring raceway and rolling-elements is the highest. The relationships between the node temperature and the speed, fault type, and fault size are analyzed, finding that the higher the speed, the higher the node temperature. Under different fault types, the node temperature first increases and then decreases as the fault size increases. The effectiveness of the model is demonstrated using the actual temperature data of a high-speed train. This study proposes a thermal network model that can predict the temperature of each component of the bearings on a high-speed train under various speed and fault conditions.
High-speed trains often use temperature sensors to monitor the motion state of bearings. However, the temperature of bearings can be affected by factors such as weather and faults. Therefore, it is necessary to analyze in detail the relationship between the bearing temperature and influencing factors. In this study, a dynamics model of the axle box bearing of high-speed trains is established. The model can obtain the contact force between the rollers and raceway and its change law when the bearing contains outer-ring, inner-ring, and rolling-element faults. Based on the model, a thermal network method is introduced to study the temperature field distribution of the axle box bearings of high-speed trains. In this model, the heat generation, conduction, and dispersion of the isothermal nodes can be solved. The results show that the temperature of the contact point between the outer-ring raceway and rolling-elements is the highest. The relationships between the node temperature and the speed, fault type, and fault size are analyzed, finding that the higher the speed, the higher the node temperature. Under different fault types, the node temperature first increases and then decreases as the fault size increases. The effectiveness of the model is demonstrated using the actual temperature data of a high-speed train. This study proposes a thermal network model that can predict the temperature of each component of the bearings on a high-speed train under various speed and fault conditions.
2022, 35: 120.
doi: 10.1186/s10033-022-00790-5
Abstract:
Autonomous vehicles require safe motion planning in uncertain environments, which are largely caused by surrounding vehicles. In this paper, a driving environment uncertainty-aware motion planning framework is proposed to lower the risk of position uncertainty of surrounding vehicles with considering the risk of rollover. First, a 4-degree of freedom vehicle dynamics model, and a rollover risk index are introduced. Besides, the uncertainty of surrounding vehicles' position is processed and propagated based on the Extended Kalman Filter method. Then, the uncertainty potential field is established to handle the position uncertainty of autonomous vehicles. In addition, the model predictive controller is designed as the motion planning framework which accounts for the rollover risk, the position uncertainty of the surrounding vehicles, and vehicle dynamic constraints of autonomous vehicles. Furthermore, two edge cases, the cut-in scenario, and merging scenario are designed. Finally, the safety, effectiveness, and real-time performance of the proposed motion planning framework are demonstrated by employing a hardware-in-the-loop experiment bench.
Autonomous vehicles require safe motion planning in uncertain environments, which are largely caused by surrounding vehicles. In this paper, a driving environment uncertainty-aware motion planning framework is proposed to lower the risk of position uncertainty of surrounding vehicles with considering the risk of rollover. First, a 4-degree of freedom vehicle dynamics model, and a rollover risk index are introduced. Besides, the uncertainty of surrounding vehicles' position is processed and propagated based on the Extended Kalman Filter method. Then, the uncertainty potential field is established to handle the position uncertainty of autonomous vehicles. In addition, the model predictive controller is designed as the motion planning framework which accounts for the rollover risk, the position uncertainty of the surrounding vehicles, and vehicle dynamic constraints of autonomous vehicles. Furthermore, two edge cases, the cut-in scenario, and merging scenario are designed. Finally, the safety, effectiveness, and real-time performance of the proposed motion planning framework are demonstrated by employing a hardware-in-the-loop experiment bench.
2022, 35: 134.
doi: 10.1186/s10033-022-00805-1
Abstract:
Noise, vibration and harshness (NVH) problems in vehicle engineering are always challenging in both traditional vehicles and intelligent vehicles. Although high accuracy manufacturing, modern structural roads and advanced suspension technology have already significantly reduced NVH problems and their impacts; off-road condition, obstacles and extreme operating condition could still trigger NVH problems unexpectedly. This paper proposes a vehicular electronic image stabilization (EIS) system to solve the vibration problem of the camera and ensure the environment perceptive function of vehicles. Firstly, feature point detection and matching based on an oriented FAST and rotated BRIEF (ORB) algorithm are implemented to match images in the process of EIS. Furthermore, a novel improved random sampling consensus algorithm (i-RANSAC) is proposed to eliminate mismatched feature points and increase the matching accuracy significantly. And an adaptive Kalman filter (AKF) is applied to improve the adaptability of the vehicular EIS. Finally, an experimental platform based on a gasoline model car was established to validate its performance. The experimental results show that the proposed EIS system can satisfy vehicular performance requirements even under off-road condition with obvious obstacles.
Noise, vibration and harshness (NVH) problems in vehicle engineering are always challenging in both traditional vehicles and intelligent vehicles. Although high accuracy manufacturing, modern structural roads and advanced suspension technology have already significantly reduced NVH problems and their impacts; off-road condition, obstacles and extreme operating condition could still trigger NVH problems unexpectedly. This paper proposes a vehicular electronic image stabilization (EIS) system to solve the vibration problem of the camera and ensure the environment perceptive function of vehicles. Firstly, feature point detection and matching based on an oriented FAST and rotated BRIEF (ORB) algorithm are implemented to match images in the process of EIS. Furthermore, a novel improved random sampling consensus algorithm (i-RANSAC) is proposed to eliminate mismatched feature points and increase the matching accuracy significantly. And an adaptive Kalman filter (AKF) is applied to improve the adaptability of the vehicular EIS. Finally, an experimental platform based on a gasoline model car was established to validate its performance. The experimental results show that the proposed EIS system can satisfy vehicular performance requirements even under off-road condition with obvious obstacles.
2022, 35: 136.
doi: 10.1186/s10033-022-00809-x
Abstract:
Recent developments have demonstrated that the brake pedal simulator (BPS) is becoming an indispensable apparatus for the break-by-wire systems in future electric vehicles. Its main function is to provide the driver with a comfortable pedal feel to improve braking safety and comfort. This paper presents the development and control of an adjustable BPS, using a disk-type magnetorheological (MR) damper as the passive braking reaction generator to simulate the traditional pedal feel. A detailed description of the mechanical design of the MR damper-based BSP (MRDBBPS) is presented in this paper. Several basic performance experiments on the MRDBBPS prototype are conducted. A return-to-zero (RTZ) algorithm is proposed to avoid hysteresis and improve the repeatability of the pedal force. In addition, an RTZ algorithm-based real-time current-tracking controller (RTZRC) is designed in consideration of the response lag of the coil circuit. Finally, an experimental system is established by integrating the MRDBBPS prototype into a self-developed automotive MR braking test bench (AMRBTB), and several control and braking experiments are performed. This research proposes a RTZRC control algorithm which can significantly increase the tracking accuracy of the brake pedal characteristic curve, particularly at a high pedal velocity. Additionally, the designed MRDBBPS prototype can achieve an effective and favorable control of the AMRBTB with a good repeatability.
Recent developments have demonstrated that the brake pedal simulator (BPS) is becoming an indispensable apparatus for the break-by-wire systems in future electric vehicles. Its main function is to provide the driver with a comfortable pedal feel to improve braking safety and comfort. This paper presents the development and control of an adjustable BPS, using a disk-type magnetorheological (MR) damper as the passive braking reaction generator to simulate the traditional pedal feel. A detailed description of the mechanical design of the MR damper-based BSP (MRDBBPS) is presented in this paper. Several basic performance experiments on the MRDBBPS prototype are conducted. A return-to-zero (RTZ) algorithm is proposed to avoid hysteresis and improve the repeatability of the pedal force. In addition, an RTZ algorithm-based real-time current-tracking controller (RTZRC) is designed in consideration of the response lag of the coil circuit. Finally, an experimental system is established by integrating the MRDBBPS prototype into a self-developed automotive MR braking test bench (AMRBTB), and several control and braking experiments are performed. This research proposes a RTZRC control algorithm which can significantly increase the tracking accuracy of the brake pedal characteristic curve, particularly at a high pedal velocity. Additionally, the designed MRDBBPS prototype can achieve an effective and favorable control of the AMRBTB with a good repeatability.
2022, 35: 144.
doi: 10.1186/s10033-022-00816-y
Abstract:
Two-speed clutchless automated manual transmission (AMT) has been widely implemented in electric vehicles for its simple structure and low cost. In contrast, due to the complex response characteristics of powertrain, utilizing clutchless AMT in a hybrid power system comes with complex coordination control problems. In order to address these issues, a power-split hybrid electric bus with two-speed clutchless AMT is studied in this paper, and a coordinated control method based on model predictive control (MPC) is used in gear shifting control strategy (GSCS) to improve gear shifting quality and reduce system jerk. First, the dynamic model of power sources and other main powertrain components including a single planetary gear set and AMT are established on the basis of data-driven and mechanism modeling methods. Second, the GSCS is put forward using the segmented control idea, and the shifting process is divided into five phases, including (Ⅰ) unloading of drive motor, (Ⅱ) shifting to neutral gear, (Ⅲ) active speed synchronization by drive motor, (Ⅳ) engaging to new gear, and (Ⅴ) resuming the drive motor's power, among which the phases Ⅰ and Ⅴ have evident impact on the system jerk. Then, the MPC-based control method is adopted for these phases, and the fast compensation of driving torque is realized by combining the prediction model and quadratic programming method. The simulation results show that the proposed GSCS can effectively reduce shift jerk and improve driving comfort. This research proposes a coordinated control strategy of two-speed clutchless AMT, which can effectively improve the smoothness of gear shifting and provides a reference for the application of two speed clutchless AMT in power-split hybrid powertrains.
Two-speed clutchless automated manual transmission (AMT) has been widely implemented in electric vehicles for its simple structure and low cost. In contrast, due to the complex response characteristics of powertrain, utilizing clutchless AMT in a hybrid power system comes with complex coordination control problems. In order to address these issues, a power-split hybrid electric bus with two-speed clutchless AMT is studied in this paper, and a coordinated control method based on model predictive control (MPC) is used in gear shifting control strategy (GSCS) to improve gear shifting quality and reduce system jerk. First, the dynamic model of power sources and other main powertrain components including a single planetary gear set and AMT are established on the basis of data-driven and mechanism modeling methods. Second, the GSCS is put forward using the segmented control idea, and the shifting process is divided into five phases, including (Ⅰ) unloading of drive motor, (Ⅱ) shifting to neutral gear, (Ⅲ) active speed synchronization by drive motor, (Ⅳ) engaging to new gear, and (Ⅴ) resuming the drive motor's power, among which the phases Ⅰ and Ⅴ have evident impact on the system jerk. Then, the MPC-based control method is adopted for these phases, and the fast compensation of driving torque is realized by combining the prediction model and quadratic programming method. The simulation results show that the proposed GSCS can effectively reduce shift jerk and improve driving comfort. This research proposes a coordinated control strategy of two-speed clutchless AMT, which can effectively improve the smoothness of gear shifting and provides a reference for the application of two speed clutchless AMT in power-split hybrid powertrains.
2022, 35: 146.
doi: 10.1186/s10033-022-00820-2
Abstract:
Engine mount system affects the automobile NVH performance. Active mounts would achieve excellent vibration isolation and relative displacement control performance in a broad frequency bandwidth by outputting controlled force to the mounting system. The actuator and control method of the active mounts determine the system performance. In this paper, an active mount based on the smart material, i.e., Terfenol-D rod, is proposed, which mainly includes three parts: rubber spring, magnetostrictive actuator (MA), and hydraulic amplification mechanism (HAM). Dynamic model of the active mount is correspondingly established. A state feedback control method based on x-LMS (Least-Mean-Square) algorithm is proposed as well. Specifically, with the consideration of the unmeasurable state parameters in the active mounting system, an x-LMS state feedback controller with the system state as the reference signal is constructed by employing Sage-Husa Kalman filter to realize the state estimation of the active mounting system. Then a detailed analysis of the proposed control method is conducted, with deriving iterative formula of tap-weight vector. Sequentially, the problem of the dependence on the excitation signal in the x-LMS algorithm is addressed. The feasibility and capability of the proposed control method are verified and evaluated by simulation of a two-degree-of-freedom active mounting system.
Engine mount system affects the automobile NVH performance. Active mounts would achieve excellent vibration isolation and relative displacement control performance in a broad frequency bandwidth by outputting controlled force to the mounting system. The actuator and control method of the active mounts determine the system performance. In this paper, an active mount based on the smart material, i.e., Terfenol-D rod, is proposed, which mainly includes three parts: rubber spring, magnetostrictive actuator (MA), and hydraulic amplification mechanism (HAM). Dynamic model of the active mount is correspondingly established. A state feedback control method based on x-LMS (Least-Mean-Square) algorithm is proposed as well. Specifically, with the consideration of the unmeasurable state parameters in the active mounting system, an x-LMS state feedback controller with the system state as the reference signal is constructed by employing Sage-Husa Kalman filter to realize the state estimation of the active mounting system. Then a detailed analysis of the proposed control method is conducted, with deriving iterative formula of tap-weight vector. Sequentially, the problem of the dependence on the excitation signal in the x-LMS algorithm is addressed. The feasibility and capability of the proposed control method are verified and evaluated by simulation of a two-degree-of-freedom active mounting system.
2022, 35: 150.
doi: 10.1186/s10033-022-00823-z
Abstract:
Proper braking force distribution strategies can improve both stability and economy performance of hybrid electric vehicles, which is prominently proved by many studies. To achieve better dynamic stable performance and higher energy recovery efficiency, an effective braking control strategy for hybrid electric buses (HEB) based on vehicle mass and road slope estimation is proposed in this paper. Firstly, the road slope and the vehicle mass are estimated by a hybrid algorithm of extended Kalman filter (EKF) and recursive least square (RLS). Secondly, the total braking torque of HEB is calculated by the sliding mode controller (SMC), which uses the information of brake intensity, whole vehicle mass, and road slope. Finally, comprehensively considering driver's braking intention and regulations of the Economic Commission for Europe (ECE), the optimal proportional relationship between regenerative braking and pneumatic braking is obtained. Furthermore, related simulations and experiments are carried out on the hardware-in-the-loop test bench. Results show that the proposed strategy can effectively improve the braking performance and increase the recovered energy through precise control of the braking torque.
Proper braking force distribution strategies can improve both stability and economy performance of hybrid electric vehicles, which is prominently proved by many studies. To achieve better dynamic stable performance and higher energy recovery efficiency, an effective braking control strategy for hybrid electric buses (HEB) based on vehicle mass and road slope estimation is proposed in this paper. Firstly, the road slope and the vehicle mass are estimated by a hybrid algorithm of extended Kalman filter (EKF) and recursive least square (RLS). Secondly, the total braking torque of HEB is calculated by the sliding mode controller (SMC), which uses the information of brake intensity, whole vehicle mass, and road slope. Finally, comprehensively considering driver's braking intention and regulations of the Economic Commission for Europe (ECE), the optimal proportional relationship between regenerative braking and pneumatic braking is obtained. Furthermore, related simulations and experiments are carried out on the hardware-in-the-loop test bench. Results show that the proposed strategy can effectively improve the braking performance and increase the recovered energy through precise control of the braking torque.
2022, 35: 2.
doi: 10.1186/s10033-021-00665-1
Abstract:
To accommodate the gait and balance disorder of the elderly with age progression and the occurrence of various senile diseases, this paper proposes a novel gait balance training robot (G-Balance) based on a six degree-of-freedom parallel platform. Using the platform movement and IMU wearable sensors, two training modes, i.e., active and passive, are developed to achieve vestibular stimulation. Virtual reality technology is applied to achieve visual stimulation. In the active training mode, the elderly actively exercises to control the posture change of the platform and the switching of the virtual scene. In the passive training mode, the platform movement is combined with the virtual scene to simulate bumpy environments, such as earthquakes, to enhance the human anti-interference ability. To achieve a smooth switching of the scene, continuous speed and acceleration of the platform motion are required in some scenarios, in which a trajectory planning algorithm is applied. This paper describes the application of the trajectory planning algorithm in the balance training mode and the optimization of jerk (differential of acceleration) based on cubic spline planning, which can reduce impact on the joint and enhance stability.
To accommodate the gait and balance disorder of the elderly with age progression and the occurrence of various senile diseases, this paper proposes a novel gait balance training robot (G-Balance) based on a six degree-of-freedom parallel platform. Using the platform movement and IMU wearable sensors, two training modes, i.e., active and passive, are developed to achieve vestibular stimulation. Virtual reality technology is applied to achieve visual stimulation. In the active training mode, the elderly actively exercises to control the posture change of the platform and the switching of the virtual scene. In the passive training mode, the platform movement is combined with the virtual scene to simulate bumpy environments, such as earthquakes, to enhance the human anti-interference ability. To achieve a smooth switching of the scene, continuous speed and acceleration of the platform motion are required in some scenarios, in which a trajectory planning algorithm is applied. This paper describes the application of the trajectory planning algorithm in the balance training mode and the optimization of jerk (differential of acceleration) based on cubic spline planning, which can reduce impact on the joint and enhance stability.
2022, 35: 7.
doi: 10.1186/s10033-021-00669-x
Abstract:
Robot manipulators perform a point-point task under kinematic and dynamic constraints. Due to multi-degree-of-freedom coupling characteristics, it is difficult to find a better desired trajectory. In this paper, a multi-objective trajectory planning approach based on an improved elitist non-dominated sorting genetic algorithm (INSGA-II) is proposed. Trajectory function is planned with a new composite polynomial that by combining of quintic polynomials with cubic Bezier curves. Then, an INSGA-II, by introducing three genetic operators: ranking group selection (RGS), direction-based crossover (DBX) and adaptive precision-controllable mutation (APCM), is developed to optimize travelling time and torque fluctuation. Inverted generational distance, hypervolume and optimizer overhead are selected to evaluate the convergence, diversity and computational effort of algorithms. The optimal solution is determined via fuzzy comprehensive evaluation to obtain the optimal trajectory. Taking a serial-parallel hybrid manipulator as instance, the velocity and acceleration profiles obtained using this composite polynomial are compared with those obtained using a quintic B-spline method. The effectiveness and practicability of the proposed method are verified by simulation results. This research proposes a trajectory optimization method which can offer a better solution with efficiency and stability for a point-to-point task of robot manipulators.
Robot manipulators perform a point-point task under kinematic and dynamic constraints. Due to multi-degree-of-freedom coupling characteristics, it is difficult to find a better desired trajectory. In this paper, a multi-objective trajectory planning approach based on an improved elitist non-dominated sorting genetic algorithm (INSGA-II) is proposed. Trajectory function is planned with a new composite polynomial that by combining of quintic polynomials with cubic Bezier curves. Then, an INSGA-II, by introducing three genetic operators: ranking group selection (RGS), direction-based crossover (DBX) and adaptive precision-controllable mutation (APCM), is developed to optimize travelling time and torque fluctuation. Inverted generational distance, hypervolume and optimizer overhead are selected to evaluate the convergence, diversity and computational effort of algorithms. The optimal solution is determined via fuzzy comprehensive evaluation to obtain the optimal trajectory. Taking a serial-parallel hybrid manipulator as instance, the velocity and acceleration profiles obtained using this composite polynomial are compared with those obtained using a quintic B-spline method. The effectiveness and practicability of the proposed method are verified by simulation results. This research proposes a trajectory optimization method which can offer a better solution with efficiency and stability for a point-to-point task of robot manipulators.
2022, 35: 13.
doi: 10.1186/s10033-021-00671-3
Abstract:
The water-lubricated bearings are usually the state of turbulent cavitating flow under high-speed conditions. And the distribution of cavitation bubbles and the interface effect between the two phases have not been included in previous studies on high-speed water-lubricated bearings. In order to study the influence of interface effect and cavitation bubble distribution on the dynamic characteristics of high-speed water-lubricated spiral groove thrust bearings (SGTB).A turbulent cavitating flow lubrication model based on two-phase fluid and population balance equation of bubbles was established in this paper. Stiffness and the damping coefficients of the SGTB were calculated using the perturbation pressure equations. An experimental apparatus was developed to verify the theoretical model. Simulating and experimental results show that the small-sized bubbles tend to generate in the turbulent cavitating flow when at a high rotary speed, and the bubbles mainly locate at the edges of the spiral groove. The simulating results also show that the direct stiffness coefficients are increased due to cavitation effect, and cross stiffness coefficients and damping coefficients are hardly affected by the cavitation effect. Turbulent effect on the dynamic characteristics of SGTB is much stronger than the cavitating effect
The water-lubricated bearings are usually the state of turbulent cavitating flow under high-speed conditions. And the distribution of cavitation bubbles and the interface effect between the two phases have not been included in previous studies on high-speed water-lubricated bearings. In order to study the influence of interface effect and cavitation bubble distribution on the dynamic characteristics of high-speed water-lubricated spiral groove thrust bearings (SGTB).A turbulent cavitating flow lubrication model based on two-phase fluid and population balance equation of bubbles was established in this paper. Stiffness and the damping coefficients of the SGTB were calculated using the perturbation pressure equations. An experimental apparatus was developed to verify the theoretical model. Simulating and experimental results show that the small-sized bubbles tend to generate in the turbulent cavitating flow when at a high rotary speed, and the bubbles mainly locate at the edges of the spiral groove. The simulating results also show that the direct stiffness coefficients are increased due to cavitation effect, and cross stiffness coefficients and damping coefficients are hardly affected by the cavitation effect. Turbulent effect on the dynamic characteristics of SGTB is much stronger than the cavitating effect
2022, 35: 16.
doi: 10.1186/s10033-022-00679-3
Abstract:
Because of their elastic links and joints, high-speed parallel robots for pick-and-place operations inevitably suffer from residual vibrations that significantly degrade their positioning accuracy. An effective approach based on the input shaping technique is presented in this paper for suppressing the residual vibration in these parallel robots. After addressing the design principle of an input shaper for a parallel robot with flexible actuated joints, a robust optimal input shaper is developed by considering the configuration-dependent flexible modes and minimizing the maximum percentage of residual vibration at the end-effector. The input shaper allows a good overall performance to be achieved throughout the entire workspace. Experimental results on a 4-DOF SCARA-type parallel robot show that the residual vibration of the end-effector is dramatically reduced and the dynamic positioning accuracy of the robot significantly improved.
Because of their elastic links and joints, high-speed parallel robots for pick-and-place operations inevitably suffer from residual vibrations that significantly degrade their positioning accuracy. An effective approach based on the input shaping technique is presented in this paper for suppressing the residual vibration in these parallel robots. After addressing the design principle of an input shaper for a parallel robot with flexible actuated joints, a robust optimal input shaper is developed by considering the configuration-dependent flexible modes and minimizing the maximum percentage of residual vibration at the end-effector. The input shaper allows a good overall performance to be achieved throughout the entire workspace. Experimental results on a 4-DOF SCARA-type parallel robot show that the residual vibration of the end-effector is dramatically reduced and the dynamic positioning accuracy of the robot significantly improved.
2022, 35: 18.
doi: 10.1186/s10033-022-00684-6
Abstract:
An automatic markerless knee tracking and registration algorithm has been proposed in the literature to avoid the marker insertion required by conventional computer-assisted knee surgery, resulting in a shorter and less invasive surgical workflow. However, such an algorithm considers intact femur geometry only. The bone surface modification is inevitable due to intra-operative intervention. The mismatched correspondences will degrade the reliability of registered target pose. To solve this problem, this work proposed a supervised deep neural network to automatically restore the surface of processed bone. The network was trained on a synthetic dataset that consists of real depth captures of a model leg and simulated realistic femur cutting. According to the evaluation on both synthetic data and real-time captures, the registration quality can be effectively improved by surface reconstruction. The improvement in tracking accuracy is only evident over test data, indicating the need for future enhancement of the dataset and network.
An automatic markerless knee tracking and registration algorithm has been proposed in the literature to avoid the marker insertion required by conventional computer-assisted knee surgery, resulting in a shorter and less invasive surgical workflow. However, such an algorithm considers intact femur geometry only. The bone surface modification is inevitable due to intra-operative intervention. The mismatched correspondences will degrade the reliability of registered target pose. To solve this problem, this work proposed a supervised deep neural network to automatically restore the surface of processed bone. The network was trained on a synthetic dataset that consists of real depth captures of a model leg and simulated realistic femur cutting. According to the evaluation on both synthetic data and real-time captures, the registration quality can be effectively improved by surface reconstruction. The improvement in tracking accuracy is only evident over test data, indicating the need for future enhancement of the dataset and network.
2022, 35: 24.
doi: 10.1186/s10033-022-00701-8
Abstract:
Soft robots have become important members of the robot community with many potential applications owing to their unique flexibility and security embedded at the material level. An increasing number of researchers are interested in their designing, manufacturing, modeling, and control. However, the dynamic simulation of soft robots is difficult owing to their infinite degrees of freedom and nonlinear characteristics that are associated with soft materials and flexible geometric structures. In this study, a novel multi-flexible body dynamic modeling and simulation technique is introduced for soft robots. Various actuators for soft robots are modeled in a virtual environment, including soft cable-driven, spring actuation, and pneumatic driving. A pneumatic driving simulation was demonstrated by the bending modules with different materials. A cable-driven soft robot arm prototype and a cylindrical soft module actuated by shape memory alley springs inspired by an octopus were manufactured and used to validate the simulation model, and the experimental results demonstrated adequate accuracy. The proposed technique can be widely applied for the modeling and dynamic simulation of other soft robots, including hybrid actuated robots and rigid-flexible coupling robots. This study also provides a fundamental framework for simulating soft mobile robots and soft manipulators in contact with the environment.
Soft robots have become important members of the robot community with many potential applications owing to their unique flexibility and security embedded at the material level. An increasing number of researchers are interested in their designing, manufacturing, modeling, and control. However, the dynamic simulation of soft robots is difficult owing to their infinite degrees of freedom and nonlinear characteristics that are associated with soft materials and flexible geometric structures. In this study, a novel multi-flexible body dynamic modeling and simulation technique is introduced for soft robots. Various actuators for soft robots are modeled in a virtual environment, including soft cable-driven, spring actuation, and pneumatic driving. A pneumatic driving simulation was demonstrated by the bending modules with different materials. A cable-driven soft robot arm prototype and a cylindrical soft module actuated by shape memory alley springs inspired by an octopus were manufactured and used to validate the simulation model, and the experimental results demonstrated adequate accuracy. The proposed technique can be widely applied for the modeling and dynamic simulation of other soft robots, including hybrid actuated robots and rigid-flexible coupling robots. This study also provides a fundamental framework for simulating soft mobile robots and soft manipulators in contact with the environment.
2022, 35: 26.
doi: 10.1186/s10033-022-00695-3
Abstract:
The current research of nuclear control rod drive mechanism (CRDM) movable latch only makes a simple measurement of wear mass. The wear volume and difference in various claw surfaces are ignored and the degradation mechanism of each claw surface is not clear. In this paper, a detailed degradation analysis was carried out on each claw surface of movable latch combined with wear result and worn morphology. Results indicate that the boundary of carbide is preferred for corrosion because carbide presents a nobler Volta potential compared to the metal matrix or boundary region. Due to the oscillation of drive shaft between the claw surfaces of movable latch, the dominant wear mechanism on the upper surface of claw (USC) and lower surface of claw (LSC) is plastic deformation caused by impact wear. Mechanical impact wear will cause the fragmentation of carbides because of the high hardness and low ductility of carbides. Corrosion promotes the broken carbides to fall off from the metal matrix. The generated fine carbides (abrasive particles) cause extra abrasive wear on USC when the movable brings the drive shaft upward or downward. As a result, USC has a higher wear volume than LSC. This research proposes a method to evaluate the wear on the whole movable latches using a 3D full-size scanner.
The current research of nuclear control rod drive mechanism (CRDM) movable latch only makes a simple measurement of wear mass. The wear volume and difference in various claw surfaces are ignored and the degradation mechanism of each claw surface is not clear. In this paper, a detailed degradation analysis was carried out on each claw surface of movable latch combined with wear result and worn morphology. Results indicate that the boundary of carbide is preferred for corrosion because carbide presents a nobler Volta potential compared to the metal matrix or boundary region. Due to the oscillation of drive shaft between the claw surfaces of movable latch, the dominant wear mechanism on the upper surface of claw (USC) and lower surface of claw (LSC) is plastic deformation caused by impact wear. Mechanical impact wear will cause the fragmentation of carbides because of the high hardness and low ductility of carbides. Corrosion promotes the broken carbides to fall off from the metal matrix. The generated fine carbides (abrasive particles) cause extra abrasive wear on USC when the movable brings the drive shaft upward or downward. As a result, USC has a higher wear volume than LSC. This research proposes a method to evaluate the wear on the whole movable latches using a 3D full-size scanner.
2022, 35: 27.
doi: 10.1186/s10033-022-00703-6
Abstract:
Recirculation is expected to be identified for its possibility to dramatically decrease the efficiency of planetary gear trains (PGTs). However, it exhibits an unexplained connection with the structure, making it challenging to identify without tedious computation through tooth and speed ratios, thus complicating the design process. This study employs a generic model utilizing the mechanical balance principle and reveals the fundamental laws of the previously unexplained connection for parallel-connected ring-sun-type PGTs. Two necessary and sufficient conditions, torque and structure, were proven for multi-stage and two-stage PGTs without recirculation, respectively. This shows that the structure, specifically whether the links are central gears or carriers, and the connections between them directly impact the recirculation of these PGTs. A geometric model representing the structure and kinematics was developed to visualize the power flow. Thus, the recirculation of parallel-connected ring-sun-type PGTs can be predicted without calculations. Our results provide the underlying insights to understanding recirculation from the structural connection viewpoint, thereby contributing to the conceptual design phase where the task is to select the kinematic structure and the gear size is unknown.
Recirculation is expected to be identified for its possibility to dramatically decrease the efficiency of planetary gear trains (PGTs). However, it exhibits an unexplained connection with the structure, making it challenging to identify without tedious computation through tooth and speed ratios, thus complicating the design process. This study employs a generic model utilizing the mechanical balance principle and reveals the fundamental laws of the previously unexplained connection for parallel-connected ring-sun-type PGTs. Two necessary and sufficient conditions, torque and structure, were proven for multi-stage and two-stage PGTs without recirculation, respectively. This shows that the structure, specifically whether the links are central gears or carriers, and the connections between them directly impact the recirculation of these PGTs. A geometric model representing the structure and kinematics was developed to visualize the power flow. Thus, the recirculation of parallel-connected ring-sun-type PGTs can be predicted without calculations. Our results provide the underlying insights to understanding recirculation from the structural connection viewpoint, thereby contributing to the conceptual design phase where the task is to select the kinematic structure and the gear size is unknown.
2022, 35: 29.
doi: 10.1186/s10033-022-00702-7
Abstract:
Current research on spherical parallel mechanisms (SPMs) mainly focus on surgical robots, exoskeleton robots, entertainment equipment, and other fields. However, compared with the SPM, the structure types and research contents of the SPM are not abundant enough. In this paper, a novel two-degree-of-freedom (2DOF) SPM with symmetrical structure is proposed and analyzed. First, the models of forward kinematics and inverse kinematics are established based on D-H parameters, and the Jacobian matrix of the mechanism is obtained and verified. Second, the workspace of the mechanism is obtained according to inverse kinematics and link interference conditions. Next, rotational characteristics analysis shows that the end effector can achieve continuous rotation about an axis located in the mid-plane and passing through the rotation center of the mechanism. Moreover, the rotational characteristics of the mechanism are proved, and motion planning is carried out. A numerical example is given to verify the kinematics analysis and motion planning. Finally, some variant mechanisms can be synthesized. This work lays the foundation for the motion control and practical application of this 2DOF SPM.
Current research on spherical parallel mechanisms (SPMs) mainly focus on surgical robots, exoskeleton robots, entertainment equipment, and other fields. However, compared with the SPM, the structure types and research contents of the SPM are not abundant enough. In this paper, a novel two-degree-of-freedom (2DOF) SPM with symmetrical structure is proposed and analyzed. First, the models of forward kinematics and inverse kinematics are established based on D-H parameters, and the Jacobian matrix of the mechanism is obtained and verified. Second, the workspace of the mechanism is obtained according to inverse kinematics and link interference conditions. Next, rotational characteristics analysis shows that the end effector can achieve continuous rotation about an axis located in the mid-plane and passing through the rotation center of the mechanism. Moreover, the rotational characteristics of the mechanism are proved, and motion planning is carried out. A numerical example is given to verify the kinematics analysis and motion planning. Finally, some variant mechanisms can be synthesized. This work lays the foundation for the motion control and practical application of this 2DOF SPM.
2022, 35: 31.
doi: 10.1186/s10033-022-00699-z
Abstract:
Robotic splicing of steel arches is a challenging task that is necessary to realize the grasping and docking of steel arches in a limited space. Steel arches often have a mass of more than 200 kg and length of more than 4 m. Owing to the large volume and mass of steel arches and the high requirements for accurately positioning the splicing, it is difficult for a general manipulator to meet the stiffness requirements. To enhance the structural stiffness of the steel arch splicing manipulator, a single-degree-of-freedom (DOF) closed-loop mechanism was added to the grasping structure of the manipulator. Based on the basic principle of structural synthesis, a solution model of the single-DOF closed-loop mechanism was developed, and alternative kinematic pairs of the mechanism with different input constraints and output requirements were derived. Based on this model, a design method for a single-DOF closed-loop grasping mechanism and a posture adjustment mechanism for a steel arch was devised. Combined with the same dimensional subspace equivalence principle of the graphical-type synthesis method, 12 types of steel arch splicing manipulator were constructed. By analyzing the motion/force transmission and structural complexity of the steel arch splicing manipulators, the best scheme was selected. A prototype of the steel arch splicing manipulator was manufactured. Adams software was used to obtain clearly the output trajectory of the end of the manipulator. The relative spatial positions of the upper and lower jaws under different working stages were analyzed, demonstrating that the manipulator satisfied the grasping requirements. Through a steel arch splicing experiment, the grasping effect, docking accuracy, and splicing efficiency of the manipulator met the design requirements. The steel arch splicing manipulator can replace the manual completion of the steel arch splicing operation, significantly improving the operation efficiency.
Robotic splicing of steel arches is a challenging task that is necessary to realize the grasping and docking of steel arches in a limited space. Steel arches often have a mass of more than 200 kg and length of more than 4 m. Owing to the large volume and mass of steel arches and the high requirements for accurately positioning the splicing, it is difficult for a general manipulator to meet the stiffness requirements. To enhance the structural stiffness of the steel arch splicing manipulator, a single-degree-of-freedom (DOF) closed-loop mechanism was added to the grasping structure of the manipulator. Based on the basic principle of structural synthesis, a solution model of the single-DOF closed-loop mechanism was developed, and alternative kinematic pairs of the mechanism with different input constraints and output requirements were derived. Based on this model, a design method for a single-DOF closed-loop grasping mechanism and a posture adjustment mechanism for a steel arch was devised. Combined with the same dimensional subspace equivalence principle of the graphical-type synthesis method, 12 types of steel arch splicing manipulator were constructed. By analyzing the motion/force transmission and structural complexity of the steel arch splicing manipulators, the best scheme was selected. A prototype of the steel arch splicing manipulator was manufactured. Adams software was used to obtain clearly the output trajectory of the end of the manipulator. The relative spatial positions of the upper and lower jaws under different working stages were analyzed, demonstrating that the manipulator satisfied the grasping requirements. Through a steel arch splicing experiment, the grasping effect, docking accuracy, and splicing efficiency of the manipulator met the design requirements. The steel arch splicing manipulator can replace the manual completion of the steel arch splicing operation, significantly improving the operation efficiency.
2022, 35: 32.
doi: 10.1186/s10033-022-00700-9
Abstract:
Large quadruped mammals, such as ruminants, have outstanding motion ability, including running and bounding. These advanced motion abilities are related to the buffer effect of their complicated musculoskeletal systems. However, the buffer effect of most bio-robots is not satisfactory owing to the simple design of their buffer systems. In this paper, a physiological analysis of the ruminant musculoskeletal system is presented to explain the intrinsic buffer mechanism of motion. Based on the physical buffer parts of the ruminant limbs, the corresponding bionic mappings were determined. These mappings were used to guide the mechanism design of the robot multistage buffer system. The multistage buffer system includes two main buffer mechanisms: the first stage and the second stage. The buffer mechanism analysis of the first stage and multiple stages is discussed in theory to compare the effects between the normal single buffer system and the novel multistage buffer system. Then, the detailed mechanical structure of the limbs was designed based on the limb mechanism design. To further verify the superior efficacy of the multistage buffer system, the corresponding walking simulation experiments were conducted after the virtual prototype of a quadruped robot with a novel limb was built completely. Both theoretical analysis and simulation experiments prove that the bionic robot design with the novel multistage buffer system achieves better motion performance than the traditional robot buffer design and can be regarded as the design template of the robot limb.
Large quadruped mammals, such as ruminants, have outstanding motion ability, including running and bounding. These advanced motion abilities are related to the buffer effect of their complicated musculoskeletal systems. However, the buffer effect of most bio-robots is not satisfactory owing to the simple design of their buffer systems. In this paper, a physiological analysis of the ruminant musculoskeletal system is presented to explain the intrinsic buffer mechanism of motion. Based on the physical buffer parts of the ruminant limbs, the corresponding bionic mappings were determined. These mappings were used to guide the mechanism design of the robot multistage buffer system. The multistage buffer system includes two main buffer mechanisms: the first stage and the second stage. The buffer mechanism analysis of the first stage and multiple stages is discussed in theory to compare the effects between the normal single buffer system and the novel multistage buffer system. Then, the detailed mechanical structure of the limbs was designed based on the limb mechanism design. To further verify the superior efficacy of the multistage buffer system, the corresponding walking simulation experiments were conducted after the virtual prototype of a quadruped robot with a novel limb was built completely. Both theoretical analysis and simulation experiments prove that the bionic robot design with the novel multistage buffer system achieves better motion performance than the traditional robot buffer design and can be regarded as the design template of the robot limb.
2022, 35: 33.
doi: 10.1186/s10033-022-00693-5
Abstract:
In order to improve the low output accuracy caused by the elastic deformations of the branch chains, a finite element-based dynamic accuracy analysis method for parallel mechanisms is proposed in this paper. First, taking a 5-prismatic-spherical-spherical (PSS)/universal-prismatic-universal (UPU) parallel mechanism as an example, the error model is established by a closed vector chain method, while its influence on the dynamic accuracy of the parallel mechanism is analyzed through numerical simulation. According to the structural and error characteristics of the parallel mechanism, a vector calibration algorithm is proposed to reduce the position and pose errors along the whole motion trajectory. Then, considering the elastic deformation of the rod, the rigid-flexible coupling dynamic equations of each component are established by combining the finite element method with the Lagrange method. The elastodynamic model of the whole machine is obtained based on the constraint condition of each moving part, and the correctness of the model is verified by simulation. Moreover, the effect of component flexibility on the dimensionless root mean square error of the displacement, velocity and acceleration of the moving platform is investigated by using a Newmark method, and the mapping relationship of these dimensionless root mean square errors to dynamic accuracy is further studied. The research work provides a theoretical basis for the design of the parameter size of the prototype.
In order to improve the low output accuracy caused by the elastic deformations of the branch chains, a finite element-based dynamic accuracy analysis method for parallel mechanisms is proposed in this paper. First, taking a 5-prismatic-spherical-spherical (PSS)/universal-prismatic-universal (UPU) parallel mechanism as an example, the error model is established by a closed vector chain method, while its influence on the dynamic accuracy of the parallel mechanism is analyzed through numerical simulation. According to the structural and error characteristics of the parallel mechanism, a vector calibration algorithm is proposed to reduce the position and pose errors along the whole motion trajectory. Then, considering the elastic deformation of the rod, the rigid-flexible coupling dynamic equations of each component are established by combining the finite element method with the Lagrange method. The elastodynamic model of the whole machine is obtained based on the constraint condition of each moving part, and the correctness of the model is verified by simulation. Moreover, the effect of component flexibility on the dimensionless root mean square error of the displacement, velocity and acceleration of the moving platform is investigated by using a Newmark method, and the mapping relationship of these dimensionless root mean square errors to dynamic accuracy is further studied. The research work provides a theoretical basis for the design of the parameter size of the prototype.
2022, 35: 34.
doi: 10.1186/s10033-022-00688-2
Abstract:
This paper presents the kinematic calibration of a novel six-legged walking machine tool comprising a six-legged mobile robot integrated with a parallel manipulator on the body. Each leg of the robot is a 2-universal-prismatic-spherical (UPS) and UP parallel mechanism, and the manipulator is a 6-PSU parallel mechanism. The error models of both subsystems are derived according to their inverse kinematics. The objective function for each kinematic limb is formulated as the inverse kinematic residual, i.e., the deviation between the actual and computed joint coordinates. The hip center of each leg is first identified via sphere fitting, and the other kinematic parameters are identified by solving the objective function for each limb individually using the least-squares method. Thus, the kinematic parameters are partially decoupled, and the complexities of the error models are reduced. A calibration method is proposed for the legged robot to overcome the lack of a fixed base on the ground. A calibration experiment is conducted to validate the proposed method, where a laser tracker is used as the measurement equipment. The kinematic parameters of the entire robot are identified, and the motion accuracy of each leg and that of the manipulator are significantly improved after calibration. Validation experiments are performed to evaluate the positioning and trajectory errors of the six-legged walking machine tool. The results indicate that the kinematic calibration of the legs and manipulator improves not only the motion accuracy of each individual subsystem but also the cooperative motion accuracy among the subsystems.
This paper presents the kinematic calibration of a novel six-legged walking machine tool comprising a six-legged mobile robot integrated with a parallel manipulator on the body. Each leg of the robot is a 2-universal-prismatic-spherical (UPS) and UP parallel mechanism, and the manipulator is a 6-PSU parallel mechanism. The error models of both subsystems are derived according to their inverse kinematics. The objective function for each kinematic limb is formulated as the inverse kinematic residual, i.e., the deviation between the actual and computed joint coordinates. The hip center of each leg is first identified via sphere fitting, and the other kinematic parameters are identified by solving the objective function for each limb individually using the least-squares method. Thus, the kinematic parameters are partially decoupled, and the complexities of the error models are reduced. A calibration method is proposed for the legged robot to overcome the lack of a fixed base on the ground. A calibration experiment is conducted to validate the proposed method, where a laser tracker is used as the measurement equipment. The kinematic parameters of the entire robot are identified, and the motion accuracy of each leg and that of the manipulator are significantly improved after calibration. Validation experiments are performed to evaluate the positioning and trajectory errors of the six-legged walking machine tool. The results indicate that the kinematic calibration of the legs and manipulator improves not only the motion accuracy of each individual subsystem but also the cooperative motion accuracy among the subsystems.
2022, 35: 53.
doi: 10.1186/s10033-022-00723-2
Abstract:
The length of flexible manipulators with a telescopic arm alters during movement. The dynamic parameters of telescopic flexible manipulators exhibit significant time-varying characteristics owing to variations in length. With an increase in the manipulators' length, the nonlinear terms caused by flexibility in the manipulators' dynamic equations cannot be ignored. The time-varying characteristics and nonlinear terms of telescopic flexible manipulators cause fluctuations in rotation angles, which affect the operation accuracy of end-effectors. In this study, a control strategy based on a combination of fuzzy adjustment and an RBF neural network is utilized to improve the control accuracy of flexible telescopic manipulators. First, the dynamic equation of the manipulators is established using the assumed mode method and Lagrange's principle, and the influence of nonlinear terms is analyzed. Subsequently, a combined control strategy is proposed to suppress the fluctuation of the rotation angle in telescopic flexible manipulators. The variation ranges of the feedforward PD controller parameters are determined by the pole placement strategy and length of the manipulators. Fuzzy rules are utilized to adjust the controller parameters in real-time. The RBF neural network is utilized to identify and compensate the uncertain part of the dynamic model of the flexible manipulators. The uncertain part comprises time-varying parameters and nonlinear terms. Finally, numerical simulations and prototype experiments prove the effectiveness of the combined control strategy. The results prove that the proposed control strategy has a smaller standard deviation of errors. Therefore, the combined control strategy is more suitable for telescopic flexible manipulators, which can effectively improve the control accuracy of rotation angles.
The length of flexible manipulators with a telescopic arm alters during movement. The dynamic parameters of telescopic flexible manipulators exhibit significant time-varying characteristics owing to variations in length. With an increase in the manipulators' length, the nonlinear terms caused by flexibility in the manipulators' dynamic equations cannot be ignored. The time-varying characteristics and nonlinear terms of telescopic flexible manipulators cause fluctuations in rotation angles, which affect the operation accuracy of end-effectors. In this study, a control strategy based on a combination of fuzzy adjustment and an RBF neural network is utilized to improve the control accuracy of flexible telescopic manipulators. First, the dynamic equation of the manipulators is established using the assumed mode method and Lagrange's principle, and the influence of nonlinear terms is analyzed. Subsequently, a combined control strategy is proposed to suppress the fluctuation of the rotation angle in telescopic flexible manipulators. The variation ranges of the feedforward PD controller parameters are determined by the pole placement strategy and length of the manipulators. Fuzzy rules are utilized to adjust the controller parameters in real-time. The RBF neural network is utilized to identify and compensate the uncertain part of the dynamic model of the flexible manipulators. The uncertain part comprises time-varying parameters and nonlinear terms. Finally, numerical simulations and prototype experiments prove the effectiveness of the combined control strategy. The results prove that the proposed control strategy has a smaller standard deviation of errors. Therefore, the combined control strategy is more suitable for telescopic flexible manipulators, which can effectively improve the control accuracy of rotation angles.
A Robotic System with Robust Remote Center of Motion Constraint for Endometrial Regeneration Surgery
2022, 35: 76.
doi: 10.1186/s10033-022-00731-2
Abstract:
Surgical robots have been widely used in different procedures to improve and facilitate the surgery. However, there is no robot designed for endometrial regeneration surgery, which is a new therapy for restoring fertility in women using stem cells. Endometrial regeneration surgery requires processing of the endometrium and transplantation of stem cells with minimal trauma to the uterus. In this paper, we introduce a surgical robotic system that consists of a dexterous hysteroscope, supporting arm, and additional novel instruments to facilitate the operation and decrease trauma to the uterus. Remote center of motion (RCM) constraint is required to protect the cervix of the uterus. First, the supporting arm and hysteroscope are controlled separately in kinematics to ensure that the RCM constraint and hysteroscope's shape and posture are predictable. Then, a task-decoupled method is used to improve the robustness of the RCM constraint. Experiments confirm that the proposed method is more robust and achieves higher RCM accuracy. In addition, the master-slave control of a robot with RCM constraint is also verified. This study proposes the realization of a robot with robust RCM control for endometrial regeneration surgery.
Surgical robots have been widely used in different procedures to improve and facilitate the surgery. However, there is no robot designed for endometrial regeneration surgery, which is a new therapy for restoring fertility in women using stem cells. Endometrial regeneration surgery requires processing of the endometrium and transplantation of stem cells with minimal trauma to the uterus. In this paper, we introduce a surgical robotic system that consists of a dexterous hysteroscope, supporting arm, and additional novel instruments to facilitate the operation and decrease trauma to the uterus. Remote center of motion (RCM) constraint is required to protect the cervix of the uterus. First, the supporting arm and hysteroscope are controlled separately in kinematics to ensure that the RCM constraint and hysteroscope's shape and posture are predictable. Then, a task-decoupled method is used to improve the robustness of the RCM constraint. Experiments confirm that the proposed method is more robust and achieves higher RCM accuracy. In addition, the master-slave control of a robot with RCM constraint is also verified. This study proposes the realization of a robot with robust RCM control for endometrial regeneration surgery.
2022, 35: 78.
doi: 10.1186/s10033-022-00747-8
Abstract:
The parasitic motion has been widely recognized as the major drawback of the parallel mechanism. Therefore a class of 2R1T PMs (parallel mechanism) without parasitic motion has been synthesized. However, these PMs can only rotate around two axes in sequential order. It decreases the performance of the balancing adjustment of the end-effector. In this paper, a family of 2R1T PMs without parasitic motion was reconstructed by using a novel method based on the remarkable properties of rotational bifurcation mechanisms, which can rotate in sequential order. Furthermore, some PMs rotating around two continuous axes in an arbitrary order are established by adding single joints. Taking the practicability of these structures into consideration, the workspace of 3-PRPS PM was analyzed as an example. Moreover, this study explores the practical application of the PMs without parasitic motion in developing balance mechanisms in rough-terrain fire-fighting robots. During the climbing process, the tank is adjusted to be parallel to the horizontal plane in real-time. It is proved that this kind of structure realizes continuous rotation around two rotation axes on the premise of no parasitic motion.
The parasitic motion has been widely recognized as the major drawback of the parallel mechanism. Therefore a class of 2R1T PMs (parallel mechanism) without parasitic motion has been synthesized. However, these PMs can only rotate around two axes in sequential order. It decreases the performance of the balancing adjustment of the end-effector. In this paper, a family of 2R1T PMs without parasitic motion was reconstructed by using a novel method based on the remarkable properties of rotational bifurcation mechanisms, which can rotate in sequential order. Furthermore, some PMs rotating around two continuous axes in an arbitrary order are established by adding single joints. Taking the practicability of these structures into consideration, the workspace of 3-PRPS PM was analyzed as an example. Moreover, this study explores the practical application of the PMs without parasitic motion in developing balance mechanisms in rough-terrain fire-fighting robots. During the climbing process, the tank is adjusted to be parallel to the horizontal plane in real-time. It is proved that this kind of structure realizes continuous rotation around two rotation axes on the premise of no parasitic motion.
2022, 35: 83.
doi: 10.1186/s10033-022-00749-6
Abstract:
Dyskinesia of the upper limbs caused by stroke, sports injury, or traffic accidents limits the ability to perform the activities of daily living. Besides the necessary medical treatment, correct and scientific rehabilitation training for the injured joint is an important auxiliary means during the treatment of the effected upper limb. Conventional upper-limb rehabilitation robots have some disadvantages, such as a complex structure, poor compliance, high cost, and poor portability. In this study, a novel soft wearable upper limb rehabilitation robot (SWULRR) with reinforced soft pneumatic actuators (RSPAs) that can withstand high pressure and featuring excellent loading characteristics was developed. Driven by RSPAs, this portable SWULRR can perform rehabilitation training of the wrist and elbow joints. In this study, the kinematics of an SWULRR were analyzed, and the force and motion characteristics of RSPA were studied experimentally. The results provide a reference for the development and application of wearable upper limb rehabilitation robots. An experimental study on the rotation angle of the wrist and the pressure of the RSPA was conducted to test the effect of the rehabilitation training and verify the rationality of the theoretical model. The process of wrist rehabilitation training was tested and evaluated, indicating that SWULRR with RSPAs will enhance the flexibility, comfort, and safety of rehabilitation training. This work is expected to promote the development of wearable upper-limb rehabilitation robots based on modular reinforced soft pneumatic actuators.
Dyskinesia of the upper limbs caused by stroke, sports injury, or traffic accidents limits the ability to perform the activities of daily living. Besides the necessary medical treatment, correct and scientific rehabilitation training for the injured joint is an important auxiliary means during the treatment of the effected upper limb. Conventional upper-limb rehabilitation robots have some disadvantages, such as a complex structure, poor compliance, high cost, and poor portability. In this study, a novel soft wearable upper limb rehabilitation robot (SWULRR) with reinforced soft pneumatic actuators (RSPAs) that can withstand high pressure and featuring excellent loading characteristics was developed. Driven by RSPAs, this portable SWULRR can perform rehabilitation training of the wrist and elbow joints. In this study, the kinematics of an SWULRR were analyzed, and the force and motion characteristics of RSPA were studied experimentally. The results provide a reference for the development and application of wearable upper limb rehabilitation robots. An experimental study on the rotation angle of the wrist and the pressure of the RSPA was conducted to test the effect of the rehabilitation training and verify the rationality of the theoretical model. The process of wrist rehabilitation training was tested and evaluated, indicating that SWULRR with RSPAs will enhance the flexibility, comfort, and safety of rehabilitation training. This work is expected to promote the development of wearable upper-limb rehabilitation robots based on modular reinforced soft pneumatic actuators.
2022, 35: 87.
doi: 10.1186/s10033-022-00765-6
Abstract:
The recirculating planetary roller screw mechanism (RPRSM) is a transmission mechanism that engages the screw and nut threaded by multiple grooved rollers. In this paper, firstly, the design method of RPRSM nut threadless area is proposed, and the equations related to the structural parameters of nut threadless area are derived. On this basis, the cross-section design method of roller, screw and nut is constructed according to the actual situation of engagements between the screw/nut and the roller. By adjusting the gap between the two beveled edges and that between the arc and the beveled edge, the accuracy of the thread engagements between the screw/nut and the roller can be improved. Secondly, to ensure the engagements of the screw/nut and the roller, the distance equation from the center surface of the different rollers to the end surface of cam ring is given. Thirdly, combined with the working principle and structural composition of RPRSM, the component model is established according to its relevant structural parameters, and the virtual assembly is completed. Finally, the 3D model is imported into the ADAMS simulation software for multi-rigid body dynamics. The dynamic characteristic is analyzed, and the simulated values are compared with the theoretical values. The results show that the contact forces between the screw/nut and the roller are sinusoidal, mainly due to the existence of a small gap between the roller and the carrier. The maximum collision forces between the roller and cam ring are independent from load magnitude. Normally, the collision force between the roller and the carrier increases as the load increases. When RPRSM is in the transmission process, the roller angular speed in nut threadless area begins to appear abruptly, and the position of the maximum change is at the contact between the roller and the convex platform of cam ring. The design of the nut threadless area and the proposed virtual assembly method can provide a theoretical guidance for RPRSM research, as well as a reference for overall performance optimization.
The recirculating planetary roller screw mechanism (RPRSM) is a transmission mechanism that engages the screw and nut threaded by multiple grooved rollers. In this paper, firstly, the design method of RPRSM nut threadless area is proposed, and the equations related to the structural parameters of nut threadless area are derived. On this basis, the cross-section design method of roller, screw and nut is constructed according to the actual situation of engagements between the screw/nut and the roller. By adjusting the gap between the two beveled edges and that between the arc and the beveled edge, the accuracy of the thread engagements between the screw/nut and the roller can be improved. Secondly, to ensure the engagements of the screw/nut and the roller, the distance equation from the center surface of the different rollers to the end surface of cam ring is given. Thirdly, combined with the working principle and structural composition of RPRSM, the component model is established according to its relevant structural parameters, and the virtual assembly is completed. Finally, the 3D model is imported into the ADAMS simulation software for multi-rigid body dynamics. The dynamic characteristic is analyzed, and the simulated values are compared with the theoretical values. The results show that the contact forces between the screw/nut and the roller are sinusoidal, mainly due to the existence of a small gap between the roller and the carrier. The maximum collision forces between the roller and cam ring are independent from load magnitude. Normally, the collision force between the roller and the carrier increases as the load increases. When RPRSM is in the transmission process, the roller angular speed in nut threadless area begins to appear abruptly, and the position of the maximum change is at the contact between the roller and the convex platform of cam ring. The design of the nut threadless area and the proposed virtual assembly method can provide a theoretical guidance for RPRSM research, as well as a reference for overall performance optimization.
2022, 35: 95.
doi: 10.1186/s10033-022-00761-w
Abstract:
Dynamic movement primitives (DMPs) as a robust and efficient framework has been studied widely for robot learning from demonstration. Classical DMPs framework mainly focuses on the movement learning in Cartesian or joint space, and can't properly represent end-effector orientation. In this paper, we present an extended DMPs framework (EDMPs) both in Cartesian space and 2-Dimensional (2D) sphere manifold for Quaternion-based orientation learning and generalization. Gaussian mixture model and Gaussian mixture regression (GMM-GMR) are adopted as the initialization phase of EDMPs to handle multi-demonstrations and obtain their mean and covariance. Additionally, some evaluation indicators including reachability and similarity are defined to characterize the learning and generalization abilities of EDMPs. Finally, a real-world experiment was conducted with human demonstrations, the endpoint poses of human arm were recorded and successfully transferred from human to the robot. The experimental results show that the absolute errors of the Cartesian and Riemannian space skills are less than 3.5 mm and 1.0°, respectively. The Pearson's correlation coefficients of the Cartesian and Riemannian space skills are mostly greater than 0.9. The developed EDMPs exhibits superior reachability and similarity for the multi-space skills' learning and generalization. This research proposes a fused framework with EDMPs and GMM-GMR which has sufficient capability to handle the multi-space skills in multi-demonstrations.
Dynamic movement primitives (DMPs) as a robust and efficient framework has been studied widely for robot learning from demonstration. Classical DMPs framework mainly focuses on the movement learning in Cartesian or joint space, and can't properly represent end-effector orientation. In this paper, we present an extended DMPs framework (EDMPs) both in Cartesian space and 2-Dimensional (2D) sphere manifold for Quaternion-based orientation learning and generalization. Gaussian mixture model and Gaussian mixture regression (GMM-GMR) are adopted as the initialization phase of EDMPs to handle multi-demonstrations and obtain their mean and covariance. Additionally, some evaluation indicators including reachability and similarity are defined to characterize the learning and generalization abilities of EDMPs. Finally, a real-world experiment was conducted with human demonstrations, the endpoint poses of human arm were recorded and successfully transferred from human to the robot. The experimental results show that the absolute errors of the Cartesian and Riemannian space skills are less than 3.5 mm and 1.0°, respectively. The Pearson's correlation coefficients of the Cartesian and Riemannian space skills are mostly greater than 0.9. The developed EDMPs exhibits superior reachability and similarity for the multi-space skills' learning and generalization. This research proposes a fused framework with EDMPs and GMM-GMR which has sufficient capability to handle the multi-space skills in multi-demonstrations.
2022, 35: 109.
doi: 10.1186/s10033-022-00775-4
Abstract:
Positioning and navigation technology is a new trend of research in mobile robot area. Existing researches focus on the indoor industrial problems, while many application fields are in the outdoor environment, which put forward higher requirements for sensor selection and navigation scheme. In this paper, a complete hybrid navigation system for a class of mobile robots with load tasks and docking tasks is presented. The work can realize large-range autonomous positioning and path planning for mobile robots in unstructured scenarios. The autonomous positioning is achieved by adopting suitable guidance methods to meet different application requirements and accuracy requirements in conditions of different distances. Based on the Bezier curve, a path planning scheme is proposed and a motion controller is designed to make the mobile robot follow the target path. The Kalman filter is established to process the guidance signals and control outputs of the motion controller. Finally, the autonomous positioning and docking experiment are carried out. The results of the research verify the effectiveness of the hybrid navigation, which can be used in autonomous warehousing logistics and multi-mobile robot system.
Positioning and navigation technology is a new trend of research in mobile robot area. Existing researches focus on the indoor industrial problems, while many application fields are in the outdoor environment, which put forward higher requirements for sensor selection and navigation scheme. In this paper, a complete hybrid navigation system for a class of mobile robots with load tasks and docking tasks is presented. The work can realize large-range autonomous positioning and path planning for mobile robots in unstructured scenarios. The autonomous positioning is achieved by adopting suitable guidance methods to meet different application requirements and accuracy requirements in conditions of different distances. Based on the Bezier curve, a path planning scheme is proposed and a motion controller is designed to make the mobile robot follow the target path. The Kalman filter is established to process the guidance signals and control outputs of the motion controller. Finally, the autonomous positioning and docking experiment are carried out. The results of the research verify the effectiveness of the hybrid navigation, which can be used in autonomous warehousing logistics and multi-mobile robot system.
2022, 35: 113.
doi: 10.1186/s10033-022-00793-2
Abstract:
The kinematic redundancy is considered as a way to improve the performance of the parallel mechanism. In this paper, the kinematics performance of a three degree-of-freedom parallel mechanism with kinematic redundancy (3-DOF PM-KR) and the influence of redundant parts on the PM-KR are analyzed. Firstly, the kinematics model of the PM-KR is established. The inverse solutions, the Jacobian matrix, and the workspace of the PM-KR are solved. Secondly, the influence of redundancy on the PM-KR is analyzed. Since there exists kinematic redundancy, the PM-KR possesses fault-tolerant performance. By locking one actuating joint or two actuating joints simultaneously, the fault-tolerant workspace is obtained. When the position of the redundant part is changed, the workspace and singularity will be changed. The results show that kinematic redundancy can be used to avoid singularity. Finally, the simulations are performed to prove the theoretical analysis.
The kinematic redundancy is considered as a way to improve the performance of the parallel mechanism. In this paper, the kinematics performance of a three degree-of-freedom parallel mechanism with kinematic redundancy (3-DOF PM-KR) and the influence of redundant parts on the PM-KR are analyzed. Firstly, the kinematics model of the PM-KR is established. The inverse solutions, the Jacobian matrix, and the workspace of the PM-KR are solved. Secondly, the influence of redundancy on the PM-KR is analyzed. Since there exists kinematic redundancy, the PM-KR possesses fault-tolerant performance. By locking one actuating joint or two actuating joints simultaneously, the fault-tolerant workspace is obtained. When the position of the redundant part is changed, the workspace and singularity will be changed. The results show that kinematic redundancy can be used to avoid singularity. Finally, the simulations are performed to prove the theoretical analysis.
2022, 35: 115.
doi: 10.1186/s10033-022-00778-1
Abstract:
Industrial robots are increasingly being used in machining tasks because of their high flexibility and intelligence. However, the low structural stiffness of a robot significantly affects its positional accuracy and the machining quality of its operation equipment. Studying robot stiffness characteristics and optimization methods is an effective method of improving the stiffness performance of a robot. Accordingly, aiming at the poor accuracy of stiffness modeling caused by approximating the stiffness of each joint as a constant, a variable stiffness identification method is proposed based on space gridding. Subsequently, a task-oriented axial stiffness evaluation index is proposed to quantitatively assess the stiffness performance in the machining direction. In addition, by analyzing the redundant kinematic characteristics of the robot machining system, a configuration optimization method is further developed to maximize the index. For numerous points or trajectory-processing tasks, a configuration smoothing strategy is proposed to rapidly acquire optimized configurations. Finally, experiments on a KR500 robot were conducted to verify the feasibility and validity of the proposed stiffness identification and configuration optimization methods.
Industrial robots are increasingly being used in machining tasks because of their high flexibility and intelligence. However, the low structural stiffness of a robot significantly affects its positional accuracy and the machining quality of its operation equipment. Studying robot stiffness characteristics and optimization methods is an effective method of improving the stiffness performance of a robot. Accordingly, aiming at the poor accuracy of stiffness modeling caused by approximating the stiffness of each joint as a constant, a variable stiffness identification method is proposed based on space gridding. Subsequently, a task-oriented axial stiffness evaluation index is proposed to quantitatively assess the stiffness performance in the machining direction. In addition, by analyzing the redundant kinematic characteristics of the robot machining system, a configuration optimization method is further developed to maximize the index. For numerous points or trajectory-processing tasks, a configuration smoothing strategy is proposed to rapidly acquire optimized configurations. Finally, experiments on a KR500 robot were conducted to verify the feasibility and validity of the proposed stiffness identification and configuration optimization methods.
2022, 35: 119.
doi: 10.1186/s10033-022-00781-6
Abstract:
For the development of a parallel mechanism (PM), it is necessary to establish a dynamic model which can accurately meet the requirements of real-time control. Compared with the general dynamic analysis model based on the inverse kinematics, the dynamic analysis model based on the forward kinematics has the advantage of low-complexity. In this paper, a new type of 3-DOF PM with analytical forward displacement analysis is proposed. Different from the general dynamic analysis based on the inverse kinematics, the displacement, velocity and acceleration equations of the PM are established and solved by forward kinematics. The inverse dynamic equation of the PM is constructed and solved by analyzing the forces on each link and based on Newton-Euler method. Then the theoretical results of an example are compared with the simulation results, which shows that the simulation results are basically consistent with the theoretical results. And the maximum error of the driving force of each pair is 1.32%, 5.8% and 5.2%, respectively, which verifies the correctness of the dynamic model. The PM has a potential application prospect in the grasping, spraying and picking of workpieces. The research results of this paper provide a theoretical basis for the design, manufacture and application of the PM.
For the development of a parallel mechanism (PM), it is necessary to establish a dynamic model which can accurately meet the requirements of real-time control. Compared with the general dynamic analysis model based on the inverse kinematics, the dynamic analysis model based on the forward kinematics has the advantage of low-complexity. In this paper, a new type of 3-DOF PM with analytical forward displacement analysis is proposed. Different from the general dynamic analysis based on the inverse kinematics, the displacement, velocity and acceleration equations of the PM are established and solved by forward kinematics. The inverse dynamic equation of the PM is constructed and solved by analyzing the forces on each link and based on Newton-Euler method. Then the theoretical results of an example are compared with the simulation results, which shows that the simulation results are basically consistent with the theoretical results. And the maximum error of the driving force of each pair is 1.32%, 5.8% and 5.2%, respectively, which verifies the correctness of the dynamic model. The PM has a potential application prospect in the grasping, spraying and picking of workpieces. The research results of this paper provide a theoretical basis for the design, manufacture and application of the PM.
2022, 35: 123.
doi: 10.1186/s10033-022-00792-3
Abstract:
In the present study, the over-constrained hybrid manipulator R(2RPR)R/SP+RR is considered as the research objective. In this paper, kinematics of the hybrid manipulator, including the forward and inverse position, are analyzed. Then, the workspace is checked based on the inverse position solution to evaluate whether the workspace of the hybrid manipulator meets the requirements, and the actual workspace of the hybrid robot is analyzed. After that, the force analysis of the over-constrained parallel mechanism is carried out, and an ADAMS-ANSYS rigid-flexible hybrid body model is established to verify the simulation. Based on the obtained results from the force analysis, the manipulator structure is designed. Then, the structure optimization is carried out to improve the robot stiffness. Finally, calibration and workspace verification experiments are performed on the prototype, cutting experiment of an S-shaped aluminum alloy workpiece is completed, and the experiment verifies the machining ability of the prototype. This work conducts kinematics, workspace, force analyses, structural optimization design and experiments on the over-constrained hybrid manipulator R(2RPR)R/SP+RR, providing design basis and technical support for the development of the novel hybrid manipulator in practical engineering.
In the present study, the over-constrained hybrid manipulator R(2RPR)R/SP+RR is considered as the research objective. In this paper, kinematics of the hybrid manipulator, including the forward and inverse position, are analyzed. Then, the workspace is checked based on the inverse position solution to evaluate whether the workspace of the hybrid manipulator meets the requirements, and the actual workspace of the hybrid robot is analyzed. After that, the force analysis of the over-constrained parallel mechanism is carried out, and an ADAMS-ANSYS rigid-flexible hybrid body model is established to verify the simulation. Based on the obtained results from the force analysis, the manipulator structure is designed. Then, the structure optimization is carried out to improve the robot stiffness. Finally, calibration and workspace verification experiments are performed on the prototype, cutting experiment of an S-shaped aluminum alloy workpiece is completed, and the experiment verifies the machining ability of the prototype. This work conducts kinematics, workspace, force analyses, structural optimization design and experiments on the over-constrained hybrid manipulator R(2RPR)R/SP+RR, providing design basis and technical support for the development of the novel hybrid manipulator in practical engineering.
2022, 35: 124.
doi: 10.1186/s10033-022-00777-2
Abstract:
A novel compliant mechanism with RPR degrees of freedom (DOF) is proposed where R and P represent rotation and translation DOFs, respectively. The proposed compliant mechanism is obtained from dimension synthesizing a 2-RPU-UPR rigid parallel mechanism with the method of optimization of motion/force transfer characteristic. R, P and U represent rotation, translation and universal pairs, respectively. Firstly, inverse kinematics and Jacobian matrix are analyzed for the dimensional synthesis. Then, output transmission indexes of branches in the parallel mechanism are given. Dimensional synthesis is completed based on the normalized design parameter. And optimization of flexure joints based on constrained energy is carried out. Afterwards, the novel compliant mechanism is obtained by direct replacing method. Mechanical model of the compliant mechanism including static stiffness and input stiffness is built based on the pseudo-rigid body modeling method and virtual work principle. Finally, FEA simulation by Ansys Workbench is carried out to verify DOF, effectiveness of the dimension synthesis, and compliant model. Optimization of motion/force transfer characteristic is first applied for the design of compliant mechanisms to suppress drift of rotation axis in the paper.
A novel compliant mechanism with RPR degrees of freedom (DOF) is proposed where R and P represent rotation and translation DOFs, respectively. The proposed compliant mechanism is obtained from dimension synthesizing a 2-RPU-UPR rigid parallel mechanism with the method of optimization of motion/force transfer characteristic. R, P and U represent rotation, translation and universal pairs, respectively. Firstly, inverse kinematics and Jacobian matrix are analyzed for the dimensional synthesis. Then, output transmission indexes of branches in the parallel mechanism are given. Dimensional synthesis is completed based on the normalized design parameter. And optimization of flexure joints based on constrained energy is carried out. Afterwards, the novel compliant mechanism is obtained by direct replacing method. Mechanical model of the compliant mechanism including static stiffness and input stiffness is built based on the pseudo-rigid body modeling method and virtual work principle. Finally, FEA simulation by Ansys Workbench is carried out to verify DOF, effectiveness of the dimension synthesis, and compliant model. Optimization of motion/force transfer characteristic is first applied for the design of compliant mechanisms to suppress drift of rotation axis in the paper.
2022, 35: 127.
doi: 10.1186/s10033-022-00800-6
Abstract:
High-speed parallel robots have been extensively utilized in the light industry. However, the influence of the nonlinear dynamic characteristics of high-speed parallel robots on system's dynamic response and stable operation cannot be ignored during the high-speed reciprocating motion. Thus, trajectory planning is essential for efficiency and stability from pick-and-place (PAP) actions. This paper presents a method for planning the equal-height pick-and-place trajectory considering velocity constraints to improve the PAP efficiency and stability of high-speed parallel robots. The velocity constraints in the start-and-end points can reduce vibration from picking and placing, making the trajectory more suitable to complex beltline situations. Based on velocity constraints, trajectory optimization includes trajectory smoothness and joint torque to optimize cycle time is carried out. This paper proposes an online trajectory optimization solution. By using back propagation (BP) neural networks, the solution is simplified and can be solved in real-time. Simulation and experiments were carried out on the SR4 parallel robot. The results show that the proposed method improves the efficiency, smoothness, and stability of the robot. This paper proposes an online trajectory planning method which is velocity constraints based and can improve the efficiency and stability of high-speed parallel robots. The work of this research is conducive to finely applying high-speed parallel robots.
High-speed parallel robots have been extensively utilized in the light industry. However, the influence of the nonlinear dynamic characteristics of high-speed parallel robots on system's dynamic response and stable operation cannot be ignored during the high-speed reciprocating motion. Thus, trajectory planning is essential for efficiency and stability from pick-and-place (PAP) actions. This paper presents a method for planning the equal-height pick-and-place trajectory considering velocity constraints to improve the PAP efficiency and stability of high-speed parallel robots. The velocity constraints in the start-and-end points can reduce vibration from picking and placing, making the trajectory more suitable to complex beltline situations. Based on velocity constraints, trajectory optimization includes trajectory smoothness and joint torque to optimize cycle time is carried out. This paper proposes an online trajectory optimization solution. By using back propagation (BP) neural networks, the solution is simplified and can be solved in real-time. Simulation and experiments were carried out on the SR4 parallel robot. The results show that the proposed method improves the efficiency, smoothness, and stability of the robot. This paper proposes an online trajectory planning method which is velocity constraints based and can improve the efficiency and stability of high-speed parallel robots. The work of this research is conducive to finely applying high-speed parallel robots.
2022, 35: 130.
doi: 10.1186/s10033-022-00801-5
Abstract:
Reducing the radiated noise of a gearbox is a difficult problem in aviation, navigation, machinery, and other fields. Structural improvement is the main means of noise reduction for a gearbox, and it is realized primarily through contribution analysis and structure optimization. However, these approaches have certain limitations. In this study, a low-noise design method for a gearbox that combines the two approaches is proposed, and experimental verification is performed. First, a finite element/boundary element model is established using a single-stage herringbone gearbox. Considering the vibration excitation of the gear system, the radiation noise of a single-stage gearbox is predicted based on the modal acoustic transfer vector (MATV) method. Subsequently, the maximum field point of the radiated noise is determined, and the acoustic transfer vector (ATV) analysis and modal acoustic contribution (MAC) analysis are conducted to determine the region that contributes significantly to the radiated noise of the field point. The optimization region is selected through the panel acoustic contribution (PAC) analysis. Next, to reduce the normal speed in the optimization region, topology optimization is performed. According to the topology optimization results, four different noise reduction structures are added to the gearbox, and the low-noise optimization models are established respectively. Finally, by measuring the radiated noise of the gearbox before and after optimization under a given working condition, the validity of the radiated noise prediction method and the low-noise optimization design method are verified by comparing the simulation and experimental data. A comparison of the four optimization models proves that the noise reduction effect can be achieved only by adding a noise reduction structure to the center of the density nephogram.
Reducing the radiated noise of a gearbox is a difficult problem in aviation, navigation, machinery, and other fields. Structural improvement is the main means of noise reduction for a gearbox, and it is realized primarily through contribution analysis and structure optimization. However, these approaches have certain limitations. In this study, a low-noise design method for a gearbox that combines the two approaches is proposed, and experimental verification is performed. First, a finite element/boundary element model is established using a single-stage herringbone gearbox. Considering the vibration excitation of the gear system, the radiation noise of a single-stage gearbox is predicted based on the modal acoustic transfer vector (MATV) method. Subsequently, the maximum field point of the radiated noise is determined, and the acoustic transfer vector (ATV) analysis and modal acoustic contribution (MAC) analysis are conducted to determine the region that contributes significantly to the radiated noise of the field point. The optimization region is selected through the panel acoustic contribution (PAC) analysis. Next, to reduce the normal speed in the optimization region, topology optimization is performed. According to the topology optimization results, four different noise reduction structures are added to the gearbox, and the low-noise optimization models are established respectively. Finally, by measuring the radiated noise of the gearbox before and after optimization under a given working condition, the validity of the radiated noise prediction method and the low-noise optimization design method are verified by comparing the simulation and experimental data. A comparison of the four optimization models proves that the noise reduction effect can be achieved only by adding a noise reduction structure to the center of the density nephogram.
2022, 35: 135.
doi: 10.1186/s10033-022-00798-x
Abstract:
Selecting the optimal speed for dynamic obstacle avoidance in complex man–machine environments is a challenging problem for mobile robots inspecting hazardous gases. Consideration of personal space is important, especially in a relatively narrow man–machine dynamic environments such as warehouses and laboratories. In this study, human and robot behaviors in man–machine environments are analyzed, and a man–machine social force model is established to study the robot obstacle avoidance speed. Four typical man–machine behavior patterns are investigated to design the robot behavior strategy. Based on the social force model and man–machine behavior patterns, the fuzzy-PID trajectory tracking control method and the autonomous obstacle avoidance behavior strategy of the mobile robot in inspecting hazardous gases in a relatively narrow man–machine dynamic environment are proposed to determine the optimal robot speed for obstacle avoidance. The simulation analysis results show that compared with the traditional PID control method, the proposed controller has a position error of less than 0.098 m, an angle error of less than 0.088 rad, a smaller steady-state error, and a shorter convergence time. The crossing and encountering pattern experiment results show that the proposed behavior strategy ensures that the robot maintains a safe distance from humans while performing trajectory tracking. This research proposes a combination autonomous behavior strategy for mobile robots inspecting hazardous gases, ensuring that the robot maintains the optimal speed to achieve dynamic obstacle avoidance, reducing human anxiety and increasing comfort in a relatively narrow man–machine environment.
Selecting the optimal speed for dynamic obstacle avoidance in complex man–machine environments is a challenging problem for mobile robots inspecting hazardous gases. Consideration of personal space is important, especially in a relatively narrow man–machine dynamic environments such as warehouses and laboratories. In this study, human and robot behaviors in man–machine environments are analyzed, and a man–machine social force model is established to study the robot obstacle avoidance speed. Four typical man–machine behavior patterns are investigated to design the robot behavior strategy. Based on the social force model and man–machine behavior patterns, the fuzzy-PID trajectory tracking control method and the autonomous obstacle avoidance behavior strategy of the mobile robot in inspecting hazardous gases in a relatively narrow man–machine dynamic environment are proposed to determine the optimal robot speed for obstacle avoidance. The simulation analysis results show that compared with the traditional PID control method, the proposed controller has a position error of less than 0.098 m, an angle error of less than 0.088 rad, a smaller steady-state error, and a shorter convergence time. The crossing and encountering pattern experiment results show that the proposed behavior strategy ensures that the robot maintains a safe distance from humans while performing trajectory tracking. This research proposes a combination autonomous behavior strategy for mobile robots inspecting hazardous gases, ensuring that the robot maintains the optimal speed to achieve dynamic obstacle avoidance, reducing human anxiety and increasing comfort in a relatively narrow man–machine environment.
2022, 35: 138.
doi: 10.1186/s10033-022-00813-1
Abstract:
The teleoperation of a 6 degrees-of-freedom (DOF) manipulator is one of the basic methods to extend people's capabilities in the wide variety of applications. The master interface based on the force/torque (FT) sensor could provide the full-dimension intuitive teleoperation of a 6-DOF robot since it has the ability to trigger 6-DOF command input. However, due to the force coupling, noise disturbance and unlimited input signals of the FT sensor, this force-sensed interface could not be widely used in practice. In this paper, we present an intuitive teleoperation method based on the FT sensor to overcome these challenges. In this method, the input signals from the force-sensed joystick were filtered and then processed to the force commands by force limit algorithm, with the merits of anti-interference, output limitation, and online velocity adjustment. Furthermore, based on the admittance control and position controller, the manipulator could be teleoperated by the force commands. Three experiments were conducted on our self-designed robotic system. The result of the first experiment shows that the interfered force from the force coupling could be effectively suppressed with the limitation of the input force through force limit algorithm. Then, a parameter was introduced in the other two experiments to adjust the velocity online practically with force limit algorithm. The proposed method could give a practical solution to the intuitive teleoperation based on the FT sensor.
The teleoperation of a 6 degrees-of-freedom (DOF) manipulator is one of the basic methods to extend people's capabilities in the wide variety of applications. The master interface based on the force/torque (FT) sensor could provide the full-dimension intuitive teleoperation of a 6-DOF robot since it has the ability to trigger 6-DOF command input. However, due to the force coupling, noise disturbance and unlimited input signals of the FT sensor, this force-sensed interface could not be widely used in practice. In this paper, we present an intuitive teleoperation method based on the FT sensor to overcome these challenges. In this method, the input signals from the force-sensed joystick were filtered and then processed to the force commands by force limit algorithm, with the merits of anti-interference, output limitation, and online velocity adjustment. Furthermore, based on the admittance control and position controller, the manipulator could be teleoperated by the force commands. Three experiments were conducted on our self-designed robotic system. The result of the first experiment shows that the interfered force from the force coupling could be effectively suppressed with the limitation of the input force through force limit algorithm. Then, a parameter was introduced in the other two experiments to adjust the velocity online practically with force limit algorithm. The proposed method could give a practical solution to the intuitive teleoperation based on the FT sensor.
2022, 35: 141.
doi: 10.1186/s10033-022-00811-3
Abstract:
Polishing plays an indispensable role in optical processing, especially for large-aperture optical reflective mirrors with freeform surfaces. Robotic polishing requires effective control of the contact force between the robot and the mirror during processing. In order to maintain a constant contact force during polishing, traditional polishing robots rely on closed-loop control of air cylinders, whose performances heavily rely on high-fidelity force sensing and real-time control. This paper proposes to employ a compliant constant-force mechanism in the end-effector of a polishing robot to passively maintain a constant force between the robot and the mirror, thus eliminating the requirement for force sensing and closed-loop control. The compliant constant force mechanism utilizing the second bending mode of fixed-guided compliant beams is adopted and elaborated for the passive end-effector. An end-effector providing a constant contact force of 40 N is designed and prototyped. The polishing experiment shows that the passive constant-force end-effector provides stable contact force between the robot and the mirror with fluctuation within 3.43 N, and achieves RMS (Root Mean Square) lower than λ/10 (λ = 632.8 nm) of the polished surface of the large-aperture optical reflective mirror. It is concluded that the constant-force compliant mechanism provides a low-cost and reliable solution for force control in robotic polishing.
Polishing plays an indispensable role in optical processing, especially for large-aperture optical reflective mirrors with freeform surfaces. Robotic polishing requires effective control of the contact force between the robot and the mirror during processing. In order to maintain a constant contact force during polishing, traditional polishing robots rely on closed-loop control of air cylinders, whose performances heavily rely on high-fidelity force sensing and real-time control. This paper proposes to employ a compliant constant-force mechanism in the end-effector of a polishing robot to passively maintain a constant force between the robot and the mirror, thus eliminating the requirement for force sensing and closed-loop control. The compliant constant force mechanism utilizing the second bending mode of fixed-guided compliant beams is adopted and elaborated for the passive end-effector. An end-effector providing a constant contact force of 40 N is designed and prototyped. The polishing experiment shows that the passive constant-force end-effector provides stable contact force between the robot and the mirror with fluctuation within 3.43 N, and achieves RMS (Root Mean Square) lower than λ/10 (λ = 632.8 nm) of the polished surface of the large-aperture optical reflective mirror. It is concluded that the constant-force compliant mechanism provides a low-cost and reliable solution for force control in robotic polishing.
2022, 35: 149.
doi: 10.1186/s10033-022-00821-1
Abstract:
An industrial robot with a six-axis force/torque sensor is usually used to produce a zero-gravity environment for testing space robotic operations. However, using traditional force control methods, such as admittance control, causes position-controlled industrial robots to undergo from force divergence owing to intrinsic time delay. In this paper, a new force control method is proposed to eliminate the force divergence. A hardware-in-the-loop (HIL) simulator with an industrial robot is first presented. The free-floating satellite dynamics and the motion mapping from the satellites to simulator are both established. Thus, the effects of measurement delay and dynamic response delay on contact velocity and force are investigated. After that, a real-time estimation method for contact stiffness and damping is proposed based on the adaptive Kalman filter. The measurement delay is compensated by a phase lead model. Moreover, the identified contact parameters are adopted to modify contact forces, and thus the dynamics response delay can be compensated for. Finally, a co-simulation and experiments were conducted to verify the force control method. The results show that contact stiffness and damping could be identified exactly and that the simulation divergence could be prevented. This paper proposes an active compliance control method that can deal with force constrained tasks of a position-controlled robot in unknown environments.
An industrial robot with a six-axis force/torque sensor is usually used to produce a zero-gravity environment for testing space robotic operations. However, using traditional force control methods, such as admittance control, causes position-controlled industrial robots to undergo from force divergence owing to intrinsic time delay. In this paper, a new force control method is proposed to eliminate the force divergence. A hardware-in-the-loop (HIL) simulator with an industrial robot is first presented. The free-floating satellite dynamics and the motion mapping from the satellites to simulator are both established. Thus, the effects of measurement delay and dynamic response delay on contact velocity and force are investigated. After that, a real-time estimation method for contact stiffness and damping is proposed based on the adaptive Kalman filter. The measurement delay is compensated by a phase lead model. Moreover, the identified contact parameters are adopted to modify contact forces, and thus the dynamics response delay can be compensated for. Finally, a co-simulation and experiments were conducted to verify the force control method. The results show that contact stiffness and damping could be identified exactly and that the simulation divergence could be prevented. This paper proposes an active compliance control method that can deal with force constrained tasks of a position-controlled robot in unknown environments.
2022, 35: 3.
doi: 10.1186/s10033-021-00667-z
Abstract:
The application of cutting fluid in the field of engineering manufacturing has a history of hundreds of years, and it plays a vital role in the processing efficiency and surface quality of parts. Among them, water-based cutting fluid accounts for more than 90% of the consumption of cutting fluid. However, long-term recycling of water-based cutting fluid could easily cause deterioration, and the breeding of bacteria could cause the cutting fluid to fail, increase manufacturing costs, and even endanger the health of workers. Traditional bactericides could improve the biological stability of cutting fluids, but they are toxic to the environment and do not conform to the development trend of low-carbon manufacturing. Low-carbon manufacturing is inevitable and the direction of sustainable manufacturing. The use of nanomaterials, transition metal complexes, and physical sterilization methods on the bacterial cell membrane and genetic material could effectively solve this problem. In this article, the mechanism of action of additives and microbial metabolites was first analyzed. Then, the denaturation mechanism of traditional bactericides on the target protein and the effect of sterilization efficiency were summarized. Further, the mechanism of nanomaterials disrupting cell membrane potential was discussed. The effects of lipophilicity and the atomic number of transition metal complexes on cell membrane penetration were also summarized, and the effects of ultraviolet rays and ozone on the destruction of bacterial genetic material were reviewed. In other words, the bactericidal performance, hazard, degradability, and economics of various sterilization methods were comprehensively evaluated, and the potential development direction of improving the biological stability of cutting fluid was proposed.
The application of cutting fluid in the field of engineering manufacturing has a history of hundreds of years, and it plays a vital role in the processing efficiency and surface quality of parts. Among them, water-based cutting fluid accounts for more than 90% of the consumption of cutting fluid. However, long-term recycling of water-based cutting fluid could easily cause deterioration, and the breeding of bacteria could cause the cutting fluid to fail, increase manufacturing costs, and even endanger the health of workers. Traditional bactericides could improve the biological stability of cutting fluids, but they are toxic to the environment and do not conform to the development trend of low-carbon manufacturing. Low-carbon manufacturing is inevitable and the direction of sustainable manufacturing. The use of nanomaterials, transition metal complexes, and physical sterilization methods on the bacterial cell membrane and genetic material could effectively solve this problem. In this article, the mechanism of action of additives and microbial metabolites was first analyzed. Then, the denaturation mechanism of traditional bactericides on the target protein and the effect of sterilization efficiency were summarized. Further, the mechanism of nanomaterials disrupting cell membrane potential was discussed. The effects of lipophilicity and the atomic number of transition metal complexes on cell membrane penetration were also summarized, and the effects of ultraviolet rays and ozone on the destruction of bacterial genetic material were reviewed. In other words, the bactericidal performance, hazard, degradability, and economics of various sterilization methods were comprehensively evaluated, and the potential development direction of improving the biological stability of cutting fluid was proposed.
2022, 35: 5.
doi: 10.1186/s10033-021-00674-0
Abstract:
With the rapid developments of marine resource exploitation, mounts of marine engineering equipment are settled on the ocean. When it is not possible to move the damaged equipment into a dry dock, welding operations must be performed in underwater environments. The underwater laser welding/cladding technique is a promising and advanced technique which could be widely applied to the maintenance of the damaged equipment. The present review paper aims to present a critical analysis and engineering overview of the underwater laser welding/cladding technique. First, we elaborated recent advances and key issues of drainage nozzles all over the world. Next, we presented the underwater laser processing and microstructural-mechanical behavior of repaired marine materials. Then, the newly developed powder-feeding based and wire-feeding based underwater laser direct metal deposition techniques were reviewed. The differences between the convection, conduction, and the metallurgical kinetics in the melt pools during underwater laser direct metal deposition and in-air laser direct metal deposition were illustrated. After that, several challenges that need to be overcame to achieve the full potential of the underwater laser welding/cladding technique are proposed. Finally, suggestions for future directions to aid the development of underwater laser welding/cladding technology and underwater metallurgical theory are provided. The present review will not only enrich the knowledge in the underwater repair technology, but also provide important guidance for the potential applications of the technology on the marine engineering.
With the rapid developments of marine resource exploitation, mounts of marine engineering equipment are settled on the ocean. When it is not possible to move the damaged equipment into a dry dock, welding operations must be performed in underwater environments. The underwater laser welding/cladding technique is a promising and advanced technique which could be widely applied to the maintenance of the damaged equipment. The present review paper aims to present a critical analysis and engineering overview of the underwater laser welding/cladding technique. First, we elaborated recent advances and key issues of drainage nozzles all over the world. Next, we presented the underwater laser processing and microstructural-mechanical behavior of repaired marine materials. Then, the newly developed powder-feeding based and wire-feeding based underwater laser direct metal deposition techniques were reviewed. The differences between the convection, conduction, and the metallurgical kinetics in the melt pools during underwater laser direct metal deposition and in-air laser direct metal deposition were illustrated. After that, several challenges that need to be overcame to achieve the full potential of the underwater laser welding/cladding technique are proposed. Finally, suggestions for future directions to aid the development of underwater laser welding/cladding technology and underwater metallurgical theory are provided. The present review will not only enrich the knowledge in the underwater repair technology, but also provide important guidance for the potential applications of the technology on the marine engineering.
2022, 35: 6.
doi: 10.1186/s10033-021-00675-z
Abstract:
Many surveys on vehicle traffic safety have shown that the tire road friction coefficient (TRFC) is correlated with the probability of an accident. The probability of road accidents increases sharply on slippery road surfaces. Therefore, accurate knowledge of TRFC contributes to the optimization of driver maneuvers for further improving the safety of intelligent vehicles. A large number of researchers have employed different tools and proposed different algorithms to obtain TRFC. This work investigates these different methods that have been widely utilized to estimate TRFC. These methods are divided into three main categories: off-board sensors-based, vehicle dynamics-based, and data-driven-based methods. This review provides a comparative analysis of these methods and describes their strengths and weaknesses. Moreover, some future research directions regarding TRFC estimation are presented.
Many surveys on vehicle traffic safety have shown that the tire road friction coefficient (TRFC) is correlated with the probability of an accident. The probability of road accidents increases sharply on slippery road surfaces. Therefore, accurate knowledge of TRFC contributes to the optimization of driver maneuvers for further improving the safety of intelligent vehicles. A large number of researchers have employed different tools and proposed different algorithms to obtain TRFC. This work investigates these different methods that have been widely utilized to estimate TRFC. These methods are divided into three main categories: off-board sensors-based, vehicle dynamics-based, and data-driven-based methods. This review provides a comparative analysis of these methods and describes their strengths and weaknesses. Moreover, some future research directions regarding TRFC estimation are presented.
2022, 35: 21.
doi: 10.1186/s10033-022-00686-4
Abstract:
The formation of a precursor film (PF) is always coupled with better wettability; thus, clarifying the formation mechanism is required to optimize the interfacial structures. However, recent research focuses on inert wetting systems at room temperature, which cannot guide practical material processing at high temperatures. In this review, PF formation mechanisms at high temperatures were reviewed. The mechanisms are surface diffusion, evaporation–condensation, subcutaneous infiltration, and rapid absorption and film overflow. In experimental metal/metal systems, the most probable mechanism is subcutaneous infiltration, related to the apparent contact angle, radius, and height of the gap between the substrate metal and the oxide film. The rapid absorption and film overflow mechanism usually occurs in metal/ceramic systems. The PF appearance for the adsorption mechanism must satisfy the paradox, that is, the relative inertial and high-affinity liquid/solid interface. Finally, another possible mechanism of PF appearance for the reactive wetting system at high temperatures was proposed, that is, the thin-surface transport mechanism. The PF formation is sensitive to external conditions. Therefore, it is necessary to develop thermodynamic and dynamic models for predicting and simulating PFs.
The formation of a precursor film (PF) is always coupled with better wettability; thus, clarifying the formation mechanism is required to optimize the interfacial structures. However, recent research focuses on inert wetting systems at room temperature, which cannot guide practical material processing at high temperatures. In this review, PF formation mechanisms at high temperatures were reviewed. The mechanisms are surface diffusion, evaporation–condensation, subcutaneous infiltration, and rapid absorption and film overflow. In experimental metal/metal systems, the most probable mechanism is subcutaneous infiltration, related to the apparent contact angle, radius, and height of the gap between the substrate metal and the oxide film. The rapid absorption and film overflow mechanism usually occurs in metal/ceramic systems. The PF appearance for the adsorption mechanism must satisfy the paradox, that is, the relative inertial and high-affinity liquid/solid interface. Finally, another possible mechanism of PF appearance for the reactive wetting system at high temperatures was proposed, that is, the thin-surface transport mechanism. The PF formation is sensitive to external conditions. Therefore, it is necessary to develop thermodynamic and dynamic models for predicting and simulating PFs.
A Review of Smart Materials for the Boost of Soft Actuators, Soft Sensors, and Robotics Applications
2022, 35: 37.
doi: 10.1186/s10033-022-00707-2
Abstract:
With the advance of smart material science, robotics is evolving from rigid robots to soft robots. Compared to rigid robots, soft robots can safely interact with the environment, easily navigate in unstructured fields, and be minimized to operate in narrow spaces, owning to the new actuation and sensing technologies developed by the smart materials. In the review, different actuation and sensing technologies based on different smart materials are analyzed and summarized. According to the driving or feedback signals, actuators are categorized into electrically responsive actuators, thermally responsive actuators, magnetically responsive actuators, and photoresponsive actuators; sensors are categorized into resistive sensors, capacitive sensors, magnetic sensors, and optical waveguide sensors. After introducing the principle and several robotic prototypes of some typical materials in each category of the actuators and sensors. The advantages and disadvantages of the actuators and sensors are compared based on the categories, and their potential applications in robotics are also presented.
With the advance of smart material science, robotics is evolving from rigid robots to soft robots. Compared to rigid robots, soft robots can safely interact with the environment, easily navigate in unstructured fields, and be minimized to operate in narrow spaces, owning to the new actuation and sensing technologies developed by the smart materials. In the review, different actuation and sensing technologies based on different smart materials are analyzed and summarized. According to the driving or feedback signals, actuators are categorized into electrically responsive actuators, thermally responsive actuators, magnetically responsive actuators, and photoresponsive actuators; sensors are categorized into resistive sensors, capacitive sensors, magnetic sensors, and optical waveguide sensors. After introducing the principle and several robotic prototypes of some typical materials in each category of the actuators and sensors. The advantages and disadvantages of the actuators and sensors are compared based on the categories, and their potential applications in robotics are also presented.
2022, 35: 67.
doi: 10.1186/s10033-022-00720-5
Abstract:
With the widespread application of the computer and microelectronic technology in the industry, digitization becomes the inevitable developing trend of the hydraulic technology. Digitization of the hydraulic components is critical in the digital hydraulic technology. High-speed on-off valves (HSVs) which convert a train of input pulses into the fast and accurate switching between the on and off states belong to widely used basic digital hydraulic elements. In some ways, the characteristics of the HSVs determine the performance of the digital hydraulic systems. This paper discusses the development of HSVs and their applications. First, the HSVs with innovative structures which is classified into direct drive valves and pilot operated valves are discussed, with the emphasis on their performance. Then, an overview of HSVs with intelligent materials is presented with considering of the switching frequency and flow capacity. Finally, the applications of the HSVs are reviewed, including digital hydraulic components with the integration of the HSVs and digital hydraulic systems controlled by the HSVs.
With the widespread application of the computer and microelectronic technology in the industry, digitization becomes the inevitable developing trend of the hydraulic technology. Digitization of the hydraulic components is critical in the digital hydraulic technology. High-speed on-off valves (HSVs) which convert a train of input pulses into the fast and accurate switching between the on and off states belong to widely used basic digital hydraulic elements. In some ways, the characteristics of the HSVs determine the performance of the digital hydraulic systems. This paper discusses the development of HSVs and their applications. First, the HSVs with innovative structures which is classified into direct drive valves and pilot operated valves are discussed, with the emphasis on their performance. Then, an overview of HSVs with intelligent materials is presented with considering of the switching frequency and flow capacity. Finally, the applications of the HSVs are reviewed, including digital hydraulic components with the integration of the HSVs and digital hydraulic systems controlled by the HSVs.
2022, 35: 80.
doi: 10.1186/s10033-022-00760-x
Abstract:
Traditional design, manufacturing and maintenance are run and managed independently under their own rules and regulations in an increasingly time-and-cost ineffective manner. A unified platform for efficient and intelligent design-manufacturing-maintenance of mechanical equipment and systems is highly needed in this rapidly digitized world. In this work, the definition of digital twin and its research progress and associated challenges in the design, manufacturing and maintenance of engineering components and equipment were thoroughly reviewed. It is indicated that digital twin concept and associated technology provide a feasible solution for the integration of design-manufacturing-maintenance as it has behaved in the entire lifecycle of products. For this aim, a framework for information-physical combination, in which a more accurate design, a defect-free manufacturing, a more intelligent maintenance, and a more advanced sensing technology, is prospected.
Traditional design, manufacturing and maintenance are run and managed independently under their own rules and regulations in an increasingly time-and-cost ineffective manner. A unified platform for efficient and intelligent design-manufacturing-maintenance of mechanical equipment and systems is highly needed in this rapidly digitized world. In this work, the definition of digital twin and its research progress and associated challenges in the design, manufacturing and maintenance of engineering components and equipment were thoroughly reviewed. It is indicated that digital twin concept and associated technology provide a feasible solution for the integration of design-manufacturing-maintenance as it has behaved in the entire lifecycle of products. For this aim, a framework for information-physical combination, in which a more accurate design, a defect-free manufacturing, a more intelligent maintenance, and a more advanced sensing technology, is prospected.
2022, 35: 97.
doi: 10.1186/s10033-022-00780-7
Abstract:
Multi-scale casting parts are important components of high-end equipment used in the aerospace, automobile manufacturing, shipbuilding, and other industries. Residual features such as parting lines and pouring risers that inevitably appear during the casting process are random in size, morphology, and distribution. The traditional manual processing method has disadvantages such as low efficiency, high labor intensity, and harsh working environment. Existing machine tool and serial robot grinding/cutting equipment do not easily achieve high-quality and high-efficiency removal of residual features due to poor dexterity and low stiffness, respectively. To address these problems, a five-degree-of-freedom (5-DoF) hybrid grinding/cutting robot with high dexterity and high stiffness is proposed. Based on it, three types of grinding/cutting equipment combined with offline programming, master-slave control, and other technologies are developed to remove the residual features of small, medium, and large casting parts. Finally, the advantages of teleoperation processing and other solutions are elaborated, and the difficulties and challenges are discussed. This paper reviews the grinding/cutting technology and equipment of casting parts and provides a reference for the research on the processing of multi-scale casting parts.
Multi-scale casting parts are important components of high-end equipment used in the aerospace, automobile manufacturing, shipbuilding, and other industries. Residual features such as parting lines and pouring risers that inevitably appear during the casting process are random in size, morphology, and distribution. The traditional manual processing method has disadvantages such as low efficiency, high labor intensity, and harsh working environment. Existing machine tool and serial robot grinding/cutting equipment do not easily achieve high-quality and high-efficiency removal of residual features due to poor dexterity and low stiffness, respectively. To address these problems, a five-degree-of-freedom (5-DoF) hybrid grinding/cutting robot with high dexterity and high stiffness is proposed. Based on it, three types of grinding/cutting equipment combined with offline programming, master-slave control, and other technologies are developed to remove the residual features of small, medium, and large casting parts. Finally, the advantages of teleoperation processing and other solutions are elaborated, and the difficulties and challenges are discussed. This paper reviews the grinding/cutting technology and equipment of casting parts and provides a reference for the research on the processing of multi-scale casting parts.
2022, 35: 103.
doi: 10.1186/s10033-022-00779-0
Abstract:
Design is a high-level and complex thinking activity of human beings, using existing knowledge and technology to solve problems and create new things. With the rise and development of intelligent manufacturing, design has increasingly reflected its importance in the product life cycle. Firstly, the concept and connotation of complex product design is expounded systematically, and the different types of design are discussed. The four schools of design theory are introduced, including universal design, axiomatic design, TRIZ and general design. Then the research status of complex product design is analyzed, such as innovative design, digital design, modular design, reliability optimization design, etc. Finally, three key scientific issues worthy of research in the future are indicated, and five research trends of "newer, better, smarter, faster, and greener" are summarized, aiming to provide references for the equipment design and manufacturing industry.
Design is a high-level and complex thinking activity of human beings, using existing knowledge and technology to solve problems and create new things. With the rise and development of intelligent manufacturing, design has increasingly reflected its importance in the product life cycle. Firstly, the concept and connotation of complex product design is expounded systematically, and the different types of design are discussed. The four schools of design theory are introduced, including universal design, axiomatic design, TRIZ and general design. Then the research status of complex product design is analyzed, such as innovative design, digital design, modular design, reliability optimization design, etc. Finally, three key scientific issues worthy of research in the future are indicated, and five research trends of "newer, better, smarter, faster, and greener" are summarized, aiming to provide references for the equipment design and manufacturing industry.
2022, 35: 114.
doi: 10.1186/s10033-022-00791-4
Abstract:
Fishes have learned how to achieve outstanding swimming performance through the evolution of hundreds of millions of years, which can provide bio-inspiration for robotic fish design. The premise of designing an excellent robotic fish include fully understanding of fish locomotion mechanism and grasp of the advanced control strategy in robot domain. In this paper, the research development on fish swimming is presented, aiming to offer a reference for the later research. First, the research methods including experimental methods and simulation methods are detailed. Then the current research directions including fish locomotion mechanism, structure and function research and bionic robotic fish are outlined. Fish locomotion mechanism is discussed from three views: macroscopic view to find a unified principle, microscopic view to include muscle activity and intermediate view to study the behaviors of single fish and fish school. Structure and function research is mainly concentrated from three aspects: fin research, lateral line system and body stiffness. Bionic robotic fish research focuses on actuation, materials and motion control. The paper concludes with the future trend that curvature control, machine learning and multiple robotic fish system will play a more important role in this field. Overall, the intensive and comprehensive research on fish swimming will decrease the gap between robotic fish and real fish and contribute to the broad application prospect of robotic fish.
Fishes have learned how to achieve outstanding swimming performance through the evolution of hundreds of millions of years, which can provide bio-inspiration for robotic fish design. The premise of designing an excellent robotic fish include fully understanding of fish locomotion mechanism and grasp of the advanced control strategy in robot domain. In this paper, the research development on fish swimming is presented, aiming to offer a reference for the later research. First, the research methods including experimental methods and simulation methods are detailed. Then the current research directions including fish locomotion mechanism, structure and function research and bionic robotic fish are outlined. Fish locomotion mechanism is discussed from three views: macroscopic view to find a unified principle, microscopic view to include muscle activity and intermediate view to study the behaviors of single fish and fish school. Structure and function research is mainly concentrated from three aspects: fin research, lateral line system and body stiffness. Bionic robotic fish research focuses on actuation, materials and motion control. The paper concludes with the future trend that curvature control, machine learning and multiple robotic fish system will play a more important role in this field. Overall, the intensive and comprehensive research on fish swimming will decrease the gap between robotic fish and real fish and contribute to the broad application prospect of robotic fish.
2022, 35: 142.
doi: 10.1186/s10033-022-00814-0
Abstract:
Owing to superior comprehensive performance than conventional superalloys at high temperature, refractory high entropy alloy (RHEA) is becoming a promising candidate for the next generation high-temperature material. Herein, contemporary aspects of corresponding development of RHEAs are reviewed to discuss various factors affecting the organization structure and service performance. It mainly covers alloying system and strengthening mechanism, the preparation method, plastic deformation and the related mechanism, as well as microstructure control by heat treatment. Firstly, the alloy systems and strengthening mechanism are introduced. This is followed by different preparation methods and the comparison of strengths and shortcomings based on different RHEAs. Then, hot deformation behavior and plastic deformation under different loadings are analyzed. Based on this, the influence of heat treatment on microstructures prior to and after the deformation is further summarized. Finally, some important research areas to be carried out in future are pointed out. This review will give a deep understanding of the effects of different factors on the service performance and provide scientific guide in designing RHEAs with improved performance.
Owing to superior comprehensive performance than conventional superalloys at high temperature, refractory high entropy alloy (RHEA) is becoming a promising candidate for the next generation high-temperature material. Herein, contemporary aspects of corresponding development of RHEAs are reviewed to discuss various factors affecting the organization structure and service performance. It mainly covers alloying system and strengthening mechanism, the preparation method, plastic deformation and the related mechanism, as well as microstructure control by heat treatment. Firstly, the alloy systems and strengthening mechanism are introduced. This is followed by different preparation methods and the comparison of strengths and shortcomings based on different RHEAs. Then, hot deformation behavior and plastic deformation under different loadings are analyzed. Based on this, the influence of heat treatment on microstructures prior to and after the deformation is further summarized. Finally, some important research areas to be carried out in future are pointed out. This review will give a deep understanding of the effects of different factors on the service performance and provide scientific guide in designing RHEAs with improved performance.
2022, 35: 148.
doi: 10.1186/s10033-022-00818-w
Abstract:
Drilling is regarded as the most complex manufacturing process compared with other conventional machining processes. During the drilling process, most of the energy consumed in metal cutting is converted to heat and increases temperature considerably. The resulting thermal phenomena are important since they influence the mode of deformation, the final metallurgical state of the machined surface, and the rate of tool wear. Hence, understanding the temperature characteristics in the drilling process is crucial for enhancing the drill performance and process efficiency. Extensive efforts have been conducted to measure and control the drilling tool temperature successively. However, very few studies have been conducted from a comprehensive perspective to review all the efforts. To address this gap in the literature, a rigorous review concerning the state-of-the-art results and advances in drilling tool temperature is presented in this paper by referring to the wide comparisons among literature analyses. The multiple aspects of drilling tool temperature are precisely detailed and discussed in terms of theoretical analysis and thermal modeling, methods for temperature measuring, the effect of cutting parameters, tool geometries and hole-making methods on temperature and temperature controlling by different cooling methods. In conclusion, several possible future research directions are discussed to offer potential insights for the drilling community and future researchers.
Drilling is regarded as the most complex manufacturing process compared with other conventional machining processes. During the drilling process, most of the energy consumed in metal cutting is converted to heat and increases temperature considerably. The resulting thermal phenomena are important since they influence the mode of deformation, the final metallurgical state of the machined surface, and the rate of tool wear. Hence, understanding the temperature characteristics in the drilling process is crucial for enhancing the drill performance and process efficiency. Extensive efforts have been conducted to measure and control the drilling tool temperature successively. However, very few studies have been conducted from a comprehensive perspective to review all the efforts. To address this gap in the literature, a rigorous review concerning the state-of-the-art results and advances in drilling tool temperature is presented in this paper by referring to the wide comparisons among literature analyses. The multiple aspects of drilling tool temperature are precisely detailed and discussed in terms of theoretical analysis and thermal modeling, methods for temperature measuring, the effect of cutting parameters, tool geometries and hole-making methods on temperature and temperature controlling by different cooling methods. In conclusion, several possible future research directions are discussed to offer potential insights for the drilling community and future researchers.
2022, 35: 10.
doi: 10.1186/s10033-022-00678-4
Abstract:
Adaptive wavelet filtering is a very important fault feature extraction method in the domain of condition monitoring; however, owing to the time-consuming computation and difficulty of choosing criteria used to represent incipient faults, the engineering applications are limited to some extent. To detect incipient gear faults at a fast speed, a new criterion is proposed to optimize the parameters of the modified impulsive wavelet for constructing an optimal wavelet filter to detect impulsive gear faults. First, a new criterion based on spectral negentropy is proposed. Then, a novel search strategy is applied to optimize the parameters of the impulsive wavelet based on the new criterion. Finally, envelope spectral analysis is applied to determine the incipient fault characteristic frequency. Both the simulation and experimental validation demonstrated the superiority of the proposed approach.
Adaptive wavelet filtering is a very important fault feature extraction method in the domain of condition monitoring; however, owing to the time-consuming computation and difficulty of choosing criteria used to represent incipient faults, the engineering applications are limited to some extent. To detect incipient gear faults at a fast speed, a new criterion is proposed to optimize the parameters of the modified impulsive wavelet for constructing an optimal wavelet filter to detect impulsive gear faults. First, a new criterion based on spectral negentropy is proposed. Then, a novel search strategy is applied to optimize the parameters of the impulsive wavelet based on the new criterion. Finally, envelope spectral analysis is applied to determine the incipient fault characteristic frequency. Both the simulation and experimental validation demonstrated the superiority of the proposed approach.
2022, 35: 12.
doi: 10.1186/s10033-022-00683-7
Abstract:
The connection between production scheduling and transportation scheduling is getting closer in smart manufacturing system, and both of those problems are summarized as NP-hard problems. However, only a few studies have considered them simultaneously. This paper solves the integrated production and transportation scheduling problem (IPTSP) in hybrid flow shops, which is an extension of the hybrid flow shop scheduling problem (HFSP). In addition to the production scheduling on machines, the transportation scheduling process on automated guided vehicles (AGVs) is considered as another optimization process. In this problem, the transfer tasks of jobs are performed by a certain number of AGVs. To solve it, we make some preparation (including the establishment of task pool, the new solution representation and the new solution evaluation), which can ensure that satisfactory solutions can be found efficiently while appropriately reducing the scale of search space. Then, an effective genetic tabu search algorithm is used to minimize the makespan. Finally, two groups of instances are designed and three types of experiments are conducted to evaluate the performance of the proposed method. The results show that the proposed method is effective to solve the integrated production and transportation scheduling problem.
The connection between production scheduling and transportation scheduling is getting closer in smart manufacturing system, and both of those problems are summarized as NP-hard problems. However, only a few studies have considered them simultaneously. This paper solves the integrated production and transportation scheduling problem (IPTSP) in hybrid flow shops, which is an extension of the hybrid flow shop scheduling problem (HFSP). In addition to the production scheduling on machines, the transportation scheduling process on automated guided vehicles (AGVs) is considered as another optimization process. In this problem, the transfer tasks of jobs are performed by a certain number of AGVs. To solve it, we make some preparation (including the establishment of task pool, the new solution representation and the new solution evaluation), which can ensure that satisfactory solutions can be found efficiently while appropriately reducing the scale of search space. Then, an effective genetic tabu search algorithm is used to minimize the makespan. Finally, two groups of instances are designed and three types of experiments are conducted to evaluate the performance of the proposed method. The results show that the proposed method is effective to solve the integrated production and transportation scheduling problem.
2022, 35: 14.
doi: 10.1186/s10033-022-00677-5
Abstract:
Variational mode decomposition (VMD) has been proved to be useful for extraction of fault-induced transients of rolling bearings. Multi-bandwidth mode manifold (Triple M, TM) is one variation of the VMD, which units multiple fault-related modes with different bandwidths by a nonlinear manifold learning algorithm named local tangent space alignment (LTSA). The merit of the TM method is that the bearing fault-induced transients extracted contain low level of in-band noise without optimization of the VMD parameters. However, the determination of the neighborhood size of the LTSA is time-consuming, and the extracted fault-induced transients may have the problem of asymmetry in the up-and-down direction. This paper aims to improve the efficiency and waveform symmetry of the TM method. Specifically, the multi-bandwidth modes consisting of the fault-related modes with different bandwidths are first obtained by repeating the recycling VMD (RVMD) method with different bandwidth balance parameters. Then, the LTSA algorithm is performed on the multi-bandwidth modes to extract their inherent manifold structure, in which the natural nearest neighbor (Triple N, TN) algorithm is adopted to efficiently and reasonably select the neighbors of each data point in the multi-bandwidth modes. Finally, a weight-based feature compensation strategy is designed to synthesize the low-dimensional manifold features to alleviate the asymmetry problem, resulting in a symmetric TM feature that can represent the real fault transient components. The major contribution of the improved TM method for bearing fault diagnosis is that the pure fault-induced transients are extracted efficiently and are symmetrical as the real. One simulation analysis and two experimental applications in bearing fault diagnosis validate the enhanced performance of the improved TM method over the traditional methods. This research proposes a bearing fault diagnosis method which has the advantages of high efficiency, good waveform symmetry and enhanced in-band noise removal capability.
Variational mode decomposition (VMD) has been proved to be useful for extraction of fault-induced transients of rolling bearings. Multi-bandwidth mode manifold (Triple M, TM) is one variation of the VMD, which units multiple fault-related modes with different bandwidths by a nonlinear manifold learning algorithm named local tangent space alignment (LTSA). The merit of the TM method is that the bearing fault-induced transients extracted contain low level of in-band noise without optimization of the VMD parameters. However, the determination of the neighborhood size of the LTSA is time-consuming, and the extracted fault-induced transients may have the problem of asymmetry in the up-and-down direction. This paper aims to improve the efficiency and waveform symmetry of the TM method. Specifically, the multi-bandwidth modes consisting of the fault-related modes with different bandwidths are first obtained by repeating the recycling VMD (RVMD) method with different bandwidth balance parameters. Then, the LTSA algorithm is performed on the multi-bandwidth modes to extract their inherent manifold structure, in which the natural nearest neighbor (Triple N, TN) algorithm is adopted to efficiently and reasonably select the neighbors of each data point in the multi-bandwidth modes. Finally, a weight-based feature compensation strategy is designed to synthesize the low-dimensional manifold features to alleviate the asymmetry problem, resulting in a symmetric TM feature that can represent the real fault transient components. The major contribution of the improved TM method for bearing fault diagnosis is that the pure fault-induced transients are extracted efficiently and are symmetrical as the real. One simulation analysis and two experimental applications in bearing fault diagnosis validate the enhanced performance of the improved TM method over the traditional methods. This research proposes a bearing fault diagnosis method which has the advantages of high efficiency, good waveform symmetry and enhanced in-band noise removal capability.
2022, 35: 15.
doi: 10.1186/s10033-022-00681-9
Abstract:
The liner of a CNG pressure vessel is manufactured by a DDI (deep drawing and ironing) process for the cylinder part, which is a continuous process that includes a drawing process to reduce the diameter of the billet and a subsequent ironing process to reduce the thickness of the billet. A tractrix die used in the 1st deep drawing allows the blank to flow smoothly by decreasing the punch load and radial tensile stress occurring in the workpiece. It also increases the draw ratio compared to conventional dies, but it causes forming defects. In this study, a shape coefficient (Sc) is proposed for the tractrix die using the blank diameter (D0), inflow diameter of the workpiece (di), and inflow angle of the workpiece (θ) for design of the tractrix die. The effects of the thickness and inflow angle of the workpiece on wrinkling and folding were investigated through FEA. Also, a discriminant is proposed for the relative radial stress (\begin{document}$\tilde{\sigma}$\end{document}
The liner of a CNG pressure vessel is manufactured by a DDI (deep drawing and ironing) process for the cylinder part, which is a continuous process that includes a drawing process to reduce the diameter of the billet and a subsequent ironing process to reduce the thickness of the billet. A tractrix die used in the 1st deep drawing allows the blank to flow smoothly by decreasing the punch load and radial tensile stress occurring in the workpiece. It also increases the draw ratio compared to conventional dies, but it causes forming defects. In this study, a shape coefficient (Sc) is proposed for the tractrix die using the blank diameter (D0), inflow diameter of the workpiece (di), and inflow angle of the workpiece (θ) for design of the tractrix die. The effects of the thickness and inflow angle of the workpiece on wrinkling and folding were investigated through FEA. Also, a discriminant is proposed for the relative radial stress (
2022, 35: 17.
doi: 10.1186/s10033-022-00685-5
Abstract:
Accurate quantification of external force is the key to improve the high-precision hemming of autobody closure panels. However, the mechanism of external force on forming quality of complex contour sheet metal with adhesive is not clear subjected to geometric curvature and materials. In the present study, taking the curved edge aluminum sheet as the research object, SPH (smooth particle hydrodynamics) is introduced to simulate the viscous adhesive, and the SPH-FEM (Finite element method) coupling model of adhesive and panels considering the viscosity-pressure effect is established. The numerical simulation of the roller hemming process is carried out, then the validity and reliability of the proposed method are verified by measuring the external force in real time using triaxial force sensor. The multi-step forming process and the effect of external force on the roll in/out, surface wave and plastic strain of aluminum alloy sheet under the viscosity-pressure effect are studied, and the relationship between process parameters and external force is discussed. Results show that the coupling SPH-FEM model can well reflect the hemming process of curved edge structure. The normal force is about 2–3 times of the tangential force in the pre and final hemming process. Compared with the case without adhesive, the surface wave of flange part of the hemming with adhesive is slightly larger. The normal force and the tangential force increase about 90 N and 30 N respectively, when the height increases by 1 mm. It provides an important basis for the accurate control of hemming trajectory and the improvement of manufacturing quality of autobody closure panels.
Accurate quantification of external force is the key to improve the high-precision hemming of autobody closure panels. However, the mechanism of external force on forming quality of complex contour sheet metal with adhesive is not clear subjected to geometric curvature and materials. In the present study, taking the curved edge aluminum sheet as the research object, SPH (smooth particle hydrodynamics) is introduced to simulate the viscous adhesive, and the SPH-FEM (Finite element method) coupling model of adhesive and panels considering the viscosity-pressure effect is established. The numerical simulation of the roller hemming process is carried out, then the validity and reliability of the proposed method are verified by measuring the external force in real time using triaxial force sensor. The multi-step forming process and the effect of external force on the roll in/out, surface wave and plastic strain of aluminum alloy sheet under the viscosity-pressure effect are studied, and the relationship between process parameters and external force is discussed. Results show that the coupling SPH-FEM model can well reflect the hemming process of curved edge structure. The normal force is about 2–3 times of the tangential force in the pre and final hemming process. Compared with the case without adhesive, the surface wave of flange part of the hemming with adhesive is slightly larger. The normal force and the tangential force increase about 90 N and 30 N respectively, when the height increases by 1 mm. It provides an important basis for the accurate control of hemming trajectory and the improvement of manufacturing quality of autobody closure panels.
2022, 35: 19.
doi: 10.1186/s10033-022-00682-8
Abstract:
Full matrix focusing method of ultrasonic phased array has been proved with advantages of good signal-to-noise ratio and imaging resolution in the field of Ultrasonic NDT. However, it is still suffering from the time-consuming data acquisition and processing. In order to solve the problem, two simplified matrix focusing methods are provided in the paper. One provided method is a triangular matrix focusing algorithm based on the principle of reciprocity for the multi-channel ultrasonic system. The other provided method is a trapezoidal matrix focusing algorithm based on the energy weight of the different channel to the focusing area. Time of data acquisition and computational is decreased with the provided simplified matrix focusing methods. In order to prove the validity of two provided algorithms, both side-drilled holes and oblique cracks are used for imaging experiments. The experimental results show that the imaging quality of the triangular matrix focusing algorithm is basically consistent to that of the full matrix focusing method. And imaging quality of the trapezoidal matrix focusing algorithm is slightly reduced with the amount of multi-channel data decreasing. Both data acquisition and computational efficiency using the triangular matrix focusing algorithm and the trapezoidal matrix focusing algorithm have been improved significantly compared with original full matrix focusing method.
Full matrix focusing method of ultrasonic phased array has been proved with advantages of good signal-to-noise ratio and imaging resolution in the field of Ultrasonic NDT. However, it is still suffering from the time-consuming data acquisition and processing. In order to solve the problem, two simplified matrix focusing methods are provided in the paper. One provided method is a triangular matrix focusing algorithm based on the principle of reciprocity for the multi-channel ultrasonic system. The other provided method is a trapezoidal matrix focusing algorithm based on the energy weight of the different channel to the focusing area. Time of data acquisition and computational is decreased with the provided simplified matrix focusing methods. In order to prove the validity of two provided algorithms, both side-drilled holes and oblique cracks are used for imaging experiments. The experimental results show that the imaging quality of the triangular matrix focusing algorithm is basically consistent to that of the full matrix focusing method. And imaging quality of the trapezoidal matrix focusing algorithm is slightly reduced with the amount of multi-channel data decreasing. Both data acquisition and computational efficiency using the triangular matrix focusing algorithm and the trapezoidal matrix focusing algorithm have been improved significantly compared with original full matrix focusing method.
2022, 35: 22.
doi: 10.1186/s10033-022-00694-4
Abstract:
It is a difficult task to root the cause of the failure of a gas face seal because different causes may result in similar observations. In the work being presented, the discrimination of multiple types of abnormities in a spiral groove gas face seal is studied. A dynamic model is employed to analyze groups of cases in order to uncover the dynamic behaviors when the face contact is induced by different mixtures of abnormities, whose discriminative features when motion and contact are monitored are studied and uncovered. A circumferential-pattern-related oscillation phenomenon is discovered, which is extracted from contact information and implies the relative magnitude of the moment on stator and the rotor tilt. The experimental observation shows consistent results. It means that the grooves (or other circumferential patterns) generate useful informative features for monitoring. These results provide guidance for designing a monitored gas face seal system.
It is a difficult task to root the cause of the failure of a gas face seal because different causes may result in similar observations. In the work being presented, the discrimination of multiple types of abnormities in a spiral groove gas face seal is studied. A dynamic model is employed to analyze groups of cases in order to uncover the dynamic behaviors when the face contact is induced by different mixtures of abnormities, whose discriminative features when motion and contact are monitored are studied and uncovered. A circumferential-pattern-related oscillation phenomenon is discovered, which is extracted from contact information and implies the relative magnitude of the moment on stator and the rotor tilt. The experimental observation shows consistent results. It means that the grooves (or other circumferential patterns) generate useful informative features for monitoring. These results provide guidance for designing a monitored gas face seal system.
2022, 35: 30.
doi: 10.1186/s10033-022-00691-7
Abstract:
The research on surface texture is developing from single macro-texture to composite micro-nano texture. The current research on the anti-friction mechanism and theoretical models of textures is relatively weak. Studying the characteristics of different types of surface textures and determining the applicable working conditions of each texture is the focus of current research. In this paper, a mathematical model of hydrodynamic lubrication is established based on Navier–Stokes equations. The FLUENT software is used to simulate and analyze the four texture models, explore the dynamic pressure lubrication characteristics of different texture types, and provide data support for texture optimization. The key variable values required by the mathematical model are obtained through the simulation data. The friction coefficient of the texture under different working conditions was measured through friction and wear experiments, and the mathematical model was verified by the experimental results. The research results show that circular texture is suitable for low to medium speed and high load conditions, chevron texture is suitable for medium to high speed and medium to high load conditions, groove texture is suitable for high speed and low load conditions, and composite texture is suitable for high speed and medium to high load conditions. Comparing the experimental results with the results obtained by the mathematical model, it is found that the two are basically the same in the ranking of the anti-friction performance of different textures, and there is an error of 10%−40% in the friction coefficient value. In this study, a mathematical model of hydrodynamic lubrication was proposed, and the solution method of the optimal surface texture model was determined.
The research on surface texture is developing from single macro-texture to composite micro-nano texture. The current research on the anti-friction mechanism and theoretical models of textures is relatively weak. Studying the characteristics of different types of surface textures and determining the applicable working conditions of each texture is the focus of current research. In this paper, a mathematical model of hydrodynamic lubrication is established based on Navier–Stokes equations. The FLUENT software is used to simulate and analyze the four texture models, explore the dynamic pressure lubrication characteristics of different texture types, and provide data support for texture optimization. The key variable values required by the mathematical model are obtained through the simulation data. The friction coefficient of the texture under different working conditions was measured through friction and wear experiments, and the mathematical model was verified by the experimental results. The research results show that circular texture is suitable for low to medium speed and high load conditions, chevron texture is suitable for medium to high speed and medium to high load conditions, groove texture is suitable for high speed and low load conditions, and composite texture is suitable for high speed and medium to high load conditions. Comparing the experimental results with the results obtained by the mathematical model, it is found that the two are basically the same in the ranking of the anti-friction performance of different textures, and there is an error of 10%−40% in the friction coefficient value. In this study, a mathematical model of hydrodynamic lubrication was proposed, and the solution method of the optimal surface texture model was determined.
2022, 35: 38.
doi: 10.1186/s10033-022-00704-5
Abstract:
With the advent of the 5G era, the design of electronic equipment is developing towards thinness, intelligence and multi-function, which requires higher cooling performance of the equipment. Micro-channel heat sink is promising for the heat dissipation of super-thin electronic equipment. In this study, thermal resistance theoretical model of the micro-channel heat sink was first established. Then, fabrication process of the micro-channel heat sink was introduced. Subsequently, heat transfer performance of the fabricated micro-channel heat sink was tested through the developed testing platform. Results show that the developed micro-channel heat sink has more superior heat dissipation performance over conventional metal solid heat sink and it is well suited for high power LEDs application. Moreover, the micro-channel structures in the heat sink were optimized by orthogonal test. Based on the orthogonal optimization, heat dissipation performance of the micro-channel radiator was further improved.
With the advent of the 5G era, the design of electronic equipment is developing towards thinness, intelligence and multi-function, which requires higher cooling performance of the equipment. Micro-channel heat sink is promising for the heat dissipation of super-thin electronic equipment. In this study, thermal resistance theoretical model of the micro-channel heat sink was first established. Then, fabrication process of the micro-channel heat sink was introduced. Subsequently, heat transfer performance of the fabricated micro-channel heat sink was tested through the developed testing platform. Results show that the developed micro-channel heat sink has more superior heat dissipation performance over conventional metal solid heat sink and it is well suited for high power LEDs application. Moreover, the micro-channel structures in the heat sink were optimized by orthogonal test. Based on the orthogonal optimization, heat dissipation performance of the micro-channel radiator was further improved.
2022, 35: 39.
doi: 10.1186/s10033-022-00711-6
Abstract:
With the increasing demand to reduce emissions and save energy, hydraulic reservoirs require new architecture to optimize their weight, space, and volume. Conventional open reservoirs are large, heavy, and easily polluted, and threaten the operation of hydraulic systems. A closed reservoir provides the advantages of small volume and light weight, compared to open reservoirs. In this study, a non-metallic pressure reservoir with variable volume is designed and manufactured for closed-circuit hydraulic systems. The reservoir housing is made of rubber, and the Mooney-Rivlin model is chosen based on the rubber strain properties. The FEA simulation for the reservoir is performed using ANSYS Workbench to obtain the structural stiffness. The major contribution is the establishment of mathematical models for this reservoir, including the volume equation changing with height, flow equation, and force balance equation, to explore the output characteristics of this reservoir. Based on these results, simulation models were built to analyze the output characteristics of the reservoir. Moreover, the test rig of a conventional hydraulic system was transformed into a closed-circuit asymmetric hydraulic system for the reservoir, and preliminary verification experiments were conducted on it. The results demonstrate that the designed reservoir can absorb and discharge oil and supercharge pump inlet to benefit system operation. The changes in the volume and pressure with displacements under different volume ratios and frequencies were obtained, which verified the accuracy of the mathematical models. Owing to its lightweight design and small volume, the reservoir can replace conventional open reservoirs, and this lays a foundation for future theoretical research on this reservoir.
With the increasing demand to reduce emissions and save energy, hydraulic reservoirs require new architecture to optimize their weight, space, and volume. Conventional open reservoirs are large, heavy, and easily polluted, and threaten the operation of hydraulic systems. A closed reservoir provides the advantages of small volume and light weight, compared to open reservoirs. In this study, a non-metallic pressure reservoir with variable volume is designed and manufactured for closed-circuit hydraulic systems. The reservoir housing is made of rubber, and the Mooney-Rivlin model is chosen based on the rubber strain properties. The FEA simulation for the reservoir is performed using ANSYS Workbench to obtain the structural stiffness. The major contribution is the establishment of mathematical models for this reservoir, including the volume equation changing with height, flow equation, and force balance equation, to explore the output characteristics of this reservoir. Based on these results, simulation models were built to analyze the output characteristics of the reservoir. Moreover, the test rig of a conventional hydraulic system was transformed into a closed-circuit asymmetric hydraulic system for the reservoir, and preliminary verification experiments were conducted on it. The results demonstrate that the designed reservoir can absorb and discharge oil and supercharge pump inlet to benefit system operation. The changes in the volume and pressure with displacements under different volume ratios and frequencies were obtained, which verified the accuracy of the mathematical models. Owing to its lightweight design and small volume, the reservoir can replace conventional open reservoirs, and this lays a foundation for future theoretical research on this reservoir.
2022, 35: 44.
doi: 10.1186/s10033-022-00697-1
Abstract:
Currently, the measurement methods for pneumatic system leakage include bubbling, ultrasonic, and pressure detection methods. These methods are sensitive to high-precision sensors, long detection times, and stable external environments. The traditional differential pressure method involves severe differential pressure fluctuations caused by environmental pressure fluctuations or electromagnetic noise interference of sensors, leading to inaccurate detection. In this paper, a differential pressure fitting method for an asymmetric differential pressure cylinder is proposed. It overcomes the limitation of the detection efficiency caused by the asynchronous temperature recovery of the two chambers in the asymmetric differential pressure method and uses the differential pressure substitution equation to replace the differential calculation of the differential pressure. The improved differential pressure method proposes an innovation based on the detection principle and calculation method. Additionally, the influence of the parameters in the differential pressure substitution equation on the leakage calculation results was simulated, and the specific physical significance of the parameters of the differential pressure substitution equation was explained. The experiments verified the fitting effect and proved the accuracy of this method. Compared with the traditional differential pressure method, the maximum leakage deviation of inhibition was 0.5 L/min. Therefore, this method can be used to detect leaks in air tanks.
Currently, the measurement methods for pneumatic system leakage include bubbling, ultrasonic, and pressure detection methods. These methods are sensitive to high-precision sensors, long detection times, and stable external environments. The traditional differential pressure method involves severe differential pressure fluctuations caused by environmental pressure fluctuations or electromagnetic noise interference of sensors, leading to inaccurate detection. In this paper, a differential pressure fitting method for an asymmetric differential pressure cylinder is proposed. It overcomes the limitation of the detection efficiency caused by the asynchronous temperature recovery of the two chambers in the asymmetric differential pressure method and uses the differential pressure substitution equation to replace the differential calculation of the differential pressure. The improved differential pressure method proposes an innovation based on the detection principle and calculation method. Additionally, the influence of the parameters in the differential pressure substitution equation on the leakage calculation results was simulated, and the specific physical significance of the parameters of the differential pressure substitution equation was explained. The experiments verified the fitting effect and proved the accuracy of this method. Compared with the traditional differential pressure method, the maximum leakage deviation of inhibition was 0.5 L/min. Therefore, this method can be used to detect leaks in air tanks.
2022, 35: 45.
doi: 10.1186/s10033-022-00728-x
Abstract:
The performance and efficiency of a baler deteriorate as a result of gearbox failure. One way to overcome this challenge is to select appropriate fault feature parameters for fault diagnosis and monitoring gearboxes. This paper proposes a fault feature selection method using an improved adaptive genetic algorithm for a baler gearbox. This method directly obtains the minimum fault feature parameter set that is most sensitive to fault features through attribute reduction. The main benefit of the improved adaptive genetic algorithm is its excellent performance in terms of the efficiency of attribute reduction without requiring prior information. Therefore, this method should be capable of timely diagnosis and monitoring. Experimental validation was performed and promising findings highlighting the relationship between diagnosis results and faults were obtained. The results indicate that when using the improved genetic algorithm to reduce 12 fault characteristic parameters to three without a priori information, 100% fault diagnosis accuracy can be achieved based on these fault characteristics and the time required for fault feature parameter selection using the improved genetic algorithm is reduced by half compared to traditional methods. The proposed method provides important insights into the instant fault diagnosis and fault monitoring of mechanical devices.
The performance and efficiency of a baler deteriorate as a result of gearbox failure. One way to overcome this challenge is to select appropriate fault feature parameters for fault diagnosis and monitoring gearboxes. This paper proposes a fault feature selection method using an improved adaptive genetic algorithm for a baler gearbox. This method directly obtains the minimum fault feature parameter set that is most sensitive to fault features through attribute reduction. The main benefit of the improved adaptive genetic algorithm is its excellent performance in terms of the efficiency of attribute reduction without requiring prior information. Therefore, this method should be capable of timely diagnosis and monitoring. Experimental validation was performed and promising findings highlighting the relationship between diagnosis results and faults were obtained. The results indicate that when using the improved genetic algorithm to reduce 12 fault characteristic parameters to three without a priori information, 100% fault diagnosis accuracy can be achieved based on these fault characteristics and the time required for fault feature parameter selection using the improved genetic algorithm is reduced by half compared to traditional methods. The proposed method provides important insights into the instant fault diagnosis and fault monitoring of mechanical devices.
2022, 35: 48.
doi: 10.1186/s10033-022-00712-5
Abstract:
A comparative study on the influence of different manufacturing methods (selective laser melting and hot rolling) on the microstructure, mechanical and thermal behaviours of tungsten (W) was presented for the first time. The results indicated that the selective laser melting (SLM) W exhibited a finer grain sizes, a lower strength ductility, hardness and thermal conductivity compared to hot-rolled W. The main reason for this result was that the laser underwent rapid heating and cooling when it was used to melt W powder with high energy density, resulting in large internal stress in the sample after manufacturing. Subsequently, the internal stress was released, leading to the generation of micro-cracks at the grain boundaries, thereby affecting the performance of SLM W samples. In addition, the higher fraction of high-angle grain boundaries (HAGBs) of SLM W was found to be the key factor for intrinsic brittleness. Because the HAGBs are the preferred crack paths, which could promote crack propagation and decrease fracture energy.
A comparative study on the influence of different manufacturing methods (selective laser melting and hot rolling) on the microstructure, mechanical and thermal behaviours of tungsten (W) was presented for the first time. The results indicated that the selective laser melting (SLM) W exhibited a finer grain sizes, a lower strength ductility, hardness and thermal conductivity compared to hot-rolled W. The main reason for this result was that the laser underwent rapid heating and cooling when it was used to melt W powder with high energy density, resulting in large internal stress in the sample after manufacturing. Subsequently, the internal stress was released, leading to the generation of micro-cracks at the grain boundaries, thereby affecting the performance of SLM W samples. In addition, the higher fraction of high-angle grain boundaries (HAGBs) of SLM W was found to be the key factor for intrinsic brittleness. Because the HAGBs are the preferred crack paths, which could promote crack propagation and decrease fracture energy.
2022, 35: 49.
doi: 10.1186/s10033-022-00727-y
Abstract:
Cavitation inside a torque converter induces noise, vibration and even failure, and these effects have been disregarded in previous torque converter design processes. However, modern torque converter applications require attention to this issue because of its high-speed and high-capacity requirements. Therefore, this study investigated the cavitation effect on a torque converter using both numerical and experimental methods with an emphasis on the influence of the charging oil feed location and charge pressure. Computational fluid dynamics (CFD) models were established to simulate the transient cavitation behaviour in the torque converter using different charging oil pressures and inlet arrangements and testing against a base case to validate the results. The CFD results suggested that cavitating bubbles mainly takes place in the stator of the torque converter. The transient cavitation CFD model yielded good agreement with the experimental data, with an error of 7.6% in the capacity constant and 7.4% in the torque ratio. Both the experimental and numerical studies showed that cavitation induced severe capacity degradation, and that the charge pressure and charging oil configuration significantly affects both the overall hydrodynamic performance and the fluid behaviour inside the torque converter because of cavitation. Increasing the charge pressure and charging the oil from the turbine-stator clearance were found to suppress cavitation development and reduce performance degradation, especially in terms of the capacity constant. This study revealed the fluid field mechanism behind the influence of charging oil conditions on torque converter cavitation behaviour, providing practical guidelines for suppressing cavitation in torque converter.
Cavitation inside a torque converter induces noise, vibration and even failure, and these effects have been disregarded in previous torque converter design processes. However, modern torque converter applications require attention to this issue because of its high-speed and high-capacity requirements. Therefore, this study investigated the cavitation effect on a torque converter using both numerical and experimental methods with an emphasis on the influence of the charging oil feed location and charge pressure. Computational fluid dynamics (CFD) models were established to simulate the transient cavitation behaviour in the torque converter using different charging oil pressures and inlet arrangements and testing against a base case to validate the results. The CFD results suggested that cavitating bubbles mainly takes place in the stator of the torque converter. The transient cavitation CFD model yielded good agreement with the experimental data, with an error of 7.6% in the capacity constant and 7.4% in the torque ratio. Both the experimental and numerical studies showed that cavitation induced severe capacity degradation, and that the charge pressure and charging oil configuration significantly affects both the overall hydrodynamic performance and the fluid behaviour inside the torque converter because of cavitation. Increasing the charge pressure and charging the oil from the turbine-stator clearance were found to suppress cavitation development and reduce performance degradation, especially in terms of the capacity constant. This study revealed the fluid field mechanism behind the influence of charging oil conditions on torque converter cavitation behaviour, providing practical guidelines for suppressing cavitation in torque converter.
2022, 35: 50.
doi: 10.1186/s10033-022-00721-4
Abstract:
The current research on the evaporation of ferrofluids mainly focuses on the characterization of ultra-low vapor pressure ferrofluids in vacuum and the theoretical analysis of the evaporation process. Few studies have focused on the experimental validation of the proposed evaporation rate equations and on the comparison of the differences in ferrofluid evaporation. In this study, based on the Bolotov's model, an evaporation rate equation is deduced from the experimental model. The experimental study included a comparison of the evaporation, magnetic particle volume fraction, temperature, height of the fluid surface from the outlet, and magnetic field of a kerosene-based ferrofluid and its base carrier liquid. The prepared sample was evaporated in a test tube, and the evaporation rate was calculated by measuring the weight loss of the sample. The experimental results show that the evaporation rate of the base carrier liquid is higher than that of the ferrofluid. The smaller the volume fraction of the magnetic particles, the greater the evaporation rate. The magnetic particles play a key role in preventing evaporation of the base liquid. The higher the temperature, the smaller the deviation of the evaporation rate from the predicted value. The evaporation rates obtained by the two control groups at the height of the fluid surface from the outlet were lower than the predict value. The magnetic field had a certain promotional effect on the evaporation of the ferrofluid. The experimental results were consistent with the results obtained using Bolotov's model. This research validates Bolotov's model and shows that the model is somewhat biased but still responds well to different variables.
The current research on the evaporation of ferrofluids mainly focuses on the characterization of ultra-low vapor pressure ferrofluids in vacuum and the theoretical analysis of the evaporation process. Few studies have focused on the experimental validation of the proposed evaporation rate equations and on the comparison of the differences in ferrofluid evaporation. In this study, based on the Bolotov's model, an evaporation rate equation is deduced from the experimental model. The experimental study included a comparison of the evaporation, magnetic particle volume fraction, temperature, height of the fluid surface from the outlet, and magnetic field of a kerosene-based ferrofluid and its base carrier liquid. The prepared sample was evaporated in a test tube, and the evaporation rate was calculated by measuring the weight loss of the sample. The experimental results show that the evaporation rate of the base carrier liquid is higher than that of the ferrofluid. The smaller the volume fraction of the magnetic particles, the greater the evaporation rate. The magnetic particles play a key role in preventing evaporation of the base liquid. The higher the temperature, the smaller the deviation of the evaporation rate from the predicted value. The evaporation rates obtained by the two control groups at the height of the fluid surface from the outlet were lower than the predict value. The magnetic field had a certain promotional effect on the evaporation of the ferrofluid. The experimental results were consistent with the results obtained using Bolotov's model. This research validates Bolotov's model and shows that the model is somewhat biased but still responds well to different variables.
2022, 35: 51.
doi: 10.1186/s10033-022-00713-4
Abstract:
High-pressure pulsed water jet technology has considerable development potential in the field of rock fragmentation. To overcome the shortcomings of existing pulsed jets, a self-supercharging pulsed water jet (SSPWJ) generation method is proposed, which is based on the theory of the pulsed water jet and the principle of hydraulic boosting. The proposed method changes the flow direction of the fluid medium through the valve core to make the piston reciprocate in the cylinder and relies on the effective area difference between the front and rear chambers in the stroke stage of the piston to realize the organic combination of "pulse" and "supercharging" of the jet, thus forming an SSPWJ. On the basis of the formation principle of the SSPWJ, a SSPWJ testing platform was constructed, and tests were performed on the jet pressure acquisition, morphology capture, and granite erosion. Both the jet pressure and the jet morphology exhibited periodic changes, and a higher pulse pressure was obtained at lower inlet pressure. The error of the pressure ratio calculated according to the experimental results was < 3% relative to the theoretical design value, confirming the feasibility of the method. The pulse pressure and pulse frequency are controllable; that is, as the inlet flow rate increases in the stroke stage of the piston, the pulse pressure and pulse frequency increase, and the pulse duration decreases. As the inlet flow rate increases in the backward-stroke stage of the piston, the pulse frequency increases, and the pulse pressure and pulse duration remain unchanged. Under the combined action of the water-hammer pressure, high-speed lateral flow, and high-frequency dynamic load of the SSPWJ, local flaky exfoliation was observed when the granite surface was eroded. The results of this study lay the foundation for enriching the theory of pulsed jet generation and expanding its application range.
High-pressure pulsed water jet technology has considerable development potential in the field of rock fragmentation. To overcome the shortcomings of existing pulsed jets, a self-supercharging pulsed water jet (SSPWJ) generation method is proposed, which is based on the theory of the pulsed water jet and the principle of hydraulic boosting. The proposed method changes the flow direction of the fluid medium through the valve core to make the piston reciprocate in the cylinder and relies on the effective area difference between the front and rear chambers in the stroke stage of the piston to realize the organic combination of "pulse" and "supercharging" of the jet, thus forming an SSPWJ. On the basis of the formation principle of the SSPWJ, a SSPWJ testing platform was constructed, and tests were performed on the jet pressure acquisition, morphology capture, and granite erosion. Both the jet pressure and the jet morphology exhibited periodic changes, and a higher pulse pressure was obtained at lower inlet pressure. The error of the pressure ratio calculated according to the experimental results was < 3% relative to the theoretical design value, confirming the feasibility of the method. The pulse pressure and pulse frequency are controllable; that is, as the inlet flow rate increases in the stroke stage of the piston, the pulse pressure and pulse frequency increase, and the pulse duration decreases. As the inlet flow rate increases in the backward-stroke stage of the piston, the pulse frequency increases, and the pulse pressure and pulse duration remain unchanged. Under the combined action of the water-hammer pressure, high-speed lateral flow, and high-frequency dynamic load of the SSPWJ, local flaky exfoliation was observed when the granite surface was eroded. The results of this study lay the foundation for enriching the theory of pulsed jet generation and expanding its application range.
2022, 35: 57.
doi: 10.1186/s10033-022-00736-x
Abstract:
The product functional configuration (PFC) is typically used by firms to satisfy the individual requirements of customers and is realized based on market analysis. This study aims to help firms analyze functions and realize functional configurations using patent data. This study first proposes a patent-data-driven PFC method based on a hypergraph network. It then constructs a weighted network model to optimize the combination of product function quantity and object from the perspective of big data, as follows: (1) The functional knowledge contained in the patent is extracted. (2) The functional hypergraph is constructed based on the co-occurrence relationship between patents and applicants. (3) The function and patent weight are calculated from the patent applicant's perspective and patent value. (4) A weight calculation model of the PFC is developed. (5) The weighted frequent subgraph algorithm is used to obtain the optimal function combination list. This method is applied to an innovative design process of a bathroom shower. The results indicate that this method can help firms detach optimal function candidates and develop a multifunctional product.
The product functional configuration (PFC) is typically used by firms to satisfy the individual requirements of customers and is realized based on market analysis. This study aims to help firms analyze functions and realize functional configurations using patent data. This study first proposes a patent-data-driven PFC method based on a hypergraph network. It then constructs a weighted network model to optimize the combination of product function quantity and object from the perspective of big data, as follows: (1) The functional knowledge contained in the patent is extracted. (2) The functional hypergraph is constructed based on the co-occurrence relationship between patents and applicants. (3) The function and patent weight are calculated from the patent applicant's perspective and patent value. (4) A weight calculation model of the PFC is developed. (5) The weighted frequent subgraph algorithm is used to obtain the optimal function combination list. This method is applied to an innovative design process of a bathroom shower. The results indicate that this method can help firms detach optimal function candidates and develop a multifunctional product.
2022, 35: 58.
doi: 10.1186/s10033-022-00738-9
Abstract:
Traditional metallic materials usually face a dilemma between high strength and poor strain hardening capacity. However, heterogeneous structured metallic materials have been found to obviously overcome the trade-off. Herein, gradient lamellar structure was fabricated through ultrasound-aided deep rolling technique in pure Ni with high stacking fault energy after heat treatment. The gradient lamellar Ni was successively divided into the four regions. In-situ micropillar compression tests were conducted in different regions to reveal the corresponding microscopic mechanical properties. Microscopic characterization techniques were performed to explore underlying deformation mechanisms and the effects of microstructural parameters on deformation behaviors. This work demonstrates that the micropillar with near nanoscale lamellar thickness possesses excellent strength and plasticity. On one hand, the reason for high strength of near nanoscale micropillar is that the strength of micropillar increases with the decrease of lamellar thickness according to the Hall-Petch effect. On the other hand, numerous lamellar grain boundaries perpendicular to the loading direction is found to hinder the motion of slip bands, resulting in great strain hardening capacity in the near nanoscale lamellar micropillar.
Traditional metallic materials usually face a dilemma between high strength and poor strain hardening capacity. However, heterogeneous structured metallic materials have been found to obviously overcome the trade-off. Herein, gradient lamellar structure was fabricated through ultrasound-aided deep rolling technique in pure Ni with high stacking fault energy after heat treatment. The gradient lamellar Ni was successively divided into the four regions. In-situ micropillar compression tests were conducted in different regions to reveal the corresponding microscopic mechanical properties. Microscopic characterization techniques were performed to explore underlying deformation mechanisms and the effects of microstructural parameters on deformation behaviors. This work demonstrates that the micropillar with near nanoscale lamellar thickness possesses excellent strength and plasticity. On one hand, the reason for high strength of near nanoscale micropillar is that the strength of micropillar increases with the decrease of lamellar thickness according to the Hall-Petch effect. On the other hand, numerous lamellar grain boundaries perpendicular to the loading direction is found to hinder the motion of slip bands, resulting in great strain hardening capacity in the near nanoscale lamellar micropillar.
2022, 35: 62.
doi: 10.1186/s10033-022-00709-0
Abstract:
To improve the quality and efficiency of Z-directional 3D preform forming, the Z-yarn frictional force distribution model of the preform and its wear mechanism were investigated. In this study, a tensile force measuring device was designed to measure the force required to replace the guide sleeve, which is equivalent to the Z-yarn frictional forces. The frictional force is proportional to the number of preform layers and is applied to the preform decreased from the corner, edge, sub-edge, and middle in order. A back propagation neural network model was established to predict the friction at different positions of the preform with different layers, and the error was within 1.9%. The wear of Z-yarn was studied at different frictional positions and after different times of successive implantation into the preform. The results showed that with an increase in the number of Z-yarn implantations and frictional forces, the amount of carbon fiber bundle hairiness gradually increased, and the tensile fracture strength damage of the fiber was increasingly affected by the frictional forces. In the corner position of the preform, when the number of implantations was 25, the fiber fracture strength decreased non-linearly and substantially; in order to avoid fiber fracturing in the implantation process, the Z-yarn needs to be replaced in time after 20–25 cycles of continuous implantation. This study solves the problem of difficulty in measuring the force required for individual replacements owing to the excessive number of guide sleeves, puts forward the relationship between fiber wear, preform position, and implantation times, solves the phenomenon of fracture in the preform during Z-direction fiber implantation, and realizes the continuous implantation of fibers.
To improve the quality and efficiency of Z-directional 3D preform forming, the Z-yarn frictional force distribution model of the preform and its wear mechanism were investigated. In this study, a tensile force measuring device was designed to measure the force required to replace the guide sleeve, which is equivalent to the Z-yarn frictional forces. The frictional force is proportional to the number of preform layers and is applied to the preform decreased from the corner, edge, sub-edge, and middle in order. A back propagation neural network model was established to predict the friction at different positions of the preform with different layers, and the error was within 1.9%. The wear of Z-yarn was studied at different frictional positions and after different times of successive implantation into the preform. The results showed that with an increase in the number of Z-yarn implantations and frictional forces, the amount of carbon fiber bundle hairiness gradually increased, and the tensile fracture strength damage of the fiber was increasingly affected by the frictional forces. In the corner position of the preform, when the number of implantations was 25, the fiber fracture strength decreased non-linearly and substantially; in order to avoid fiber fracturing in the implantation process, the Z-yarn needs to be replaced in time after 20–25 cycles of continuous implantation. This study solves the problem of difficulty in measuring the force required for individual replacements owing to the excessive number of guide sleeves, puts forward the relationship between fiber wear, preform position, and implantation times, solves the phenomenon of fracture in the preform during Z-direction fiber implantation, and realizes the continuous implantation of fibers.
2022, 35: 66.
doi: 10.1186/s10033-022-00737-w
Abstract:
As a type of hydraulic rotary actuator, a helical hydraulic rotary actuator exhibits a large angle, high torque, and compact structure; hence, it has been widely used in various fields. However, its core technology is proprietary to several companies and thus has not been disclosed. Furthermore, the relevant reports are primarily limited to the component level. The dynamic characteristics of the output when a helical rotary actuator is applied to a closed-loop system are investigated from the perspective of driving system design. Two main aspects are considered: one is to establish a reliable mathematical model and the other is to consider the effect of system parameter perturbation on the output. In this study, a detailed mechanical analysis of a helical rotary hydraulic cylinder is first performed, factors such as friction and load are considered, and an accurate dynamic model of the actuator is established. Subsequently, considering the nonlinear characteristics of pressure flow and the dynamic characteristics of the valve, a dynamic model of a valve-controlled helical rotary actuator angle closed-loop system is described based on sixth-order nonlinear state equations, which has never been reported previously. After deriving the system model, a sensitivity analysis of 23 main parameters in the model with a perturbation of 10% is performed under nine operating conditions. Finally, the system dynamics model and sensitivity analysis results are verified via a prototype experiment and co-simulation, which demonstrate the reliability of the theoretical results obtained in this study. The results provide an accurate mathematical model and analysis basis for the structural optimization or control compensation of similar systems.
As a type of hydraulic rotary actuator, a helical hydraulic rotary actuator exhibits a large angle, high torque, and compact structure; hence, it has been widely used in various fields. However, its core technology is proprietary to several companies and thus has not been disclosed. Furthermore, the relevant reports are primarily limited to the component level. The dynamic characteristics of the output when a helical rotary actuator is applied to a closed-loop system are investigated from the perspective of driving system design. Two main aspects are considered: one is to establish a reliable mathematical model and the other is to consider the effect of system parameter perturbation on the output. In this study, a detailed mechanical analysis of a helical rotary hydraulic cylinder is first performed, factors such as friction and load are considered, and an accurate dynamic model of the actuator is established. Subsequently, considering the nonlinear characteristics of pressure flow and the dynamic characteristics of the valve, a dynamic model of a valve-controlled helical rotary actuator angle closed-loop system is described based on sixth-order nonlinear state equations, which has never been reported previously. After deriving the system model, a sensitivity analysis of 23 main parameters in the model with a perturbation of 10% is performed under nine operating conditions. Finally, the system dynamics model and sensitivity analysis results are verified via a prototype experiment and co-simulation, which demonstrate the reliability of the theoretical results obtained in this study. The results provide an accurate mathematical model and analysis basis for the structural optimization or control compensation of similar systems.
2022, 35: 68.
doi: 10.1186/s10033-022-00751-y
Abstract:
With the increasing demand for high-precision optical components, bonnet polishing technology is increasingly being used in the polishing process of optical components owing to its high removal efficiency and high surface accuracy. However, it is expensive and difficult to implement dedicated bonnet polishing machine tools, and their processing range is limited. This research combines bonnet polishing technology with industrial robot-assisted processing technology to propose a robotic bonnet polishing control model for large-diameter axisymmetric aspherical optical components. Using the transformation relations of the spatial coordinate system, the transformation relations of the workpiece coordinate system, local coordinate system of the polishing point, and tool coordinate system of the bonnet sphere center are established to obtain the bonnet precession polishing motion model. The polishing trajectory of large-diameter axisymmetric aspherical components and the variation in the linkage angle difference were simulated by adding an efficiency-optimal control strategy to the motion model. The robot motion was simulated in Robostudio to verify the correctness of the precession motion model and control algorithm. Lastly, the robotic bonnet polishing system was successfully applied to the polishing process of the optical components.
With the increasing demand for high-precision optical components, bonnet polishing technology is increasingly being used in the polishing process of optical components owing to its high removal efficiency and high surface accuracy. However, it is expensive and difficult to implement dedicated bonnet polishing machine tools, and their processing range is limited. This research combines bonnet polishing technology with industrial robot-assisted processing technology to propose a robotic bonnet polishing control model for large-diameter axisymmetric aspherical optical components. Using the transformation relations of the spatial coordinate system, the transformation relations of the workpiece coordinate system, local coordinate system of the polishing point, and tool coordinate system of the bonnet sphere center are established to obtain the bonnet precession polishing motion model. The polishing trajectory of large-diameter axisymmetric aspherical components and the variation in the linkage angle difference were simulated by adding an efficiency-optimal control strategy to the motion model. The robot motion was simulated in Robostudio to verify the correctness of the precession motion model and control algorithm. Lastly, the robotic bonnet polishing system was successfully applied to the polishing process of the optical components.
2022, 35: 69.
doi: 10.1186/s10033-022-00754-9
Abstract:
Traditional atomization devices always exhibit many drawbacks, such as non-uniform atomization particle sizes, instability of transient atomization quantity and uncontrollability of precise energy, which seriously restrict further practical application of atomization inhalation therapy. The formation and separation process of droplets belongs to a microphenomenon of atomization. The investigation of the droplet formation and separation process will be favorable for understanding the atomization mechanism. In present work, the Conservative Level Set Method (CLSM) is successfully applied on the simulation of the formation and separation of droplets in a medical piezoelectric atomization device induced by intra-hole fluctuation. The intra-hole fluctuation mechanism is systematically explored and analyzed, and also the expression of the volume change in the micro cone hole is built and evaluated. Both the control equation and simulation model of droplet formation and separation process have been well established by meshing the simulation model, and thereby the process of droplet formation and separation is simulated. The corresponding results demonstrate that the breaking time of droplets is decreased with the inlet velocity and liquid temperature rising, while enhanced with the liquid concentration increasing. Meanwhile, the volume of droplet is decreased with the inlet velocity and liquid concentration increasing, but increased with the liquid temperature rising. The velocity of droplet is enhanced with the inlet velocity and liquid temperature rising, and reduced with the increase of liquid concentration. When the large side diameter of micro-cone hole is set as 79 μm, the breaking time of the droplet reaches a minimum value of 38.7 μs, whereas the volume and the velocity of droplet reach a maximum value of 79.8 pL and 4.46 m/s, respectively. This study provides theoretical guidance for the design of medical piezoelectric atomization devices and contributes to the promotion of inhalation therapy in practical use.
Traditional atomization devices always exhibit many drawbacks, such as non-uniform atomization particle sizes, instability of transient atomization quantity and uncontrollability of precise energy, which seriously restrict further practical application of atomization inhalation therapy. The formation and separation process of droplets belongs to a microphenomenon of atomization. The investigation of the droplet formation and separation process will be favorable for understanding the atomization mechanism. In present work, the Conservative Level Set Method (CLSM) is successfully applied on the simulation of the formation and separation of droplets in a medical piezoelectric atomization device induced by intra-hole fluctuation. The intra-hole fluctuation mechanism is systematically explored and analyzed, and also the expression of the volume change in the micro cone hole is built and evaluated. Both the control equation and simulation model of droplet formation and separation process have been well established by meshing the simulation model, and thereby the process of droplet formation and separation is simulated. The corresponding results demonstrate that the breaking time of droplets is decreased with the inlet velocity and liquid temperature rising, while enhanced with the liquid concentration increasing. Meanwhile, the volume of droplet is decreased with the inlet velocity and liquid concentration increasing, but increased with the liquid temperature rising. The velocity of droplet is enhanced with the inlet velocity and liquid temperature rising, and reduced with the increase of liquid concentration. When the large side diameter of micro-cone hole is set as 79 μm, the breaking time of the droplet reaches a minimum value of 38.7 μs, whereas the volume and the velocity of droplet reach a maximum value of 79.8 pL and 4.46 m/s, respectively. This study provides theoretical guidance for the design of medical piezoelectric atomization devices and contributes to the promotion of inhalation therapy in practical use.
2022, 35: 70.
doi: 10.1186/s10033-022-00724-1
Abstract:
The rotating parts looseness is one of the common failures in rotating machinery. The current researches of looseness fault mainly focus on non-rotating components. However, the looseness fault of disc-shaft system, which is the main work part in the rotor system, is almost ignored. Here, a dynamic model of the rotor system with loose disc caused by the insufficient interference force is proposed based on the contact model of disc-shaft system with the microscopic surface topography, the vibration characteristics of the system are analyzed and discussed by the number simulation, and verified by the experiment. The results show that the speed of the shaft, the contact stiffness, the clearance between the disc and shaft, the damping of the disc and the rotational damping have an influence on the rotation state of the disc. When the rotation speed of the disc and the shaft are same, the collision frequency is mainly composed of one frequency multiplication component and very weak high frequency multiplication components. When the rotation speed of the disc and the shaft is close, the vibration of the disc occurs a beat vibration phenomenon in the horizontal direction. Simultaneously, a periodical similar beat vibration phenomenon also occurs in the waveform of the disc-shaft displacement difference. The collision frequency is mainly composed of a low frequency and a weak high frequency component. When the rotation speed of the disc and the shaft has great difference, the collision frequency is mainly composed of one frequency multiplication, a few weak high frequency multiplication components and a few low frequency multiplication component. With the reduction of the relative speed of the disc, the trajectory of the disc changes from circle-shape to inner eight-shape, and then to circle-shape. In the inner eight-shape, the inner ring first gradually becomes smaller and then gradually becomes larger, and the outer ring is still getting smaller. The obtained research results in this paper has important theoretical value for the diagnosis of the rotor system with the loose disc.
The rotating parts looseness is one of the common failures in rotating machinery. The current researches of looseness fault mainly focus on non-rotating components. However, the looseness fault of disc-shaft system, which is the main work part in the rotor system, is almost ignored. Here, a dynamic model of the rotor system with loose disc caused by the insufficient interference force is proposed based on the contact model of disc-shaft system with the microscopic surface topography, the vibration characteristics of the system are analyzed and discussed by the number simulation, and verified by the experiment. The results show that the speed of the shaft, the contact stiffness, the clearance between the disc and shaft, the damping of the disc and the rotational damping have an influence on the rotation state of the disc. When the rotation speed of the disc and the shaft are same, the collision frequency is mainly composed of one frequency multiplication component and very weak high frequency multiplication components. When the rotation speed of the disc and the shaft is close, the vibration of the disc occurs a beat vibration phenomenon in the horizontal direction. Simultaneously, a periodical similar beat vibration phenomenon also occurs in the waveform of the disc-shaft displacement difference. The collision frequency is mainly composed of a low frequency and a weak high frequency component. When the rotation speed of the disc and the shaft has great difference, the collision frequency is mainly composed of one frequency multiplication, a few weak high frequency multiplication components and a few low frequency multiplication component. With the reduction of the relative speed of the disc, the trajectory of the disc changes from circle-shape to inner eight-shape, and then to circle-shape. In the inner eight-shape, the inner ring first gradually becomes smaller and then gradually becomes larger, and the outer ring is still getting smaller. The obtained research results in this paper has important theoretical value for the diagnosis of the rotor system with the loose disc.
Characteristics of Oscillation in Cavity of Helmholtz Nozzle Generating Self-excited Pulsed Waterjet
2022, 35: 73.
doi: 10.1186/s10033-022-00714-3
Abstract:
Cavity flow oscillations in the axisymmetric cavity are critical to the operating efficiency of self-excited pulsed waterjets, which are widely employed in many practical applications. In this study, the behaviors of a turbulent flow in axisymmetric cavities causing cavity flow oscillations are investigated based on wall pressure characteristics. Experiments are performed using four Helmholtz nozzles with varying length-to-radius ratios at flow velocities of 20–80 m/s. Three orders of hydrodynamic modes in axisymmetric cavity are obtained through the spectral analysis of wall pressure. Based on the experimental results, the empirical coefficient of Rossiter's formula is modified, and the values of the parameter phase lag and the ratio of convection velocity to free stream velocity are obtained as 0.061 and 0.511, respectively. In addition, the spectral peak with a relatively constant frequency shows that the flow-acoustic resonance is excited significantly. A modified model is introduced based on the fluidic networks to predict the lock-on frequency. The results obtained can provide a basis for the structural optimization of the nozzle to improve the performance of self-excited pulsed waterjets.
Cavity flow oscillations in the axisymmetric cavity are critical to the operating efficiency of self-excited pulsed waterjets, which are widely employed in many practical applications. In this study, the behaviors of a turbulent flow in axisymmetric cavities causing cavity flow oscillations are investigated based on wall pressure characteristics. Experiments are performed using four Helmholtz nozzles with varying length-to-radius ratios at flow velocities of 20–80 m/s. Three orders of hydrodynamic modes in axisymmetric cavity are obtained through the spectral analysis of wall pressure. Based on the experimental results, the empirical coefficient of Rossiter's formula is modified, and the values of the parameter phase lag and the ratio of convection velocity to free stream velocity are obtained as 0.061 and 0.511, respectively. In addition, the spectral peak with a relatively constant frequency shows that the flow-acoustic resonance is excited significantly. A modified model is introduced based on the fluidic networks to predict the lock-on frequency. The results obtained can provide a basis for the structural optimization of the nozzle to improve the performance of self-excited pulsed waterjets.
2022, 35: 74.
doi: 10.1186/s10033-022-00710-7
Abstract:
The acoustic propagation characteristics of axisymmetric waves have been widely used in leak detection of fluid-filled pipes. The related acoustic methods and equipment are gradually coming to the market, but their theoretical research obviously lags behind the field practice, which seriously restricts the breakthrough and innovation of this technology. Based on the fully three-dimensional effect of the surrounding medium, a coupled motion equation of axisymmetric wave of buried liquid-filled pipes is derived in detail, a contact coefficient is used to express the coupling strength between surrounding medium and pipe, then, a general equation of motion was derived which contain the pipe soil lubrication contact, pipe soil compact contact and pipe in water and air. Finally, the corresponding numerical calculation model is established and solved used numerical method. The shear effects of the surrounding medium and the shear effects at the interface between surrounding medium and pipe are discussed in detail. The output indicates that the surrounding medium is to add mass to the pipe wall, but the shear effect is to add stiffness. With the consideration of the contact strength between the pipe and the medium, the additional mass and the pipe wall will resonate at a specific frequency, resulting in a significant increase in the radiation wave to the surrounding medium. The research contents have great guiding effect on the theory of acoustic wave propagation and the engineering application of leak detection technology in the buried pipe.
The acoustic propagation characteristics of axisymmetric waves have been widely used in leak detection of fluid-filled pipes. The related acoustic methods and equipment are gradually coming to the market, but their theoretical research obviously lags behind the field practice, which seriously restricts the breakthrough and innovation of this technology. Based on the fully three-dimensional effect of the surrounding medium, a coupled motion equation of axisymmetric wave of buried liquid-filled pipes is derived in detail, a contact coefficient is used to express the coupling strength between surrounding medium and pipe, then, a general equation of motion was derived which contain the pipe soil lubrication contact, pipe soil compact contact and pipe in water and air. Finally, the corresponding numerical calculation model is established and solved used numerical method. The shear effects of the surrounding medium and the shear effects at the interface between surrounding medium and pipe are discussed in detail. The output indicates that the surrounding medium is to add mass to the pipe wall, but the shear effect is to add stiffness. With the consideration of the contact strength between the pipe and the medium, the additional mass and the pipe wall will resonate at a specific frequency, resulting in a significant increase in the radiation wave to the surrounding medium. The research contents have great guiding effect on the theory of acoustic wave propagation and the engineering application of leak detection technology in the buried pipe.
2022, 35: 75.
doi: 10.1186/s10033-022-00756-7
Abstract:
The inverse problem analysis method provides an effective way for the structural parameter identification. However, uncertainties wildly exist in the practical engineering inverse problems. Due to the coupling of multi-source uncertainties in the measured responses and the modeling parameters, the traditional inverse method under the deterministic framework faces the challenges in solving mechanism and computing cost. In this paper, an uncertain inverse method based on convex model and dimension reduction decomposition is proposed to realize the interval identification of unknown structural parameters according to the uncertain measured responses and modeling parameters. Firstly, the polygonal convex set model is established to quantify the epistemic uncertainties of modeling parameters. Afterwards, a space collocation method based on dimension reduction decomposition is proposed to transform the inverse problem considering multi-source uncertainties into a few interval inverse problems considering response uncertainty. The transformed interval inverse problem involves the two-layer solving process including interval propagation and optimization updating. In order to solve the interval inverse problems considering response uncertainty, an efficient interval inverse method based on the high dimensional model representation and affine algorithm is further developed. Through the coupling of the above two strategies, the proposed uncertain inverse method avoids the time-consuming multi-layer nested calculation procedure, and then effectively realizes the uncertainty identification of unknown structural parameters. Finally, two engineering examples are provided to verify the effectiveness of the proposed uncertain inverse method.
The inverse problem analysis method provides an effective way for the structural parameter identification. However, uncertainties wildly exist in the practical engineering inverse problems. Due to the coupling of multi-source uncertainties in the measured responses and the modeling parameters, the traditional inverse method under the deterministic framework faces the challenges in solving mechanism and computing cost. In this paper, an uncertain inverse method based on convex model and dimension reduction decomposition is proposed to realize the interval identification of unknown structural parameters according to the uncertain measured responses and modeling parameters. Firstly, the polygonal convex set model is established to quantify the epistemic uncertainties of modeling parameters. Afterwards, a space collocation method based on dimension reduction decomposition is proposed to transform the inverse problem considering multi-source uncertainties into a few interval inverse problems considering response uncertainty. The transformed interval inverse problem involves the two-layer solving process including interval propagation and optimization updating. In order to solve the interval inverse problems considering response uncertainty, an efficient interval inverse method based on the high dimensional model representation and affine algorithm is further developed. Through the coupling of the above two strategies, the proposed uncertain inverse method avoids the time-consuming multi-layer nested calculation procedure, and then effectively realizes the uncertainty identification of unknown structural parameters. Finally, two engineering examples are provided to verify the effectiveness of the proposed uncertain inverse method.
2022, 35: 77.
doi: 10.1186/s10033-022-00742-z
Abstract:
Multifidelity surrogates (MFSs) replace computationally intensive models by synergistically combining information from different fidelity data with a significant improvement in modeling efficiency. In this paper, a modified MFS (MMFS) model based on a radial basis function (RBF) is proposed, in which two fidelities of information can be analyzed by adaptively obtaining the scale factor. In the MMFS, an RBF was employed to establish the low-fidelity model. The correlation matrix of the high-fidelity samples and corresponding low-fidelity responses were integrated into an expansion matrix to determine the scaling function parameters. The shape parameters of the basis function were optimized by minimizing the leave-one-out cross-validation error of the high-fidelity sample points. The performance of the MMFS was compared with those of other MFS models (MFS-RBF and cooperative RBF) and single-fidelity RBF using four benchmark test functions, by which the impacts of different high-fidelity sample sizes on the prediction accuracy were also analyzed. The sensitivity of the MMFS model to the randomness of the design of experiments (DoE) was investigated by repeating sampling plans with 20 different DoEs. Stress analysis of the steel plate is presented to highlight the prediction ability of the proposed MMFS model. This research proposes a new multifidelity modeling method that can fully use two fidelity sample sets, rapidly calculate model parameters, and exhibit good prediction accuracy and robustness.
Multifidelity surrogates (MFSs) replace computationally intensive models by synergistically combining information from different fidelity data with a significant improvement in modeling efficiency. In this paper, a modified MFS (MMFS) model based on a radial basis function (RBF) is proposed, in which two fidelities of information can be analyzed by adaptively obtaining the scale factor. In the MMFS, an RBF was employed to establish the low-fidelity model. The correlation matrix of the high-fidelity samples and corresponding low-fidelity responses were integrated into an expansion matrix to determine the scaling function parameters. The shape parameters of the basis function were optimized by minimizing the leave-one-out cross-validation error of the high-fidelity sample points. The performance of the MMFS was compared with those of other MFS models (MFS-RBF and cooperative RBF) and single-fidelity RBF using four benchmark test functions, by which the impacts of different high-fidelity sample sizes on the prediction accuracy were also analyzed. The sensitivity of the MMFS model to the randomness of the design of experiments (DoE) was investigated by repeating sampling plans with 20 different DoEs. Stress analysis of the steel plate is presented to highlight the prediction ability of the proposed MMFS model. This research proposes a new multifidelity modeling method that can fully use two fidelity sample sets, rapidly calculate model parameters, and exhibit good prediction accuracy and robustness.
2022, 35: 79.
doi: 10.1186/s10033-022-00718-z
Abstract:
Rheological properties are the theoretical basis and the key to common problems in ferrofluid applications, therefore they are expected to be adjustable to satisfy different technical requirements through altering the microstructure of ferrofluid during the process of preparation. In this paper, Four ferrofluid samples with different magnetic particle size were prepared by controlling the concentration of precursor solution during co-precipitation process and the rheological properties of these samples were investigated. These samples exhibited field-controlled rheological properties. Eternal magnetic field would enhance the formation of microstructures, resulting in an increase of viscosity. While with the increase of shear rate, microstructures tended to be destroyed, causing viscosity to decrease. There were two opposing mechanisms of the influence of precursor solution concentration. On one hand, the reduction of the precursor solution concentration would produce primary magnetic particles of smaller size. But on the other hand, the surfactant became insufficient to completely coat the magnetic particles because of an increased specific surface area, causing the magnetic particles to aggregate and form secondary clustering structures which strongly enhanced the magnetoviscous effect and weakened the viscoelastic effect.
Rheological properties are the theoretical basis and the key to common problems in ferrofluid applications, therefore they are expected to be adjustable to satisfy different technical requirements through altering the microstructure of ferrofluid during the process of preparation. In this paper, Four ferrofluid samples with different magnetic particle size were prepared by controlling the concentration of precursor solution during co-precipitation process and the rheological properties of these samples were investigated. These samples exhibited field-controlled rheological properties. Eternal magnetic field would enhance the formation of microstructures, resulting in an increase of viscosity. While with the increase of shear rate, microstructures tended to be destroyed, causing viscosity to decrease. There were two opposing mechanisms of the influence of precursor solution concentration. On one hand, the reduction of the precursor solution concentration would produce primary magnetic particles of smaller size. But on the other hand, the surfactant became insufficient to completely coat the magnetic particles because of an increased specific surface area, causing the magnetic particles to aggregate and form secondary clustering structures which strongly enhanced the magnetoviscous effect and weakened the viscoelastic effect.
2022, 35: 81.
doi: 10.1186/s10033-022-00750-z
Abstract:
In aerospace engineering, design and optimization of mechanical structures are usually performed with respect to elastic limit. Besides causing insufficient use of the material, such design concept fails to meet the ever growing needs of the light weight design. To remedy this problem, in the present study, a shakedown theory based numerical approach for performing parametric optimization is presented. Within this approach, strength of the structure is measured by its shakedown limit calculated from the direct method. The numerical method developed for the structural optimization consists of nested loops: the inner loop adopts the interior point method to solve shakedown problems pertained to fixed design parameters, while the outer loop employs the genetic algorithm to find optimal design parameters leading to the greatest shakedown limit. The method established is first verified by the classic plate-with-a-circular-hole example, and after that it is applied to an airtight module for determining few key design parameters. By carefully analyzing results generated during the optimization process, it is convinced that the approach can become a viable means for designing similar aerospace structures.
In aerospace engineering, design and optimization of mechanical structures are usually performed with respect to elastic limit. Besides causing insufficient use of the material, such design concept fails to meet the ever growing needs of the light weight design. To remedy this problem, in the present study, a shakedown theory based numerical approach for performing parametric optimization is presented. Within this approach, strength of the structure is measured by its shakedown limit calculated from the direct method. The numerical method developed for the structural optimization consists of nested loops: the inner loop adopts the interior point method to solve shakedown problems pertained to fixed design parameters, while the outer loop employs the genetic algorithm to find optimal design parameters leading to the greatest shakedown limit. The method established is first verified by the classic plate-with-a-circular-hole example, and after that it is applied to an airtight module for determining few key design parameters. By carefully analyzing results generated during the optimization process, it is convinced that the approach can become a viable means for designing similar aerospace structures.
2022, 35: 82.
doi: 10.1186/s10033-022-00746-9
Abstract:
Initial residual stress is the main reason causing machining deformation of the workpiece, which has been deemed as one of the most important aspects of machining quality issues. The inference of the distribution of initial residual stress inside the blank has significant meaning for machining deformation control. Due to the principle error of existing residual stress detection methods, there are still challenges in practical applications. Aiming at the detection problem of the initial residual stress field, an initial residual stress inference method by incorporating monitoring data and mechanism model is proposed in this paper. Monitoring data during machining process is used to represent the macroscopic characterization of the unbalanced residual stress, and the finite element numerical model is used as the mechanism model so as to solve the problem that the analytic mechanism model is difficult to establish; the policy gradient approach is introduced to solve the gradient descent problem of the combination of learning model and mechanism model. Finally, the initial residual stress field is obtained through iterative calculation based on the fusing method of monitoring data and mechanism model. Verification results show that the proposed inference method of initial residual stress field can accurately and effectively reflect the machining deformation in the actual machining process.
Initial residual stress is the main reason causing machining deformation of the workpiece, which has been deemed as one of the most important aspects of machining quality issues. The inference of the distribution of initial residual stress inside the blank has significant meaning for machining deformation control. Due to the principle error of existing residual stress detection methods, there are still challenges in practical applications. Aiming at the detection problem of the initial residual stress field, an initial residual stress inference method by incorporating monitoring data and mechanism model is proposed in this paper. Monitoring data during machining process is used to represent the macroscopic characterization of the unbalanced residual stress, and the finite element numerical model is used as the mechanism model so as to solve the problem that the analytic mechanism model is difficult to establish; the policy gradient approach is introduced to solve the gradient descent problem of the combination of learning model and mechanism model. Finally, the initial residual stress field is obtained through iterative calculation based on the fusing method of monitoring data and mechanism model. Verification results show that the proposed inference method of initial residual stress field can accurately and effectively reflect the machining deformation in the actual machining process.
2022, 35: 86.
doi: 10.1186/s10033-022-00757-6
Abstract:
Raising the rotational speed of an axial piston pump is useful for improving its power density; however, the churning losses of the piston increase significantly with increasing speed, and this reduces the performance and efficiency of the axial piston pump. Currently, there has been some research on the churning losses of pistons; however, it has rarely been analyzed from the perspective of the piston number. To improve the performance and efficiency of the axial piston pump, a computational fluid dynamics (CFD) simulation model of the churning loss was established, and the effect of piston number on the churning loss was studied in detail. The simulation analysis results revealed that the churning losses initially increased as the number of pistons increased; however, when the number of pistons increased from six to nine, the torque of the churning losses decreased because of the hydrodynamic shadowing effect. In addition, in the analysis of cavitation results, it was determined that the cavitation area of the axial piston pump was mainly concentrated around the piston, and the cavitation became increasingly severe as the speed increased. By comparing the simulation results with and without the cavitation model, it was observed that the cavitation phenomenon is beneficial for the reduction of churning losses. In this study, a piston churning loss test rig that can eliminate other friction losses was established to verify the accuracy of the simulation results. A comparative analysis indicated that the simulation results were consistent with the actual situation. In addition, this study also conducted a simulation study on seven and nine piston pumps with the same displacement. The simulation results revealed that churning losses of the seven pistons were generally greater than those of the nine pistons under the same displacement. In addition, regarding the same piston number and displacement, reducing the pitch circle radius of piston bores is effective in reducing the churning loss. This research analyzes the effect of piston number on the churning loss, which has certain guiding significance for the structural design and model selection of axial piston pumps.
Raising the rotational speed of an axial piston pump is useful for improving its power density; however, the churning losses of the piston increase significantly with increasing speed, and this reduces the performance and efficiency of the axial piston pump. Currently, there has been some research on the churning losses of pistons; however, it has rarely been analyzed from the perspective of the piston number. To improve the performance and efficiency of the axial piston pump, a computational fluid dynamics (CFD) simulation model of the churning loss was established, and the effect of piston number on the churning loss was studied in detail. The simulation analysis results revealed that the churning losses initially increased as the number of pistons increased; however, when the number of pistons increased from six to nine, the torque of the churning losses decreased because of the hydrodynamic shadowing effect. In addition, in the analysis of cavitation results, it was determined that the cavitation area of the axial piston pump was mainly concentrated around the piston, and the cavitation became increasingly severe as the speed increased. By comparing the simulation results with and without the cavitation model, it was observed that the cavitation phenomenon is beneficial for the reduction of churning losses. In this study, a piston churning loss test rig that can eliminate other friction losses was established to verify the accuracy of the simulation results. A comparative analysis indicated that the simulation results were consistent with the actual situation. In addition, this study also conducted a simulation study on seven and nine piston pumps with the same displacement. The simulation results revealed that churning losses of the seven pistons were generally greater than those of the nine pistons under the same displacement. In addition, regarding the same piston number and displacement, reducing the pitch circle radius of piston bores is effective in reducing the churning loss. This research analyzes the effect of piston number on the churning loss, which has certain guiding significance for the structural design and model selection of axial piston pumps.
2022, 35: 88.
doi: 10.1186/s10033-022-00759-4
Abstract:
Variable gauge rolling is a new process to obtain a plate for which the thickness changes continuously by continuously and dynamically adjusting the roll gap upward and downward in the rolling process. This technology is an effective method for producing lightweight, low-cost, and economical plates. However, variable gauge rolling is an unsteady process, and the changes in the force and deformation parameters are complex. In this research, based on the minimum energy theory of the variational principle and considering the characteristics of the roll movement and workpiece deformation comprehensively, the internal plastic deformation, friction, shear and tension powers, and the minimum result of the total power functional in upward and downward rolling are obtained with the first integral and then with a variation of adopting the specific plastic power and strain rate vector inner product. The analytical results of the deformation and force parameters are also established using the variational method. Then the precision of this model is certified using the measured values in a medium plate hot rolling plant and the experimental data for Tailor Rolled Blank rolling. Good agreement is found. Additionally, the variation rule of bite angle, neutral angle, and location neutral points are shown, and the change mechanism of the friction parameter on the stress state effect coefficient is given in variable gauge rolling. This research proposes a new mathematical model for rolling process control that provides a scientific basis and technical support for obtaining an accurate section shape in variable gauge rolling production.
Variable gauge rolling is a new process to obtain a plate for which the thickness changes continuously by continuously and dynamically adjusting the roll gap upward and downward in the rolling process. This technology is an effective method for producing lightweight, low-cost, and economical plates. However, variable gauge rolling is an unsteady process, and the changes in the force and deformation parameters are complex. In this research, based on the minimum energy theory of the variational principle and considering the characteristics of the roll movement and workpiece deformation comprehensively, the internal plastic deformation, friction, shear and tension powers, and the minimum result of the total power functional in upward and downward rolling are obtained with the first integral and then with a variation of adopting the specific plastic power and strain rate vector inner product. The analytical results of the deformation and force parameters are also established using the variational method. Then the precision of this model is certified using the measured values in a medium plate hot rolling plant and the experimental data for Tailor Rolled Blank rolling. Good agreement is found. Additionally, the variation rule of bite angle, neutral angle, and location neutral points are shown, and the change mechanism of the friction parameter on the stress state effect coefficient is given in variable gauge rolling. This research proposes a new mathematical model for rolling process control that provides a scientific basis and technical support for obtaining an accurate section shape in variable gauge rolling production.
2022, 35: 92.
doi: 10.1186/s10033-022-00766-5
Abstract:
Additive manufacturing (AM) technologies have been recognized for their capability to build complex components and hence have offered more freedom to designers for a long time. The ability to directly use a computer-aided design (CAD) model has allowed for fabricating and realizing complicated components, monolithic design, reducing the number of components in an assembly, decreasing time to market, and adding performance or comfort-enhancing functionalities. One of the features that can be introduced for boosting a component functionality using AM is the inclusion of surface texture on a given component. This inclusion is usually a difficult task as creating a CAD model resolving fine details of a given texture is difficult even using commercial software packages. This paper develops a methodology to include texture directly on the CAD model of a target surface using a patch-based sampling texture synthesis algorithm, which can be manufactured using AM. Input for the texture generation algorithm can be either a physical sample or an image with heightmap information. The heightmap information from a physical sample can be obtained by 3D scanning the sample and using the information from the acquired point cloud. After obtaining the required inputs, the patches are sampled for texture generation according to non-parametric estimation of the local conditional Markov random field (MRF) density function, which helps avoid mismatched features across the patch boundaries. While generating the texture, a design constraint to ensure AM producibility is considered, which is essential when manufacturing a component using, e.g., Fused Deposition Melting (FDM) or Laser Powder Bed Fusion (LPBF). The generated texture is then mapped onto the surface using the developed distance and angle preserving mapping algorithms. The implemented algorithms can be used to map the generated texture onto a mathematically defined surface. This paper maps the textures onto flat, curved, and sinusoidal surfaces for illustration. After the texture mapping, a stereolithography (STL) model is generated with the desired texture on the target surface. The generated STL model is printed using FDM technology as a final step.
Additive manufacturing (AM) technologies have been recognized for their capability to build complex components and hence have offered more freedom to designers for a long time. The ability to directly use a computer-aided design (CAD) model has allowed for fabricating and realizing complicated components, monolithic design, reducing the number of components in an assembly, decreasing time to market, and adding performance or comfort-enhancing functionalities. One of the features that can be introduced for boosting a component functionality using AM is the inclusion of surface texture on a given component. This inclusion is usually a difficult task as creating a CAD model resolving fine details of a given texture is difficult even using commercial software packages. This paper develops a methodology to include texture directly on the CAD model of a target surface using a patch-based sampling texture synthesis algorithm, which can be manufactured using AM. Input for the texture generation algorithm can be either a physical sample or an image with heightmap information. The heightmap information from a physical sample can be obtained by 3D scanning the sample and using the information from the acquired point cloud. After obtaining the required inputs, the patches are sampled for texture generation according to non-parametric estimation of the local conditional Markov random field (MRF) density function, which helps avoid mismatched features across the patch boundaries. While generating the texture, a design constraint to ensure AM producibility is considered, which is essential when manufacturing a component using, e.g., Fused Deposition Melting (FDM) or Laser Powder Bed Fusion (LPBF). The generated texture is then mapped onto the surface using the developed distance and angle preserving mapping algorithms. The implemented algorithms can be used to map the generated texture onto a mathematically defined surface. This paper maps the textures onto flat, curved, and sinusoidal surfaces for illustration. After the texture mapping, a stereolithography (STL) model is generated with the desired texture on the target surface. The generated STL model is printed using FDM technology as a final step.
2022, 35: 94.
doi: 10.1186/s10033-022-00768-3
Abstract:
The shallow subsurface defects are difficult to be identified and quantified by ultrasonic time-of-flight diffraction (TOFD) due to the low resolution induced by pulse width and beam spreading. In this paper, Sparse-SAFT is proposed to improve the time resolution and lateral resolution in TOFD imaging by combining sparse deconvolution and synthetic aperture focusing technique (SAFT). The mathematical model in the frequency domain is established based on the l1 and l2 norm constraints, and the optimization problem is solved for enhancing time resolution. On this basis, SAFT is employed to improve lateral resolution by delay-and-sum beamforming. The simulated and experimental results indicate that the lateral wave and tip-diffracted waves can be decoupled with Sparse-SAFT. The shallow subsurface defects with a height of 3.0 mm at the depth of 3.0 mm were detected quantitatively, and the relative measurement errors of flaw heights and depths were no more than 10.3%. Compared to conventional SAFT, the time resolution and lateral resolution are enhanced by 72.5 and 56% with Sparse-SAFT, respectively. Finally, the proposed method is also suitable for improving resolution to detect the defects beyond dead zone.
The shallow subsurface defects are difficult to be identified and quantified by ultrasonic time-of-flight diffraction (TOFD) due to the low resolution induced by pulse width and beam spreading. In this paper, Sparse-SAFT is proposed to improve the time resolution and lateral resolution in TOFD imaging by combining sparse deconvolution and synthetic aperture focusing technique (SAFT). The mathematical model in the frequency domain is established based on the l1 and l2 norm constraints, and the optimization problem is solved for enhancing time resolution. On this basis, SAFT is employed to improve lateral resolution by delay-and-sum beamforming. The simulated and experimental results indicate that the lateral wave and tip-diffracted waves can be decoupled with Sparse-SAFT. The shallow subsurface defects with a height of 3.0 mm at the depth of 3.0 mm were detected quantitatively, and the relative measurement errors of flaw heights and depths were no more than 10.3%. Compared to conventional SAFT, the time resolution and lateral resolution are enhanced by 72.5 and 56% with Sparse-SAFT, respectively. Finally, the proposed method is also suitable for improving resolution to detect the defects beyond dead zone.
2022, 35: 98.
doi: 10.1186/s10033-022-00752-x
Abstract:
Casing parts are regarded as key components of aero-engines. Most casing parts are attached to convex structures of different shapes, whose heights range from hundreds of microns to tens of millimeters. Using profiling blocky electrodes for electrochemical machining (ECM) of casing parts is a commonly adopted method, especially when highly convex structures. However, with an increase in the convex structure height, the flow fields of the machining areas become more complex, and short circuits may occur at any time. In this study, a method to improve the flow field characteristics within a machining area by adjusting the backwater pressure is proposed and validated through simulation and experiment analyses. The simulation results demonstrated that the back-pressure method can significantly improve the uniformity of the flow field around the convex structure compared with the extraction and open outlet modes. Subsequently, the back-pressure value was optimized at 0.5 MPa according to the simulation results. The experimental results showed that using the optimized back-pressure parameters, the cathode feed-rate increased from 0.6 to 0.7 mm/min, and a 16.1 mm tall convex structure was successfully machined. This indicates that the back-pressure method is suitable and effective for electrochemical machining of highly convex structures with blocky electrodes. In this study, we propose a method to improve the electrochemical machining stability of a convex structure on a casing surface using backwater pressure, which has achieved remarkable results.
Casing parts are regarded as key components of aero-engines. Most casing parts are attached to convex structures of different shapes, whose heights range from hundreds of microns to tens of millimeters. Using profiling blocky electrodes for electrochemical machining (ECM) of casing parts is a commonly adopted method, especially when highly convex structures. However, with an increase in the convex structure height, the flow fields of the machining areas become more complex, and short circuits may occur at any time. In this study, a method to improve the flow field characteristics within a machining area by adjusting the backwater pressure is proposed and validated through simulation and experiment analyses. The simulation results demonstrated that the back-pressure method can significantly improve the uniformity of the flow field around the convex structure compared with the extraction and open outlet modes. Subsequently, the back-pressure value was optimized at 0.5 MPa according to the simulation results. The experimental results showed that using the optimized back-pressure parameters, the cathode feed-rate increased from 0.6 to 0.7 mm/min, and a 16.1 mm tall convex structure was successfully machined. This indicates that the back-pressure method is suitable and effective for electrochemical machining of highly convex structures with blocky electrodes. In this study, we propose a method to improve the electrochemical machining stability of a convex structure on a casing surface using backwater pressure, which has achieved remarkable results.
2022, 35: 101.
doi: 10.1186/s10033-022-00770-9
Abstract:
The processed surface contour shape is extracted with the finite element simulation software. The difference value of contour shape change is used as the parameters of balancing surface roughness to construct finite element model of supersonic vibration milling in cutting stability domain. The surface roughness trial scheme is designed in the orthogonal test design method to analyze the surface roughness test result in the response surface methodology. The surface roughness prediction model is established and optimized. Finally, the surface roughness finite element simulation prediction model is verified by experiments. The research results show that, compared with the experiment results, the error range of the finite element simulation model is 27.5%–30.9%, and the error range of the empirical model obtained by the response surface method is between 4.4% and 12.3%. So, the model in this paper is accurate and will provide the theoretical basis for the optimization study of the auxiliary milling process of supersonic vibration.
The processed surface contour shape is extracted with the finite element simulation software. The difference value of contour shape change is used as the parameters of balancing surface roughness to construct finite element model of supersonic vibration milling in cutting stability domain. The surface roughness trial scheme is designed in the orthogonal test design method to analyze the surface roughness test result in the response surface methodology. The surface roughness prediction model is established and optimized. Finally, the surface roughness finite element simulation prediction model is verified by experiments. The research results show that, compared with the experiment results, the error range of the finite element simulation model is 27.5%–30.9%, and the error range of the empirical model obtained by the response surface method is between 4.4% and 12.3%. So, the model in this paper is accurate and will provide the theoretical basis for the optimization study of the auxiliary milling process of supersonic vibration.
2022, 35: 105.
doi: 10.1186/s10033-022-00763-8
Abstract:
The assembly process of aerospace products such as satellites and rockets has the characteristics of single- or small-batch production, a long development period, high reliability, and frequent disturbances. How to predict and avoid quality abnormalities, quickly locate their causes, and improve product assembly quality and efficiency are urgent engineering issues. As the core technology to realize the integration of virtual and physical space, digital twin (DT) technology can make full use of the low cost, high efficiency, and predictable advantages of digital space to provide a feasible solution to such problems. Hence, a quality management method for the assembly process of aerospace products based on DT is proposed. Given that traditional quality control methods for the assembly process of aerospace products are mostly post-inspection, the Grey-Markov model and T-K control chart are used with a small sample of assembly quality data to predict the value of quality data and the status of an assembly system. The Apriori algorithm is applied to mine the strong association rules related to quality data anomalies and uncontrolled assembly systems so as to solve the issue that the causes of abnormal quality are complicated and difficult to trace. The implementation of the proposed approach is described, taking the collected centroid data of an aerospace product's cabin, one of the key quality data in the assembly process of aerospace products, as an example. A DT-based quality management system for the assembly process of aerospace products is developed, which can effectively improve the efficiency of quality management for the assembly process of aerospace products and reduce quality abnormalities.
The assembly process of aerospace products such as satellites and rockets has the characteristics of single- or small-batch production, a long development period, high reliability, and frequent disturbances. How to predict and avoid quality abnormalities, quickly locate their causes, and improve product assembly quality and efficiency are urgent engineering issues. As the core technology to realize the integration of virtual and physical space, digital twin (DT) technology can make full use of the low cost, high efficiency, and predictable advantages of digital space to provide a feasible solution to such problems. Hence, a quality management method for the assembly process of aerospace products based on DT is proposed. Given that traditional quality control methods for the assembly process of aerospace products are mostly post-inspection, the Grey-Markov model and T-K control chart are used with a small sample of assembly quality data to predict the value of quality data and the status of an assembly system. The Apriori algorithm is applied to mine the strong association rules related to quality data anomalies and uncontrolled assembly systems so as to solve the issue that the causes of abnormal quality are complicated and difficult to trace. The implementation of the proposed approach is described, taking the collected centroid data of an aerospace product's cabin, one of the key quality data in the assembly process of aerospace products, as an example. A DT-based quality management system for the assembly process of aerospace products is developed, which can effectively improve the efficiency of quality management for the assembly process of aerospace products and reduce quality abnormalities.
2022, 35: 107.
doi: 10.1186/s10033-022-00772-7
Abstract:
Forming of various customized bending parts, small batches, as well as numerous types of materials is a new challenges for Industry 4.0, the current control strategies can not meet the precision and flexibility requirement, expected control strategy of bending processes need to not only resist unknown interferences of process condition and models, but also produce various new parts automatically and efficiently. In this paper, a precision and flexible bending control strategy based on analytical models and data models is proposed to build adaptive bending systems. New analytical prediction models for loading and unloading are established and suitable for various materials, a sequential identification strategy is proposed to search nominal properties using the four sub-optimization models. A data-based feedback model is established to prevent over-bending and eliminate online deviation. Above models are merged into a precision and flexible control strategy. The system firstly uses sub-optimization models to search the nominal point which is near to target point, secondly the system further uses feedback model to eliminate residual error between the nominal point and target point. Compared with four kinds sheet metals, the allowable ranges for variables are determined for a good convergence. The target bending angles were set to 20°, 40°, and 60°. Forty parts were tracked for each kind material, the adaptive bending system converged after one iteration, and exhibited better performances.
Forming of various customized bending parts, small batches, as well as numerous types of materials is a new challenges for Industry 4.0, the current control strategies can not meet the precision and flexibility requirement, expected control strategy of bending processes need to not only resist unknown interferences of process condition and models, but also produce various new parts automatically and efficiently. In this paper, a precision and flexible bending control strategy based on analytical models and data models is proposed to build adaptive bending systems. New analytical prediction models for loading and unloading are established and suitable for various materials, a sequential identification strategy is proposed to search nominal properties using the four sub-optimization models. A data-based feedback model is established to prevent over-bending and eliminate online deviation. Above models are merged into a precision and flexible control strategy. The system firstly uses sub-optimization models to search the nominal point which is near to target point, secondly the system further uses feedback model to eliminate residual error between the nominal point and target point. Compared with four kinds sheet metals, the allowable ranges for variables are determined for a good convergence. The target bending angles were set to 20°, 40°, and 60°. Forty parts were tracked for each kind material, the adaptive bending system converged after one iteration, and exhibited better performances.
2022, 35: 108.
doi: 10.1186/s10033-022-00782-5
Abstract:
Precision grinding is a key process for realizing the use of large-aperture aspherical optical elements in laser nuclear fusion devices, large-aperture astronomical telescopes, and high-resolution space cameras. In this study, the arc envelope grinding process of large-aperture aspherical optics is investigated using a CM1500 precision grinding machine with a maximum machinable diameter of Φ1500 mm. The form error of the aspherical workpiece induced by wheel setting errors is analytically modeled for both parallel and cross grinding. Results show that the form error is more sensitive to the wheel setting error along the feed direction than that along the lateral direction. It is a bilinear function of the feed-direction wheel setting error and the distance to the optical axis. Based on the error function above, a method to determine the wheel setting error is proposed. Subsequently, grinding tests are performed with the wheels aligned accurately. Using a newly proposed partial error compensation method with an appropriate compensation factor, a form error of 3.4 μm peak-to-valley (PV) for a Φ400 mm elliptical K9 glass surface is achieved.
Precision grinding is a key process for realizing the use of large-aperture aspherical optical elements in laser nuclear fusion devices, large-aperture astronomical telescopes, and high-resolution space cameras. In this study, the arc envelope grinding process of large-aperture aspherical optics is investigated using a CM1500 precision grinding machine with a maximum machinable diameter of Φ1500 mm. The form error of the aspherical workpiece induced by wheel setting errors is analytically modeled for both parallel and cross grinding. Results show that the form error is more sensitive to the wheel setting error along the feed direction than that along the lateral direction. It is a bilinear function of the feed-direction wheel setting error and the distance to the optical axis. Based on the error function above, a method to determine the wheel setting error is proposed. Subsequently, grinding tests are performed with the wheels aligned accurately. Using a newly proposed partial error compensation method with an appropriate compensation factor, a form error of 3.4 μm peak-to-valley (PV) for a Φ400 mm elliptical K9 glass surface is achieved.
2022, 35: 111.
doi: 10.1186/s10033-022-00787-0
Abstract:
Low excitation voltage for an electromagnetic acoustic transducer (EMAT) is necessary for the petrochemical equipment and facilities inspection, which work at high-temperatures, to avoid potential explosion. However, low excitation voltage causes low signal-to-noise ratio (SNR) signals that are difficult to extract features, especially in a high-temperature environment, which causes high noise. In this study, a denoising method called the variational wavelet ensemble empirical (VWEE) method was proposed by combining the advantages of the variational modal decomposition (VMD), wavelet threshold (WT) denoising, and ensemble empirical mode decomposition (EEMD) methods. To validate the VWEE method, EMAT signals obtained in the temperature range of 25 to 700 ℃ were analyzed. The results show that, compared with VMD, WT and empirical mode decomposition denoising methods, the SNR of proposed method is improved more than two times. The VWEE method dramatically improved the SNR of a high-temperature EMAT signal and enhanced the accuracy of defect echos extraction.
Low excitation voltage for an electromagnetic acoustic transducer (EMAT) is necessary for the petrochemical equipment and facilities inspection, which work at high-temperatures, to avoid potential explosion. However, low excitation voltage causes low signal-to-noise ratio (SNR) signals that are difficult to extract features, especially in a high-temperature environment, which causes high noise. In this study, a denoising method called the variational wavelet ensemble empirical (VWEE) method was proposed by combining the advantages of the variational modal decomposition (VMD), wavelet threshold (WT) denoising, and ensemble empirical mode decomposition (EEMD) methods. To validate the VWEE method, EMAT signals obtained in the temperature range of 25 to 700 ℃ were analyzed. The results show that, compared with VMD, WT and empirical mode decomposition denoising methods, the SNR of proposed method is improved more than two times. The VWEE method dramatically improved the SNR of a high-temperature EMAT signal and enhanced the accuracy of defect echos extraction.
2022, 35: 116.
doi: 10.1186/s10033-022-00776-3
Abstract:
Measuring and reconstructing the shape of workpieces have been considered as a fundamental step in both reverse engineering and product quality control. Owing to increasing structural complexity of recent products, measurements from multiple directions are typically required in current scanning techniques. Specifically, the plane structured light can be applied to measure one area of a part at a time, with an additional algorithm required to merge the collected data of each area. Alternatively, the line structured light sensor integrated on CNC machines or CMMs could also realize multi-view measurement. However, the system needs to be repeatedly calibrated at each new direction. This paper presents a flexible scanning method by integrating laser line sensors with articulated arm coordinate measuring machines (AACMM). Since the output of the laser line sensor is 2D raw data in the laser plane, our system model introduces an explicit transformation from the 2D sensor coordinate frame to the 3D base coordinate frame of the AACMM (i.e., the translation and rotation the of the 2D sensor coordinate in the sixth coordinate system of AACMM). To solve the model, the "conjugate pairs" are proposed and identified by measuring a fixed point (e.g., a sphere center). Moreover, a search algorithm is adopted to find the optimal solution, which noticeably boosts the model accuracy. The experimental results show that the error of the system is about 0.2 mm, which is caused by the error of the AACMM, the sensor error and the calibration error. By measuring a complicated part, the proposed system is proved to be flexible and facilitate, with the ability to measure a part expediently from any necessary direction. Furthermore, the proposed calibration method can also be used for robot hand-eye relationship calibration.
Measuring and reconstructing the shape of workpieces have been considered as a fundamental step in both reverse engineering and product quality control. Owing to increasing structural complexity of recent products, measurements from multiple directions are typically required in current scanning techniques. Specifically, the plane structured light can be applied to measure one area of a part at a time, with an additional algorithm required to merge the collected data of each area. Alternatively, the line structured light sensor integrated on CNC machines or CMMs could also realize multi-view measurement. However, the system needs to be repeatedly calibrated at each new direction. This paper presents a flexible scanning method by integrating laser line sensors with articulated arm coordinate measuring machines (AACMM). Since the output of the laser line sensor is 2D raw data in the laser plane, our system model introduces an explicit transformation from the 2D sensor coordinate frame to the 3D base coordinate frame of the AACMM (i.e., the translation and rotation the of the 2D sensor coordinate in the sixth coordinate system of AACMM). To solve the model, the "conjugate pairs" are proposed and identified by measuring a fixed point (e.g., a sphere center). Moreover, a search algorithm is adopted to find the optimal solution, which noticeably boosts the model accuracy. The experimental results show that the error of the system is about 0.2 mm, which is caused by the error of the AACMM, the sensor error and the calibration error. By measuring a complicated part, the proposed system is proved to be flexible and facilitate, with the ability to measure a part expediently from any necessary direction. Furthermore, the proposed calibration method can also be used for robot hand-eye relationship calibration.
2022, 35: 117.
doi: 10.1186/s10033-022-00785-2
Abstract:
Water-based lubrication is an effective method to achieve superlubricity, which implies a friction coefficient in the order of 10−3 or lower. Recent numerical, analytical, and experimental studies confirm that the surface force effect is crucial for realizing water-based superlubricity. To enhance the contribution of the surface force, soft and plastic materials can be utilized as friction pair materials because of their effect in increasing the contact area. A new numerical model of water-based lubrication that considers the surface force between plastic and elastic materials is developed in this study to investigate the effect of plastic flow in water-based lubrication. Considering the complexity of residual stress accumulation in lubrication problems, a simplified plastic model is proposed, which merely calculates the result of the dry contact solution and avoids repeated calculations of the plastic flow. The results of the two models show good agreement. Plastic deformation reduces the local contact pressure and enhances the function of the surface force, thus resulting in a lower friction coefficient.
Water-based lubrication is an effective method to achieve superlubricity, which implies a friction coefficient in the order of 10−3 or lower. Recent numerical, analytical, and experimental studies confirm that the surface force effect is crucial for realizing water-based superlubricity. To enhance the contribution of the surface force, soft and plastic materials can be utilized as friction pair materials because of their effect in increasing the contact area. A new numerical model of water-based lubrication that considers the surface force between plastic and elastic materials is developed in this study to investigate the effect of plastic flow in water-based lubrication. Considering the complexity of residual stress accumulation in lubrication problems, a simplified plastic model is proposed, which merely calculates the result of the dry contact solution and avoids repeated calculations of the plastic flow. The results of the two models show good agreement. Plastic deformation reduces the local contact pressure and enhances the function of the surface force, thus resulting in a lower friction coefficient.
2022, 35: 118.
doi: 10.1186/s10033-022-00788-z
Abstract:
Solid contamination existing as solid particles in power fluid transmission systems may lead to transmission performance reduction, system failures, and component damage. The hydraulic reservoir will deposit the contamination and store hydraulic fluid. To investigate its purification ability for solid contamination, experiments and simulations for the motion and deposition status of the typical hydraulic system particles are carried out to reveal the interaction of particles and fluid in hydraulic water reservoirs. The results show that the CFD-DEM coupling method could predict the accurate deposition position of iron particles and sand particles when ignoring the small-scale turbulence effect in the flow field. Besides, the particle motion traces and deposition patterns in the reservoir illustrate that the flow development on the bottom surface results in the particles turning, and particles tend to settle in the low flow energy position. The motion of particles is also linked to particles Stokes number, and the same-size sand particles are easily driven by the fluid. The contribution of this paper could provide a guide for predicting the particle motion and deposition pattern in the hydraulic reservoir.
Solid contamination existing as solid particles in power fluid transmission systems may lead to transmission performance reduction, system failures, and component damage. The hydraulic reservoir will deposit the contamination and store hydraulic fluid. To investigate its purification ability for solid contamination, experiments and simulations for the motion and deposition status of the typical hydraulic system particles are carried out to reveal the interaction of particles and fluid in hydraulic water reservoirs. The results show that the CFD-DEM coupling method could predict the accurate deposition position of iron particles and sand particles when ignoring the small-scale turbulence effect in the flow field. Besides, the particle motion traces and deposition patterns in the reservoir illustrate that the flow development on the bottom surface results in the particles turning, and particles tend to settle in the low flow energy position. The motion of particles is also linked to particles Stokes number, and the same-size sand particles are easily driven by the fluid. The contribution of this paper could provide a guide for predicting the particle motion and deposition pattern in the hydraulic reservoir.
2022, 35: 121.
doi: 10.1186/s10033-022-00794-1
Abstract:
Existing models of bulk modulus for aerated hydraulic fluids primarily focus on the effects of pressure and air fraction, whereas the effect of temperature on bulk modulus is disregarded. Based on the lumped parameter method and the full cavitation model, combined with the improved Henry's law and the air polytropic course equation, a theoretical model of dynamic bulk modulus for an aerated hydraulic fluid is derived. The effects of system pressure, air fraction, and temperature on bulk modulus are investigated using the controlled variable method. The results show that the dynamic bulk modulus of the aerated hydraulic fluid is inconsistent during the compression process. At the same pressure point, the dynamic bulk modulus during expansion is higher than that during compression. Under the same initial air faction and pressure changing period, a higher temperature results in a lower dynamic bulk modulus. When the pressure is lower, the dynamic bulk modulus of each temperature point is more similar to each other. By comparing the theoretical results with the actual dynamic bulk modulus of the Shell Tellus S ISO32 standard air-containing oil, the goodness-of-fit between the theoretical model and experimental value at three temperatures is 0.9726, 0.9732, and 0.9675, which validates the theoretical model. In this study, a calculation model of dynamic bulk modulus that considers temperature factors is proposed. It predicts the dynamic bulk modulus of aerated hydraulic fluids at different temperatures and provides a theoretical basis for improving the analytical model of bulk modulus.
Existing models of bulk modulus for aerated hydraulic fluids primarily focus on the effects of pressure and air fraction, whereas the effect of temperature on bulk modulus is disregarded. Based on the lumped parameter method and the full cavitation model, combined with the improved Henry's law and the air polytropic course equation, a theoretical model of dynamic bulk modulus for an aerated hydraulic fluid is derived. The effects of system pressure, air fraction, and temperature on bulk modulus are investigated using the controlled variable method. The results show that the dynamic bulk modulus of the aerated hydraulic fluid is inconsistent during the compression process. At the same pressure point, the dynamic bulk modulus during expansion is higher than that during compression. Under the same initial air faction and pressure changing period, a higher temperature results in a lower dynamic bulk modulus. When the pressure is lower, the dynamic bulk modulus of each temperature point is more similar to each other. By comparing the theoretical results with the actual dynamic bulk modulus of the Shell Tellus S ISO32 standard air-containing oil, the goodness-of-fit between the theoretical model and experimental value at three temperatures is 0.9726, 0.9732, and 0.9675, which validates the theoretical model. In this study, a calculation model of dynamic bulk modulus that considers temperature factors is proposed. It predicts the dynamic bulk modulus of aerated hydraulic fluids at different temperatures and provides a theoretical basis for improving the analytical model of bulk modulus.
2022, 35: 122.
doi: 10.1186/s10033-022-00784-3
Abstract:
The manufacturing of spiral groove structure of two-dimensional valve (2D valve) feedback mechanism has shortcomings of both high cost and time-consuming. This paper presents a novel configuration of rotary electro-mechanical converter with negative feedback mechanism (REMC-NFM) in order to replace the feedback mechanism of spiral groove and thus reduce cost of valve manufacturing. In order to rapidly and quantitative evaluate the driving and feedback performance of the REMC-NFM, an analytical model taking leakage flux, edge effect and permeability nonlinearity into account is formulated based on the equivalent magnetic circuit approach. Then the model is properly simplified in order to obtain the optimal pitch angle. FEM simulation is used to study the influence of crucial parameters on the performance of REMC-NFM. A prototype of REMC-NFM is designed and machined, and an exclusive experimental platform is built. The torque-angle characteristics, torque-displacement characteristics, and magnetic flux density in the working air gap with different excitation currents are measured. The experimental results are in good agreement with the analytical and FEM simulated results, which verifies the correctness of the analytical model. For torque-angle characteristics, the overall torque increases with both current and rotation angle, which reaches about 0.48 N·m with 1.5 A and 1.5°. While for torque-displacement characteristics, the overall torque increases with current yet decrease with armature displacement due to the negative feedback mechanism, which is about 0.16 N·m with 1.5 A and 0.8 mm. Besides, experimental results of conventional torque motor are compared with counterparts of REMC-NFM in order to validate the simplified model. The research indicates that the REMC-NFM can be potentially used as the electro-mechanical converter for 2D valves in civil servo areas.
The manufacturing of spiral groove structure of two-dimensional valve (2D valve) feedback mechanism has shortcomings of both high cost and time-consuming. This paper presents a novel configuration of rotary electro-mechanical converter with negative feedback mechanism (REMC-NFM) in order to replace the feedback mechanism of spiral groove and thus reduce cost of valve manufacturing. In order to rapidly and quantitative evaluate the driving and feedback performance of the REMC-NFM, an analytical model taking leakage flux, edge effect and permeability nonlinearity into account is formulated based on the equivalent magnetic circuit approach. Then the model is properly simplified in order to obtain the optimal pitch angle. FEM simulation is used to study the influence of crucial parameters on the performance of REMC-NFM. A prototype of REMC-NFM is designed and machined, and an exclusive experimental platform is built. The torque-angle characteristics, torque-displacement characteristics, and magnetic flux density in the working air gap with different excitation currents are measured. The experimental results are in good agreement with the analytical and FEM simulated results, which verifies the correctness of the analytical model. For torque-angle characteristics, the overall torque increases with both current and rotation angle, which reaches about 0.48 N·m with 1.5 A and 1.5°. While for torque-displacement characteristics, the overall torque increases with current yet decrease with armature displacement due to the negative feedback mechanism, which is about 0.16 N·m with 1.5 A and 0.8 mm. Besides, experimental results of conventional torque motor are compared with counterparts of REMC-NFM in order to validate the simplified model. The research indicates that the REMC-NFM can be potentially used as the electro-mechanical converter for 2D valves in civil servo areas.
2022, 35: 125.
doi: 10.1186/s10033-022-00797-y
Abstract:
To address the problems of large welding deformation and splashing in the resistance spot welding of the lubricating oil cooler plate, the laser spot welding was employed, instead of the resistance spot welding, and a novel laser spot welding was proposed, i.e., laser multi-section welding. The major processes involved in this study referred to a finite element model of pulsed laser lap welding built by adopting SYSWELD simulation software, as well as the laser welding of various welding methods. The effect of different welding methods on the welding quality was studied, the parameters of the average power and the duty cycle were optimized in line with the comparative analysis of the experimentally achieved results and the numerical simulation. As indicated from the experimentally achieved results, when the new 6-sections welding method was adopted, the resulting welded joint achieved the most uniform heat input and the largest welding fusion area, and the tensile properties exhibited by the welded joints were significantly enhanced, whereas some pores remained. By altering the duty cycle, pores could be eliminated to further improve the quality of the joint. The mentioned process method could tackle down the problems facing conventional resistance spot welding. Furthermore, it was capable of improving the uneven heat input of the laser spot welding.
To address the problems of large welding deformation and splashing in the resistance spot welding of the lubricating oil cooler plate, the laser spot welding was employed, instead of the resistance spot welding, and a novel laser spot welding was proposed, i.e., laser multi-section welding. The major processes involved in this study referred to a finite element model of pulsed laser lap welding built by adopting SYSWELD simulation software, as well as the laser welding of various welding methods. The effect of different welding methods on the welding quality was studied, the parameters of the average power and the duty cycle were optimized in line with the comparative analysis of the experimentally achieved results and the numerical simulation. As indicated from the experimentally achieved results, when the new 6-sections welding method was adopted, the resulting welded joint achieved the most uniform heat input and the largest welding fusion area, and the tensile properties exhibited by the welded joints were significantly enhanced, whereas some pores remained. By altering the duty cycle, pores could be eliminated to further improve the quality of the joint. The mentioned process method could tackle down the problems facing conventional resistance spot welding. Furthermore, it was capable of improving the uneven heat input of the laser spot welding.
2022, 35: 126.
doi: 10.1186/s10033-022-00802-4
Abstract:
The considerable heat treatment induced runout value in the end face of the automobile main reducer gear is always dimensionally out of tolerance. It directly affects the dimensional accuracy, the grade of carburized and hardened gears, and the post-quenching manufacturing costs. In this study, three dimensional numerical models were developed to simulate the carburizing-quenching process of gear based on the multi-field coupling theory using DEFORM software. The results indicated that the ununiform cooling rate of the gear caused by the asymmetry of the web structure would result in the ununiform distribution of martensite, leading to the large runout value at the end face of the gear. Therefore, a novel method was proposed to minimize the heat treatment induced runout value. It was found that the heat treatment induced runout value could be effectively controlled by the addition of a compensation ring and the support of a rod structure. Further experiments showed that the average runout value of the gear end face before and after the proposed heat treatment method were about 0.023 mm and 0.059 mm respectively, which was in good agreement with the simulated results. The novel approach proposed in this study led to a reduction of the gear runout value by 70.0%‒76.9% compared to that of the original heat treatment process, which may serve as a practical and economical way to predict and minimize the heat treatment induced distortion in drive gear.
The considerable heat treatment induced runout value in the end face of the automobile main reducer gear is always dimensionally out of tolerance. It directly affects the dimensional accuracy, the grade of carburized and hardened gears, and the post-quenching manufacturing costs. In this study, three dimensional numerical models were developed to simulate the carburizing-quenching process of gear based on the multi-field coupling theory using DEFORM software. The results indicated that the ununiform cooling rate of the gear caused by the asymmetry of the web structure would result in the ununiform distribution of martensite, leading to the large runout value at the end face of the gear. Therefore, a novel method was proposed to minimize the heat treatment induced runout value. It was found that the heat treatment induced runout value could be effectively controlled by the addition of a compensation ring and the support of a rod structure. Further experiments showed that the average runout value of the gear end face before and after the proposed heat treatment method were about 0.023 mm and 0.059 mm respectively, which was in good agreement with the simulated results. The novel approach proposed in this study led to a reduction of the gear runout value by 70.0%‒76.9% compared to that of the original heat treatment process, which may serve as a practical and economical way to predict and minimize the heat treatment induced distortion in drive gear.
2022, 35: 128.
doi: 10.1186/s10033-022-00799-w
Abstract:
The pneumatic vibration isolator (PVI) plays an increasingly important role in precision manufacturing. In this paper, aiming to detect the performance of the pressure regulator in the PVI system, a PVI testing system with a pressure regulator is designed and developed. Firstly, the structure of the pneumatic spring is presented and analyzed, and the nonlinear stiffness is obtained based on the ideal gas model and material mechanics. Then, according to the working principle and continuity equations of ideal airflow, a dynamic model of the PVI system with a pressure regulator is established. Through the simulation analysis, the vibration isolation performance is improved with the efficient and precise pressure regulator. The average values of both the vibration velocity and transmission rate decrease when the vibration is set to 4, 10, 20 and 40 Hz, respectively. The experiments demonstrate the reliability and effectiveness of the pressure regulator. This achievement will become an important basis for future research concerning precision manufacturing.
The pneumatic vibration isolator (PVI) plays an increasingly important role in precision manufacturing. In this paper, aiming to detect the performance of the pressure regulator in the PVI system, a PVI testing system with a pressure regulator is designed and developed. Firstly, the structure of the pneumatic spring is presented and analyzed, and the nonlinear stiffness is obtained based on the ideal gas model and material mechanics. Then, according to the working principle and continuity equations of ideal airflow, a dynamic model of the PVI system with a pressure regulator is established. Through the simulation analysis, the vibration isolation performance is improved with the efficient and precise pressure regulator. The average values of both the vibration velocity and transmission rate decrease when the vibration is set to 4, 10, 20 and 40 Hz, respectively. The experiments demonstrate the reliability and effectiveness of the pressure regulator. This achievement will become an important basis for future research concerning precision manufacturing.
2022, 35: 129.
doi: 10.1186/s10033-022-00804-2
Abstract:
Laser oscillating welding was employed to fabricate Al-Si coated press-hardened steel (PHS) to improve the element homogeneity in the fusion zone. Laser oscillating welding was employed with various oscillation amplitudes (0 mm, 0.5 mm and 1.3 mm) in this present. Ni foil of 0.06 mm thickness was used as an interlayer between two tailored PHS welded. The weld morphology, elemental profile, microstructure and tensile strength of welded joints were studied. The results showed that full penetration weld without any weld defects were achieved for any oscillation amplitudes, and weld width increased with increasing oscillation amplitudes. With the oscillation amplitudes increased, Ni and Al had an uneven elemental profile due to strong stirring force, but the Ni and Al content in the weld was decreased and Ni had a sharp descent compared to Al element. Only few δ-ferrite was presented in fusion line with the oscillation amplitudes increased to 1.3 mm. The oscillation amplitudes did not have an effect on the tensile properties, which was similar to that of base metal. But if keeping increasing the oscillation amplitudes or reducing the thickness of Ni interlayer, it has a potential risk to form more and more δ ferrite such that deteriorate the mechnical properties of welded joints.
Laser oscillating welding was employed to fabricate Al-Si coated press-hardened steel (PHS) to improve the element homogeneity in the fusion zone. Laser oscillating welding was employed with various oscillation amplitudes (0 mm, 0.5 mm and 1.3 mm) in this present. Ni foil of 0.06 mm thickness was used as an interlayer between two tailored PHS welded. The weld morphology, elemental profile, microstructure and tensile strength of welded joints were studied. The results showed that full penetration weld without any weld defects were achieved for any oscillation amplitudes, and weld width increased with increasing oscillation amplitudes. With the oscillation amplitudes increased, Ni and Al had an uneven elemental profile due to strong stirring force, but the Ni and Al content in the weld was decreased and Ni had a sharp descent compared to Al element. Only few δ-ferrite was presented in fusion line with the oscillation amplitudes increased to 1.3 mm. The oscillation amplitudes did not have an effect on the tensile properties, which was similar to that of base metal. But if keeping increasing the oscillation amplitudes or reducing the thickness of Ni interlayer, it has a potential risk to form more and more δ ferrite such that deteriorate the mechnical properties of welded joints.
2022, 35: 131.
doi: 10.1186/s10033-022-00783-4
Abstract:
A three-dimensional numerical model based on the volume-of-fluid (VOF) method is typically preferred for studying high-current gas metal arc welding (GMAW) metal transfer mechanism and then controlling it. It is informed that the rotating spray transfer is extremely complicated, and some researchers have focused on simplified models without considering the energy conservation to make analysis manageable for the unstable metal transfer process. Using our created numerical model, the metal transfer of high-current GMAW with shielding gas of different conductivities has been studied by analyzing acting forces and fluid flows in the metal liquid column, especially for the contributions of the self-induced electromagnetic force, equivalent volume force of the capillary pressure of the surface tension (Named surface tension force in this work), static arc pressure. It is found that the unbalanced electromagnetic force greatly promotes the metal rotating motion in 500 A metal inert gas (MIG) welding with pure argon shielding gas and it pushes the metal liquid column to rotate. Considering the arc constricting effect in active shielding gas by simply changing the arc conductivity, it is found that the metal liquid column no longer rotates, it turns to swing since the unbalanced electromagnetic force is large enough to break the rotating motion. The calculated results of the metal liquid column deflected angle and rotating/swing frequency agree well with the experiment of high-speed camera observations.
A three-dimensional numerical model based on the volume-of-fluid (VOF) method is typically preferred for studying high-current gas metal arc welding (GMAW) metal transfer mechanism and then controlling it. It is informed that the rotating spray transfer is extremely complicated, and some researchers have focused on simplified models without considering the energy conservation to make analysis manageable for the unstable metal transfer process. Using our created numerical model, the metal transfer of high-current GMAW with shielding gas of different conductivities has been studied by analyzing acting forces and fluid flows in the metal liquid column, especially for the contributions of the self-induced electromagnetic force, equivalent volume force of the capillary pressure of the surface tension (Named surface tension force in this work), static arc pressure. It is found that the unbalanced electromagnetic force greatly promotes the metal rotating motion in 500 A metal inert gas (MIG) welding with pure argon shielding gas and it pushes the metal liquid column to rotate. Considering the arc constricting effect in active shielding gas by simply changing the arc conductivity, it is found that the metal liquid column no longer rotates, it turns to swing since the unbalanced electromagnetic force is large enough to break the rotating motion. The calculated results of the metal liquid column deflected angle and rotating/swing frequency agree well with the experiment of high-speed camera observations.
2022, 35: 132.
doi: 10.1186/s10033-022-00803-3
Abstract:
With the continuous development of science and technology, electronic devices have begun to enter all aspects of human life, becoming increasingly closely related to human life. Users have higher quality requirements for electronic devices. Electronic device testing has gradually become an irreplaceable engineering process in modern manufacturing enterprises to guarantee the quality of products while preventing inferior products from entering the market. Considering the large output of electronic devices, improving the testing efficiency while reducing the testing cost has become an urgent problem to be solved. This study investigates the electronic device testing machine allocation problem (EDTMAP), aiming to improve the production of electronic devices and reduce the scheduling distance among testing machines through reasonable machine allocation. First, a mathematical model was formulated for the EDTMAP to maximize both production and the scheduling distance among testing machines. Second, we developed a discrete multi-objective artificial bee colony (DMOABC) algorithm to solve EDTMAP. A crossover operator and local search operator were designed to improve the exploration and exploitation of the algorithm, respectively. Numerical experiments were conducted to evaluate the performance of the proposed algorithm. The experimental results demonstrate the superiority of the proposed algorithm compared with the non-dominated sorting genetic algorithm Ⅱ (NSGA-Ⅱ) and strength Pareto evolutionary algorithm 2 (SPEA2). Finally, the mathematical model and DMOABC algorithm were applied to a real-world factory that tests radio-frequency modules. The results verify that our method can significantly improve production and reduce the scheduling distance among testing machines.
With the continuous development of science and technology, electronic devices have begun to enter all aspects of human life, becoming increasingly closely related to human life. Users have higher quality requirements for electronic devices. Electronic device testing has gradually become an irreplaceable engineering process in modern manufacturing enterprises to guarantee the quality of products while preventing inferior products from entering the market. Considering the large output of electronic devices, improving the testing efficiency while reducing the testing cost has become an urgent problem to be solved. This study investigates the electronic device testing machine allocation problem (EDTMAP), aiming to improve the production of electronic devices and reduce the scheduling distance among testing machines through reasonable machine allocation. First, a mathematical model was formulated for the EDTMAP to maximize both production and the scheduling distance among testing machines. Second, we developed a discrete multi-objective artificial bee colony (DMOABC) algorithm to solve EDTMAP. A crossover operator and local search operator were designed to improve the exploration and exploitation of the algorithm, respectively. Numerical experiments were conducted to evaluate the performance of the proposed algorithm. The experimental results demonstrate the superiority of the proposed algorithm compared with the non-dominated sorting genetic algorithm Ⅱ (NSGA-Ⅱ) and strength Pareto evolutionary algorithm 2 (SPEA2). Finally, the mathematical model and DMOABC algorithm were applied to a real-world factory that tests radio-frequency modules. The results verify that our method can significantly improve production and reduce the scheduling distance among testing machines.
2022, 35: 133.
doi: 10.1186/s10033-022-00806-0
Abstract:
Feature information extraction is one of the key steps in prognostics and health management of rotating machinery. In the present study, an investigation about the feasibility of a methodology based on generalized S transform (GST) and singular value decomposition (SVD) methods for feature extraction in rolling bearing, due to local damage under variable conditions, is conducted. The technique adopts the GST method, following the time-frequency analysis, to transform a raw fault signal of the rolling bearing into a two-dimensional complex matrix. And then, the SVD method is performed to decompose the matrix to obtain the feature vectors. By this procedure it is possible to obtain the fault feature information of rolling bearing under different speeds and different loads. In order to streamline the feature parameters of the feature vectors to train more uncomplicated models, the principal component analysis (PCA) subsequently performed. The particle swarm optimization-support vector machine (PSO-SVM) model is used to identify and classify the different fault states of rolling bearing. Furthermore, in order to highlight the superiority of the proposed method some comparisons are conducted with the conventional methods. The obtained results show that the proposed method can effectively extract fault features of the rolling bearing under variable conditions.
Feature information extraction is one of the key steps in prognostics and health management of rotating machinery. In the present study, an investigation about the feasibility of a methodology based on generalized S transform (GST) and singular value decomposition (SVD) methods for feature extraction in rolling bearing, due to local damage under variable conditions, is conducted. The technique adopts the GST method, following the time-frequency analysis, to transform a raw fault signal of the rolling bearing into a two-dimensional complex matrix. And then, the SVD method is performed to decompose the matrix to obtain the feature vectors. By this procedure it is possible to obtain the fault feature information of rolling bearing under different speeds and different loads. In order to streamline the feature parameters of the feature vectors to train more uncomplicated models, the principal component analysis (PCA) subsequently performed. The particle swarm optimization-support vector machine (PSO-SVM) model is used to identify and classify the different fault states of rolling bearing. Furthermore, in order to highlight the superiority of the proposed method some comparisons are conducted with the conventional methods. The obtained results show that the proposed method can effectively extract fault features of the rolling bearing under variable conditions.
Fabrication of Ordered Micro/Nanostructures Using Probe-Based Force-Controlled Micromachining System
2022, 35: 139.
doi: 10.1186/s10033-022-00808-y
Abstract:
This paper presents a probe-based force-controlled nanoindentation method to fabricate ordered micro/nanostructures. Both the experimental and finite element simulation approaches are employed to investigate the influence of the interval between the adjacent indentations and the rotation angle of the probe on the formed micro/nanostructures. The non-contacting part between indenter and the sample material and the height of the material pile-up are two competing factors to determine the depth relationship between the adjacent indentations. For the one array indentations, nanostructures with good depth consistency and periodicity can be formed after the depth of the indentation becoming stable, and the variation of the rotation angle results in the large difference between the morphology of the formed nanostructures at the bottom of the one array indentation. In addition, for the indentation arrays, the nanostructures with good consistency and periodicity of the shape and depth can be generated with the spacing greater than 1 μm. Finally, Raman tests are also carried out based on the obtained ordered micro/nanostructures with Rhodamine probe molecule. The indentation arrays with a smaller spacing lead to better the enhancement effect of the substrate, which has the potential applications in the fields of biological or chemical molecular detection.
This paper presents a probe-based force-controlled nanoindentation method to fabricate ordered micro/nanostructures. Both the experimental and finite element simulation approaches are employed to investigate the influence of the interval between the adjacent indentations and the rotation angle of the probe on the formed micro/nanostructures. The non-contacting part between indenter and the sample material and the height of the material pile-up are two competing factors to determine the depth relationship between the adjacent indentations. For the one array indentations, nanostructures with good depth consistency and periodicity can be formed after the depth of the indentation becoming stable, and the variation of the rotation angle results in the large difference between the morphology of the formed nanostructures at the bottom of the one array indentation. In addition, for the indentation arrays, the nanostructures with good consistency and periodicity of the shape and depth can be generated with the spacing greater than 1 μm. Finally, Raman tests are also carried out based on the obtained ordered micro/nanostructures with Rhodamine probe molecule. The indentation arrays with a smaller spacing lead to better the enhancement effect of the substrate, which has the potential applications in the fields of biological or chemical molecular detection.
2022, 35: 143.
doi: 10.1186/s10033-022-00812-2
Abstract:
The recycling and remanufacturing of end-of-life products are significant for environmental protection and resource conservation. Disassembly is an essential process of remanufacturing end-of-life products. Effective disassembly plans help improve disassembly efficiency and reduce disassembly costs. This paper studies a disassembly planning problem with operation attributes, in which an integrated decision of the disassembly sequence, disassembly directions, and disassembly tools are made. Besides, a mathematical model is formulated with the objective of minimizing the penalty cost caused by the changing of operation attributes. Then, a neighborhood modularization-based artificial bee colony algorithm is developed, which contains a modular optimized design. Finally, two case studies with different scales and complexities are used to verify the performance of the proposed approach, and experimental results show that the proposed algorithm outperforms the two existing methods within an acceptable computational time.
The recycling and remanufacturing of end-of-life products are significant for environmental protection and resource conservation. Disassembly is an essential process of remanufacturing end-of-life products. Effective disassembly plans help improve disassembly efficiency and reduce disassembly costs. This paper studies a disassembly planning problem with operation attributes, in which an integrated decision of the disassembly sequence, disassembly directions, and disassembly tools are made. Besides, a mathematical model is formulated with the objective of minimizing the penalty cost caused by the changing of operation attributes. Then, a neighborhood modularization-based artificial bee colony algorithm is developed, which contains a modular optimized design. Finally, two case studies with different scales and complexities are used to verify the performance of the proposed approach, and experimental results show that the proposed algorithm outperforms the two existing methods within an acceptable computational time.
2022, 35: 145.
doi: 10.1186/s10033-022-00815-z
Abstract:
Thin-walled parts are typically difficult-to-cut components due to the complex dynamics in cutting process. The dynamics is variant for part during machining, but invariant for machine tool. The variation of the relative dynamics results in the difference of cutting stage division and cutting parameter selection. This paper develops a novel method for whole cutting process optimization based on the relative varying dynamic characteristic of machining system. A new strategy to distinguish cutting stages depending on the dominated dynamics during machining process is proposed, and a thickness-dependent model to predict the dynamics of part is developed. Optimal cutting parameters change with stages, which can be divided by the critical thickness of part. Based on the dynamics comparison between machine tool and thickness-varying part, the critical thicknesses are predicted by an iterative algorithm. The proposed method is validated by the machining of three benchmarks. Good agreements have been obtained between prediction and experimental results in terms of stages identification, meanwhile, the optimized parameters perform well during the whole cutting process.
Thin-walled parts are typically difficult-to-cut components due to the complex dynamics in cutting process. The dynamics is variant for part during machining, but invariant for machine tool. The variation of the relative dynamics results in the difference of cutting stage division and cutting parameter selection. This paper develops a novel method for whole cutting process optimization based on the relative varying dynamic characteristic of machining system. A new strategy to distinguish cutting stages depending on the dominated dynamics during machining process is proposed, and a thickness-dependent model to predict the dynamics of part is developed. Optimal cutting parameters change with stages, which can be divided by the critical thickness of part. Based on the dynamics comparison between machine tool and thickness-varying part, the critical thicknesses are predicted by an iterative algorithm. The proposed method is validated by the machining of three benchmarks. Good agreements have been obtained between prediction and experimental results in terms of stages identification, meanwhile, the optimized parameters perform well during the whole cutting process.
2022, 35: 147.
doi: 10.1186/s10033-022-00817-x
Abstract:
Electric cable shovel (ECS) is a complex production equipment, which is widely utilized in open-pit mines. Rational valuations of load is the foundation for the development of intelligent or unmanned ECS, since it directly influences the planning of digging trajectories and energy consumption. Load prediction of ECS mainly consists of two types of methods: physics-based modeling and data-driven methods. The former approach is based on known physical laws, usually, it is necessarily approximations of reality due to incomplete knowledge of certain processes, which introduces bias. The latter captures features/patterns from data in an end-to-end manner without dwelling on domain expertise but requires a large amount of accurately labeled data to achieve generalization, which introduces variance. In addition, some parts of load are non-observable and latent, which cannot be measured from actual system sensing, so they can't be predicted by data-driven methods. Herein, an innovative hybrid physics-informed deep neural network (HPINN) architecture, which combines physics-based models and data-driven methods to predict dynamic load of ECS, is presented. In the proposed framework, some parts of the theoretical model are incorporated, while capturing the difficult-to-model part by training a highly expressive approximator with data. Prior physics knowledge, such as Lagrangian mechanics and the conservation of energy, is considered extra constraints, and embedded in the overall loss function to enforce model training in a feasible solution space. The satisfactory performance of the proposed framework is verified through both synthetic and actual measurement dataset.
Electric cable shovel (ECS) is a complex production equipment, which is widely utilized in open-pit mines. Rational valuations of load is the foundation for the development of intelligent or unmanned ECS, since it directly influences the planning of digging trajectories and energy consumption. Load prediction of ECS mainly consists of two types of methods: physics-based modeling and data-driven methods. The former approach is based on known physical laws, usually, it is necessarily approximations of reality due to incomplete knowledge of certain processes, which introduces bias. The latter captures features/patterns from data in an end-to-end manner without dwelling on domain expertise but requires a large amount of accurately labeled data to achieve generalization, which introduces variance. In addition, some parts of load are non-observable and latent, which cannot be measured from actual system sensing, so they can't be predicted by data-driven methods. Herein, an innovative hybrid physics-informed deep neural network (HPINN) architecture, which combines physics-based models and data-driven methods to predict dynamic load of ECS, is presented. In the proposed framework, some parts of the theoretical model are incorporated, while capturing the difficult-to-model part by training a highly expressive approximator with data. Prior physics knowledge, such as Lagrangian mechanics and the conservation of energy, is considered extra constraints, and embedded in the overall loss function to enforce model training in a feasible solution space. The satisfactory performance of the proposed framework is verified through both synthetic and actual measurement dataset.
2022, 35: 151.
doi: 10.1186/s10033-022-00822-0
Abstract:
In previous studies about the synchronization of vibrators, the restoring forces of springs are mainly treated as linear directly, whereas the nonlinear features are rarely considered in vibrating systems. To make up this drawback, a dynamical model of a nonlinear vibrating mechanical system with double rigid frames (RFs), driven by two vibrators, is proposed to explore the synchronization and stability of the system. In this paper, the nonlinearity is reflected in nonlinear restoring forces of springs characterized by asymmetrical piecewise linear, where the nonlinear stiffness of springs is linearized equivalently using the asymptotic method. Based on the average method and Hamilton's principle, the theory conditions to achieve synchronization and stability of two vibrators are deduced. After the theory analyses, some numerical qualitative analyses are given to reveal the coupling dynamical characteristics of the system and the relative motion properties between two RFs. Besides, some experiments are carried out to examine the validity of the theoretical results and the correctness of the numerical analyses results. Based on the comparisons of the theory, numeric and experiment, the ideal working regions of the system are suggested. Based on the present work, some new types of vibrating equipment, such as vibrating discharging centrifugal dehydrators/conveyers/screens, can be designed.
In previous studies about the synchronization of vibrators, the restoring forces of springs are mainly treated as linear directly, whereas the nonlinear features are rarely considered in vibrating systems. To make up this drawback, a dynamical model of a nonlinear vibrating mechanical system with double rigid frames (RFs), driven by two vibrators, is proposed to explore the synchronization and stability of the system. In this paper, the nonlinearity is reflected in nonlinear restoring forces of springs characterized by asymmetrical piecewise linear, where the nonlinear stiffness of springs is linearized equivalently using the asymptotic method. Based on the average method and Hamilton's principle, the theory conditions to achieve synchronization and stability of two vibrators are deduced. After the theory analyses, some numerical qualitative analyses are given to reveal the coupling dynamical characteristics of the system and the relative motion properties between two RFs. Besides, some experiments are carried out to examine the validity of the theoretical results and the correctness of the numerical analyses results. Based on the comparisons of the theory, numeric and experiment, the ideal working regions of the system are suggested. Based on the present work, some new types of vibrating equipment, such as vibrating discharging centrifugal dehydrators/conveyers/screens, can be designed.
2022, 35: 11.
doi: 10.1186/s10033-022-00680-w
Abstract:
2022, 35: 60.
doi: 10.1186/s10033-022-00741-0
Abstract:
Research on micro-machines is becoming popular. In this paper, the electric driving behavior of liquid metal columns in confining channel was studied. When the electric field was applied, the liquid metal near the negative electrode became flat, longer. The NaOH electrolyte (1.0 mol/L) could flow from the positive electrode to the negative electrode from a small space above the liquid metal column. Besides, the length and volume of the liquid metal would affect its motion and deformation behavior. Both cylindrical liquid column (R = 5 mm, L = 5 cm) and linear liquid column (R = 5 mm, L = 40 cm) exhibit deformable movements, which are similar to the bionic movements of earthworms. The electrically driven liquid metal in closed systems could provide a theoretical basis for droplet actuation in microtubes. It has a very wide application prospect in the field of micro-drive machines.
Research on micro-machines is becoming popular. In this paper, the electric driving behavior of liquid metal columns in confining channel was studied. When the electric field was applied, the liquid metal near the negative electrode became flat, longer. The NaOH electrolyte (1.0 mol/L) could flow from the positive electrode to the negative electrode from a small space above the liquid metal column. Besides, the length and volume of the liquid metal would affect its motion and deformation behavior. Both cylindrical liquid column (R = 5 mm, L = 5 cm) and linear liquid column (R = 5 mm, L = 40 cm) exhibit deformable movements, which are similar to the bionic movements of earthworms. The electrically driven liquid metal in closed systems could provide a theoretical basis for droplet actuation in microtubes. It has a very wide application prospect in the field of micro-drive machines.
2022, 35: 25.
doi: 10.1186/s10033-022-00687-3
Abstract:
Aiming at the requirement of the full-ocean-depth (operating water depth 11000 m) manned submersible to carry out the gas-tight sampling operation of the abyss seabed sediment, a kind of full-ocean-depth carrier submersible mechanical hand-held, full-ocean-depth gas-tight sediment sampler (GTSS) with the function of pressure-retaining and coring is designed. Firstly, the volume change model of pressure compensator is established, and it is pointed out that the volume of pressure compensator is about 16.14% equal to the volume of gas-tight sediment sampler (GTSS). Secondly, the pressure compensator is analyzed and calculated, and the relationship between the precharge pressure of the pressure compensator, the nominal volume of the pressure compensator and the pressure holding effect of the gas-tight sediment sampler (GTSS) is studied. The results show that with the increase of gas precharge pressure in the pressure compensator, the final pressure of the sampler also increases. Under the same precharge pressure condition, the larger the nominal volume of the pressure compensator, the greater the final pressure of the sampler. Finally, the air tightness test method is designed by using the developed gas tightness sampler of the full-ocean-depth product, and the change of the final pressure in the gas tight sampler under different precharge pressure is observed. The test results are consistent with the simulation results, indicating the correctness of the pressure compensation system (PCS) model.
Aiming at the requirement of the full-ocean-depth (operating water depth 11000 m) manned submersible to carry out the gas-tight sampling operation of the abyss seabed sediment, a kind of full-ocean-depth carrier submersible mechanical hand-held, full-ocean-depth gas-tight sediment sampler (GTSS) with the function of pressure-retaining and coring is designed. Firstly, the volume change model of pressure compensator is established, and it is pointed out that the volume of pressure compensator is about 16.14% equal to the volume of gas-tight sediment sampler (GTSS). Secondly, the pressure compensator is analyzed and calculated, and the relationship between the precharge pressure of the pressure compensator, the nominal volume of the pressure compensator and the pressure holding effect of the gas-tight sediment sampler (GTSS) is studied. The results show that with the increase of gas precharge pressure in the pressure compensator, the final pressure of the sampler also increases. Under the same precharge pressure condition, the larger the nominal volume of the pressure compensator, the greater the final pressure of the sampler. Finally, the air tightness test method is designed by using the developed gas tightness sampler of the full-ocean-depth product, and the change of the final pressure in the gas tight sampler under different precharge pressure is observed. The test results are consistent with the simulation results, indicating the correctness of the pressure compensation system (PCS) model.
2022, 35: 35.
doi: 10.1186/s10033-022-00689-1
Abstract:
With the increasingly more extensive application of the medical surgical robot in the clinic, higher requirements have been put forward for medical robots. The bone-attached robot, a popular orthopedic robot in recent years, has a tendency of miniaturization and refinement. Thus, a bone-attached parallel manipulator (PM) based on 6-UCU (universal-cylindrical-universal) configuration is proposed, which is characterized by small volume, compact structure, high precision and six-dimensional force feedback. To optimize the structure and make it more compact, the workspace of the 6-UCU PM is analyzed based on the analysis of three kinds of constraint, and workspace model is established through spherical coordinate search method. This study also analyzes the influence of structural parameters on workspace, which may contribute to improving the efficiency of design and ensuring small-sized robots possess relatively large workspace. Moreover, to improve the motion accuracy, an error modeling method is developed based on the structure of 6-UCU PMs. According to this established error model, the output pose error curves are drawn using MATLAB software when the structure parameters change, and the influence of the structure and pose parameters change on the output pose error of PMs is analyzed. The proposed research provides the instruction to design and analysis of small PMs such as bone-attached robots.
With the increasingly more extensive application of the medical surgical robot in the clinic, higher requirements have been put forward for medical robots. The bone-attached robot, a popular orthopedic robot in recent years, has a tendency of miniaturization and refinement. Thus, a bone-attached parallel manipulator (PM) based on 6-UCU (universal-cylindrical-universal) configuration is proposed, which is characterized by small volume, compact structure, high precision and six-dimensional force feedback. To optimize the structure and make it more compact, the workspace of the 6-UCU PM is analyzed based on the analysis of three kinds of constraint, and workspace model is established through spherical coordinate search method. This study also analyzes the influence of structural parameters on workspace, which may contribute to improving the efficiency of design and ensuring small-sized robots possess relatively large workspace. Moreover, to improve the motion accuracy, an error modeling method is developed based on the structure of 6-UCU PMs. According to this established error model, the output pose error curves are drawn using MATLAB software when the structure parameters change, and the influence of the structure and pose parameters change on the output pose error of PMs is analyzed. The proposed research provides the instruction to design and analysis of small PMs such as bone-attached robots.
2022, 35: 40.
doi: 10.1186/s10033-022-00719-y
Abstract:
Needle biopsy is an essential part of modern clinical medicine. The puncture accuracy and sampling success rate of puncture surgery can be effectively improved through virtual surgery. There are few three-dimensional puncture (3D) models, which have little significance for surgical guidance under complicated conditions and restrict the development of virtual surgery. In this paper, a 3D simulation of the muscle tissue puncture process is studied. Firstly, the mechanical properties of muscle tissue are measured. The Mooney-Rivlin (M-R) model is selected by considering the fitting accuracy and calculation speed. Subsequently, an accurate 3D dynamic puncture model is established. The failure criterion is used to define the breaking characteristics of the muscle, and the bilinear cohesion model defines the breaking process. Experiments with different puncture speeds are carried out through the built in vitro puncture platform. The experimental results are compared with the simulation results. The experimental and simulated reaction force curves are highly consistent, which verifies the accuracy of the model. Finally, the model under different parameters is studied. The simulation results of varying puncture depths and puncture speeds are analyzed. The 3D puncture model can provide more accurate model support for virtual surgery and help improve the success rate of puncture surgery.
Needle biopsy is an essential part of modern clinical medicine. The puncture accuracy and sampling success rate of puncture surgery can be effectively improved through virtual surgery. There are few three-dimensional puncture (3D) models, which have little significance for surgical guidance under complicated conditions and restrict the development of virtual surgery. In this paper, a 3D simulation of the muscle tissue puncture process is studied. Firstly, the mechanical properties of muscle tissue are measured. The Mooney-Rivlin (M-R) model is selected by considering the fitting accuracy and calculation speed. Subsequently, an accurate 3D dynamic puncture model is established. The failure criterion is used to define the breaking characteristics of the muscle, and the bilinear cohesion model defines the breaking process. Experiments with different puncture speeds are carried out through the built in vitro puncture platform. The experimental results are compared with the simulation results. The experimental and simulated reaction force curves are highly consistent, which verifies the accuracy of the model. Finally, the model under different parameters is studied. The simulation results of varying puncture depths and puncture speeds are analyzed. The 3D puncture model can provide more accurate model support for virtual surgery and help improve the success rate of puncture surgery.
2022, 35: 42.
doi: 10.1186/s10033-022-00722-3
Abstract:
Modern-day microtomy requires high precision equipment to thinly section biological tissues. The sectioned tissue must be of good quality not showing cutting tracks or so-called artefacts. The quality of these sections is dependent on the blade wear, which is related to the hardness of the tissue sample, cutting angle and cutting speed. A test rig has been designed and manufactured to allow these parameters to be controlled. This has allowed for the blade wear to be analysed and quantified, and this has been completed for both ultrasonically assisted and conventional cutting. The obtained results showed a 25.2% decrease in average blade roughness after 38 cuts when using the ultrasonically assisted cutting regime. The data also showed no adverse effect on the quality of the slides produced when using this cutting methodology. Finally, the cutting force measured for both cutting regimes showed that ultrasonically assisted cutting required less force compared to conventional cutting. With the reduction of surface roughness and force, it is possible to state that ultrasonically assisted cutting reduces the wear of the blade, thereby increasing the life of the blades. An increase of just 10% in blade life would yield a cost saving of approximately 25% thereby reducing the environmental and financial impact of microtomy.
Modern-day microtomy requires high precision equipment to thinly section biological tissues. The sectioned tissue must be of good quality not showing cutting tracks or so-called artefacts. The quality of these sections is dependent on the blade wear, which is related to the hardness of the tissue sample, cutting angle and cutting speed. A test rig has been designed and manufactured to allow these parameters to be controlled. This has allowed for the blade wear to be analysed and quantified, and this has been completed for both ultrasonically assisted and conventional cutting. The obtained results showed a 25.2% decrease in average blade roughness after 38 cuts when using the ultrasonically assisted cutting regime. The data also showed no adverse effect on the quality of the slides produced when using this cutting methodology. Finally, the cutting force measured for both cutting regimes showed that ultrasonically assisted cutting required less force compared to conventional cutting. With the reduction of surface roughness and force, it is possible to state that ultrasonically assisted cutting reduces the wear of the blade, thereby increasing the life of the blades. An increase of just 10% in blade life would yield a cost saving of approximately 25% thereby reducing the environmental and financial impact of microtomy.
2022, 35: 43.
doi: 10.1186/s10033-022-00708-1
Abstract:
Medical devices are a major component of precision medicine and play a key role in medical treatment, particularly with the rapid development of minimally invasive surgery and wearable devices. Their tissue contact properties strongly affect device performance and patient health (e.g., heat coagulation and slipperiness on surgical graspers). However, the design and optimization of these device surfaces are still indistinct and have no supporting principles. Under such conditions, natural surfaces with various unique functions can provide solutions. This review summarizes the current progress in natural functional surfaces for medical devices, including ultra-slipperiness and strong wet attachment. The underlying mechanisms of these surfaces are attributed to their coupling effects and featured micro-nano structures. Depending on various medical requirements, adaptable designs and fabrication methods have been developed. Additionally, various medical device surfaces have been validated to achieve enhanced contact properties. Based on these studies, a more promising future for medical devices can be achieved for enhanced precision medicine and human health.
Medical devices are a major component of precision medicine and play a key role in medical treatment, particularly with the rapid development of minimally invasive surgery and wearable devices. Their tissue contact properties strongly affect device performance and patient health (e.g., heat coagulation and slipperiness on surgical graspers). However, the design and optimization of these device surfaces are still indistinct and have no supporting principles. Under such conditions, natural surfaces with various unique functions can provide solutions. This review summarizes the current progress in natural functional surfaces for medical devices, including ultra-slipperiness and strong wet attachment. The underlying mechanisms of these surfaces are attributed to their coupling effects and featured micro-nano structures. Depending on various medical requirements, adaptable designs and fabrication methods have been developed. Additionally, various medical device surfaces have been validated to achieve enhanced contact properties. Based on these studies, a more promising future for medical devices can be achieved for enhanced precision medicine and human health.
2022, 35: 52.
doi: 10.1186/s10033-022-00740-1
Abstract:
Bone cutting is of importance in orthopaedic surgery but is also challenging due to its nature of brittleness—where severe mechanical and thermal damages can be introduced easily in conventional machining. Laser machining is a new technology that can allow for complex cut geometries whilst minimising surface defects i.e., smearing, which occur in mechanical methods. However, comparative studies on the influence of lasers with different pulse characteristics on necrotic damage and surface integrity have not been reported yet. This paper for the first time investigates the effects of laser type on the necrotic damage and surface integrity in fresh bovine cortical bone after ex-situ laser machining. Three lasers of different pulse widths, i.e., picosecond, nanosecond and continuous wave lasers have been investigated with different feed speeds tested to study the machining efficiency. The cutting temperature, and geometrical outputs have been measured to investigate the thermal influence on the cooling behaviour of the bone samples while high-speed imaging was used to compare the material removal mechanisms between a pulsed and continuous wave laser. Furthermore, an in-depth histological analysis of the subsurface has revealed that the nanosecond laser caused the largest necrotic depth, owing to the high pulse frequency limiting the dissipation of heat. It has also been observed that surface cracks positioned perpendicular to the trench direction were produced after machining by the picosecond laser, indicative of the photomechanical effect induced by plasma explosions. Therefore, the choice of laser type (i.e., in terms of its pulse width and frequency) needs to be critically considered for appropriate application during laser osteotomy with minimum damage and improved healing.
Bone cutting is of importance in orthopaedic surgery but is also challenging due to its nature of brittleness—where severe mechanical and thermal damages can be introduced easily in conventional machining. Laser machining is a new technology that can allow for complex cut geometries whilst minimising surface defects i.e., smearing, which occur in mechanical methods. However, comparative studies on the influence of lasers with different pulse characteristics on necrotic damage and surface integrity have not been reported yet. This paper for the first time investigates the effects of laser type on the necrotic damage and surface integrity in fresh bovine cortical bone after ex-situ laser machining. Three lasers of different pulse widths, i.e., picosecond, nanosecond and continuous wave lasers have been investigated with different feed speeds tested to study the machining efficiency. The cutting temperature, and geometrical outputs have been measured to investigate the thermal influence on the cooling behaviour of the bone samples while high-speed imaging was used to compare the material removal mechanisms between a pulsed and continuous wave laser. Furthermore, an in-depth histological analysis of the subsurface has revealed that the nanosecond laser caused the largest necrotic depth, owing to the high pulse frequency limiting the dissipation of heat. It has also been observed that surface cracks positioned perpendicular to the trench direction were produced after machining by the picosecond laser, indicative of the photomechanical effect induced by plasma explosions. Therefore, the choice of laser type (i.e., in terms of its pulse width and frequency) needs to be critically considered for appropriate application during laser osteotomy with minimum damage and improved healing.
2022, 35: 55.
doi: 10.1186/s10033-022-00732-1
Abstract:
At present, dental implant surgery mainly relies on the clinical experience of the doctor and the assistance of preoperative medical imaging. However, there are some problems in dental implant surgery, such as narrow space, sight obstruction, inaccurate positioning, and high requirements of doctors' proficiency. Therefore, a dental implant robot system (DIRS) guided by optical navigation is developed in this study, with an x-shaped tool and an irregular pentagonal tracer are designed for spatial registration and needle tip positioning strategy respectively. The coordinate system of each unit in DIRS is unified through system calibration, spatial registration, and needle tip positioning strategy. Then the surgical path is planned on the computed tomography (CT) images in the navigation software before operation. The automatic positioning method and the auxiliary positioning method can be used in the operation to achieve accurate positioning and assist doctors to complete the operation. The errors of spatial registration, needle tip positioning strategy, and the overall accuracy of the system were evaluated respectively, and the results showed that they all met the needs of clinical surgery. This study preliminarily verified the feasibility of the precise positioning method for dental surgery robots and provided certain ideas for subsequent related research.
At present, dental implant surgery mainly relies on the clinical experience of the doctor and the assistance of preoperative medical imaging. However, there are some problems in dental implant surgery, such as narrow space, sight obstruction, inaccurate positioning, and high requirements of doctors' proficiency. Therefore, a dental implant robot system (DIRS) guided by optical navigation is developed in this study, with an x-shaped tool and an irregular pentagonal tracer are designed for spatial registration and needle tip positioning strategy respectively. The coordinate system of each unit in DIRS is unified through system calibration, spatial registration, and needle tip positioning strategy. Then the surgical path is planned on the computed tomography (CT) images in the navigation software before operation. The automatic positioning method and the auxiliary positioning method can be used in the operation to achieve accurate positioning and assist doctors to complete the operation. The errors of spatial registration, needle tip positioning strategy, and the overall accuracy of the system were evaluated respectively, and the results showed that they all met the needs of clinical surgery. This study preliminarily verified the feasibility of the precise positioning method for dental surgery robots and provided certain ideas for subsequent related research.
2022, 35: 56.
doi: 10.1186/s10033-022-00730-3
Abstract:
The insertion torque of a dental implant is an important indicator for the primary stability of dental implants. Thus, the preoperative prediction for the insertion torque is crucial to improve the success rate of implantation surgery. In this present research, an alternative method for prediction of implant torque was proposed. First, the mechanical model for the insertion torque was established based on an oblique cutting process. In the proposed mechanical model, three factors, including bone quality, implant geometry and surgical methods were considered in terms of bone-quality coefficients, chip load and insertion speeds, respectively. Then, the defined bone-quality coefficients for cancellous bone with the computed tomography (CT) value of 235–245, 345–355 and 415–425 Hu were obtained by a series of insertion experiments of IS and ITI implants. Finally, the insertion experiments of DIO implants were carried out to verify the accuracy of developed model. The predicted insertion torques calculated by the mechanical model were compared with those acquired by insertion experiments, with good agreement, the relative error being less than 15%. This method allows the insertion torque for different implant types to be quickly established and enhances prediction accuracy by considering the effects of implants' geometries and surgical methods.
The insertion torque of a dental implant is an important indicator for the primary stability of dental implants. Thus, the preoperative prediction for the insertion torque is crucial to improve the success rate of implantation surgery. In this present research, an alternative method for prediction of implant torque was proposed. First, the mechanical model for the insertion torque was established based on an oblique cutting process. In the proposed mechanical model, three factors, including bone quality, implant geometry and surgical methods were considered in terms of bone-quality coefficients, chip load and insertion speeds, respectively. Then, the defined bone-quality coefficients for cancellous bone with the computed tomography (CT) value of 235–245, 345–355 and 415–425 Hu were obtained by a series of insertion experiments of IS and ITI implants. Finally, the insertion experiments of DIO implants were carried out to verify the accuracy of developed model. The predicted insertion torques calculated by the mechanical model were compared with those acquired by insertion experiments, with good agreement, the relative error being less than 15%. This method allows the insertion torque for different implant types to be quickly established and enhances prediction accuracy by considering the effects of implants' geometries and surgical methods.
2022, 35: 61.
doi: 10.1186/s10033-022-00744-x
Abstract:
Efficient monitoring of bone milling conditions in orthopedic and neurosurgical surgery can prevent tissue, bone, and tool damage, and reduce surgery time. Current researches are mainly focused on recognizing the cutting state using force signal. However, the force signal during the milling process is difficult and expensive to acquire. In this study, a neural network-based method is proposed to recognize the cutting state and force during the bone milling process using sound signals. Numerical modeling of the cutting force is performed to capture the relationship between the cutting force and the depth of cut in the bone milling process. The force model is used to calibrate the training data to improve the recognition accuracy. Wavelet package transform is used for signal processing to understand bone-cutting phenomena using sound signals. The proposed system succeeds to monitor the bone milling process to reduce the surgical risk. Experiments on standard bone specimens and vertebrae also indicate that the proposed approach has considerable potential for use in computer-assisted and robot-assisted bone-cutting systems used in various types of surgery.
Efficient monitoring of bone milling conditions in orthopedic and neurosurgical surgery can prevent tissue, bone, and tool damage, and reduce surgery time. Current researches are mainly focused on recognizing the cutting state using force signal. However, the force signal during the milling process is difficult and expensive to acquire. In this study, a neural network-based method is proposed to recognize the cutting state and force during the bone milling process using sound signals. Numerical modeling of the cutting force is performed to capture the relationship between the cutting force and the depth of cut in the bone milling process. The force model is used to calibrate the training data to improve the recognition accuracy. Wavelet package transform is used for signal processing to understand bone-cutting phenomena using sound signals. The proposed system succeeds to monitor the bone milling process to reduce the surgical risk. Experiments on standard bone specimens and vertebrae also indicate that the proposed approach has considerable potential for use in computer-assisted and robot-assisted bone-cutting systems used in various types of surgery.
2022, 35: 65.
doi: 10.1186/s10033-022-00743-y
Abstract:
Minimally invasive surgery is an important technique used for cytopathological examination. Recently, multiple studies have been conducted on a three-dimensional (3D) puncture simulation model as it can reveal the internal deformation state of the tissue at the micro level. In this study, a viscoelastic constitutive equation suitable for muscle tissue was derived. Additionally, a method was developed to define the fracture characteristics of muscle tissue material during the simulation process. The fracture of the muscle tissue in contact with the puncture needle was simulated using the cohesive zone model and a 3D puncture finite element model was established to analyze the deformation of the muscle tissue. The stress nephogram and reaction force under different parameters were compared and analyzed to study the deformation of the biological soft tissue and guide the actual operation process and reduce pain.
Minimally invasive surgery is an important technique used for cytopathological examination. Recently, multiple studies have been conducted on a three-dimensional (3D) puncture simulation model as it can reveal the internal deformation state of the tissue at the micro level. In this study, a viscoelastic constitutive equation suitable for muscle tissue was derived. Additionally, a method was developed to define the fracture characteristics of muscle tissue material during the simulation process. The fracture of the muscle tissue in contact with the puncture needle was simulated using the cohesive zone model and a 3D puncture finite element model was established to analyze the deformation of the muscle tissue. The stress nephogram and reaction force under different parameters were compared and analyzed to study the deformation of the biological soft tissue and guide the actual operation process and reduce pain.
2022, 35: 89.
doi: 10.1186/s10033-022-00767-4
Abstract:
Biological soft tissues manipulation, including conventional (mechanical) and nonconventional (laser, waterjet and ultrasonic) processes, is critically required in most surgical innervations. However, the soft tissues, with their nature of anisotropic and viscoelastic mechanical properties, and high biological and heat sensitivities, are difficult to manipulated. Moreover, the mechanical and thermal induced damage on the surface and surrounding tissue during the surgery can impair the proliferative phase of healing. Thus, understanding the manipulation mechanism and the resulted surface damage is of importance to the community. In recent years, more and more scholars carried out researches on soft biological tissue cutting in order to improve the cutting performance of surgical instruments and reduce the surgery induced tissue damage. However, there is a lack of compressive review that focused on the recent advances in soft biological tissue manipulating technologies. Hence, this review paper attempts to provide an informative literature survey of the state-of-the-art of soft tissue manipulation processes in surgery. This is achieved by exploring and recollecting the different soft tissue manipulation techniques currently used, including mechanical, laser, waterjet and ultrasonic cutting and advanced anastomosis and reconstruction processes, with highlighting their governing removal mechanisms as well as the surface and subsurface damages.
Biological soft tissues manipulation, including conventional (mechanical) and nonconventional (laser, waterjet and ultrasonic) processes, is critically required in most surgical innervations. However, the soft tissues, with their nature of anisotropic and viscoelastic mechanical properties, and high biological and heat sensitivities, are difficult to manipulated. Moreover, the mechanical and thermal induced damage on the surface and surrounding tissue during the surgery can impair the proliferative phase of healing. Thus, understanding the manipulation mechanism and the resulted surface damage is of importance to the community. In recent years, more and more scholars carried out researches on soft biological tissue cutting in order to improve the cutting performance of surgical instruments and reduce the surgery induced tissue damage. However, there is a lack of compressive review that focused on the recent advances in soft biological tissue manipulating technologies. Hence, this review paper attempts to provide an informative literature survey of the state-of-the-art of soft tissue manipulation processes in surgery. This is achieved by exploring and recollecting the different soft tissue manipulation techniques currently used, including mechanical, laser, waterjet and ultrasonic cutting and advanced anastomosis and reconstruction processes, with highlighting their governing removal mechanisms as well as the surface and subsurface damages.
2022, 35: 91.
doi: 10.1186/s10033-022-00769-2
Abstract:
Cortical bone is semi-brittle and anisotropic, that brings a challenge to suppress vibration and avoid undesired fracture in precise cutting process in surgeries. In this paper, a novel analytical model is proposed to represent cortical bone cutting processes. The model is utilized to predict the chip formations, material removal behavior and cracks propagation under varying bone osteon cutting angles and depths. Series of orthogonal cutting experiments were conducted on cortical bone to investigate the impact of bone osteon cutting angle and depth of cut on cutting force, crack initialization and propagation. The observed chip morphology highly agreed with the prediction of chip formation based on the analytical model. The curly, serrated, grainy and powdery chips formed when the cutting angle was set as 0°, 60°, 90°, and 120°, respectively. Cortical bone were removed dominantly by shearing at a small depth of cut from 10 to 50 μm, and by a mixture of pealing, shearing, fracture and crushing at a large depth of cut over 100 μm at different bone osteon angles. Moreover, its fracture toughness was calculated based on measured cutting force. It is found that the fluctuation of cutting force is suppressed and the bone material becomes easy to remove, which attributes to lower fracture toughness at bone osteon cutting angle 0°. When the cutting direction develops a certain angle to bone osteon, the fracture toughness increases then the crack propagation is inhibited to some extent and the fluctuation of cutting force comparatively decreases. There is a theoretical and practical significance for tools design and operational parameters choice in surgeries.
Cortical bone is semi-brittle and anisotropic, that brings a challenge to suppress vibration and avoid undesired fracture in precise cutting process in surgeries. In this paper, a novel analytical model is proposed to represent cortical bone cutting processes. The model is utilized to predict the chip formations, material removal behavior and cracks propagation under varying bone osteon cutting angles and depths. Series of orthogonal cutting experiments were conducted on cortical bone to investigate the impact of bone osteon cutting angle and depth of cut on cutting force, crack initialization and propagation. The observed chip morphology highly agreed with the prediction of chip formation based on the analytical model. The curly, serrated, grainy and powdery chips formed when the cutting angle was set as 0°, 60°, 90°, and 120°, respectively. Cortical bone were removed dominantly by shearing at a small depth of cut from 10 to 50 μm, and by a mixture of pealing, shearing, fracture and crushing at a large depth of cut over 100 μm at different bone osteon angles. Moreover, its fracture toughness was calculated based on measured cutting force. It is found that the fluctuation of cutting force is suppressed and the bone material becomes easy to remove, which attributes to lower fracture toughness at bone osteon cutting angle 0°. When the cutting direction develops a certain angle to bone osteon, the fracture toughness increases then the crack propagation is inhibited to some extent and the fluctuation of cutting force comparatively decreases. There is a theoretical and practical significance for tools design and operational parameters choice in surgeries.
2022, 35: 102.
doi: 10.1186/s10033-022-00774-5
Abstract:
2022, 35: 106.
doi: 10.1186/s10033-022-00773-6
Abstract:
Needles, as some of the most widely used medical devices, have been effectively applied in human disease prevention, diagnosis, treatment, and rehabilitation. Thin 1D needle can easily penetrate cells/organs by generating highly localized stress with their sharp tips to achieve bioliquid sampling, biosensing, drug delivery, surgery, and other such applications. In this review, we provide an overview of multiscale needle fabrication techniques and their biomedical applications. Needles are classified as nanoneedles, microneedles and millineedles based on the needle diameter, and their fabrication techniques are highlighted. Nanoneedles bridge the inside and outside of cells, achieving intracellular electrical recording, biochemical sensing, and drug delivery. Microneedles penetrate the stratum corneum layer to detect biomarkers/bioelectricity in interstitial fluid and deliver drugs through the skin into the human circulatory system. Millineedles, including puncture, syringe, acupuncture and suture needles, are presented. Finally, conclusions and future perspectives for next-generation nano/micro/milli needles are discussed.
Needles, as some of the most widely used medical devices, have been effectively applied in human disease prevention, diagnosis, treatment, and rehabilitation. Thin 1D needle can easily penetrate cells/organs by generating highly localized stress with their sharp tips to achieve bioliquid sampling, biosensing, drug delivery, surgery, and other such applications. In this review, we provide an overview of multiscale needle fabrication techniques and their biomedical applications. Needles are classified as nanoneedles, microneedles and millineedles based on the needle diameter, and their fabrication techniques are highlighted. Nanoneedles bridge the inside and outside of cells, achieving intracellular electrical recording, biochemical sensing, and drug delivery. Microneedles penetrate the stratum corneum layer to detect biomarkers/bioelectricity in interstitial fluid and deliver drugs through the skin into the human circulatory system. Millineedles, including puncture, syringe, acupuncture and suture needles, are presented. Finally, conclusions and future perspectives for next-generation nano/micro/milli needles are discussed.
2022, 35: 112.
doi: 10.1186/s10033-022-00796-z
Abstract:
The simulation and planning system (SPS) requires accurate and real-time feedback regarding the deformation of soft tissues during the needle insertion procedure. Traditional mechanical-based models such as the finite element method (FEM) are widely used to compute the deformations of soft tissue. However, it is difficult for the FEM or other methods to find a balance between an acceptable image fidelity and real-time deformation feedback due to their complex material properties, geometries and interaction mechanisms. In this paper, a Kriging-based method is applied to model the soft tissue deformation to strike a balance between the accuracy and efficiency of deformation feedback. Four combinations of regression and correlation functions are compared regarding their ability to predict the maximum deformations of ten characteristic markers at a fixed insertion depth. The results suggest that a first order regression function with Gaussian correlation functions can best fit the results of the ground truth. The functional response of the Kriging-based method is utilized to model the dynamic deformations of markers at a series of needle insertion depths. The feasibility of the method is verified by investigating the adaptation to step variations. Compared with the ground truth of the finite element (FE) results, the maximum residual is less than 0.92 mm in the Y direction and 0.31 mm in the X direction. The results suggest that the Kriging metamodel provides real-time deformation feedback for a target and an obstacle to a SPS.
The simulation and planning system (SPS) requires accurate and real-time feedback regarding the deformation of soft tissues during the needle insertion procedure. Traditional mechanical-based models such as the finite element method (FEM) are widely used to compute the deformations of soft tissue. However, it is difficult for the FEM or other methods to find a balance between an acceptable image fidelity and real-time deformation feedback due to their complex material properties, geometries and interaction mechanisms. In this paper, a Kriging-based method is applied to model the soft tissue deformation to strike a balance between the accuracy and efficiency of deformation feedback. Four combinations of regression and correlation functions are compared regarding their ability to predict the maximum deformations of ten characteristic markers at a fixed insertion depth. The results suggest that a first order regression function with Gaussian correlation functions can best fit the results of the ground truth. The functional response of the Kriging-based method is utilized to model the dynamic deformations of markers at a series of needle insertion depths. The feasibility of the method is verified by investigating the adaptation to step variations. Compared with the ground truth of the finite element (FE) results, the maximum residual is less than 0.92 mm in the Y direction and 0.31 mm in the X direction. The results suggest that the Kriging metamodel provides real-time deformation feedback for a target and an obstacle to a SPS.
2022, 35: 41.
doi: 10.1186/s10033-022-00715-2
Abstract:
Sediments in the seabed hold vital clues to the study of marine geology, microbial communities and history of ocean life, and the remote operated vehicle (ROV) mounted tubular sampling is an important way to obtain sediments. However, sampling in the seabed is a particularly difficult and complicated task due to the difficulty accessing deep water layers. The sampling is affected by the sampler's structural parameters, operation parameters and the interaction between the sampling tube and sediments, which usually results in low volume and coring rate of sediments obtained. This paper simulated the soft viscous seabed sediments as non-Newtonian Herschel-Bulkley viscoplastic fluids and established a numerical model for the tubular sampling based on the volume of fluid (VOF) method. The influence rules of the sampling tube diameter, drainage area rate, penetration velocity, and sediments dynamic viscosity on coring rate and volume were studied. The results showed that coring volume was negatively correlated with all the parameters except the sampling tube diameter. Furthermore, coring rate decreased with increases in penetration velocity, drainage area rate, and sediments dynamic viscosity. The coring rate first increased and then decreased with increasing of the sampling tube diameter, and the peak value was also influenced by penetration velocity. Then, based on the numerical simulation results, an experimental sampling platform was set up and real-world sampling experiments were conducted. The simulation results tallied with the experimental results, with a maximum absolute error of only 4.6%, which verified that the numerical simulation model accurately reflected real-world sampling. The findings in this paper can provide a theoretical basis for facilitating the optimal design of the geometric structure of the seabed sediments samplers and the parameters in the sampling process.
Sediments in the seabed hold vital clues to the study of marine geology, microbial communities and history of ocean life, and the remote operated vehicle (ROV) mounted tubular sampling is an important way to obtain sediments. However, sampling in the seabed is a particularly difficult and complicated task due to the difficulty accessing deep water layers. The sampling is affected by the sampler's structural parameters, operation parameters and the interaction between the sampling tube and sediments, which usually results in low volume and coring rate of sediments obtained. This paper simulated the soft viscous seabed sediments as non-Newtonian Herschel-Bulkley viscoplastic fluids and established a numerical model for the tubular sampling based on the volume of fluid (VOF) method. The influence rules of the sampling tube diameter, drainage area rate, penetration velocity, and sediments dynamic viscosity on coring rate and volume were studied. The results showed that coring volume was negatively correlated with all the parameters except the sampling tube diameter. Furthermore, coring rate decreased with increases in penetration velocity, drainage area rate, and sediments dynamic viscosity. The coring rate first increased and then decreased with increasing of the sampling tube diameter, and the peak value was also influenced by penetration velocity. Then, based on the numerical simulation results, an experimental sampling platform was set up and real-world sampling experiments were conducted. The simulation results tallied with the experimental results, with a maximum absolute error of only 4.6%, which verified that the numerical simulation model accurately reflected real-world sampling. The findings in this paper can provide a theoretical basis for facilitating the optimal design of the geometric structure of the seabed sediments samplers and the parameters in the sampling process.
2022, 35: 63.
doi: 10.1186/s10033-022-00739-8
Abstract:
Compared with ordinary graphite anode, SnO2 possesses higher theoretical specific capacity, rich raw materials and low price. While the severe volume expansion of SnO2 during lithium-ion extraction/intercalation limits its further application. To solve this problem, in this work the reduced graphene oxide (rGO) was introduced as volume buffer matrix of SnO2. Herein, SnO2/rGO composite is obtained through one-step hydrothermal method. Three-dimensional structure of rGO could effectively hinder the polymerization of SnO2 nanoparticles and provide more lithium storage sites attributed to high specific surface area and density defects. The initial discharge capacity of the composite cathode is 959 mA·h·g-1 and the capacity remained at 300 mA·h·g-1 after 1000 cycles at 1 C. It proved that the rGO added in the anode has a capacity contribution to the lithium-ion battery. It changes the capacity contribution mechanism from diffusion process dominance to surface driven capacitive contribution. Due to the addition of rGO, the anode material gains stable structure and great conductivity.
Compared with ordinary graphite anode, SnO2 possesses higher theoretical specific capacity, rich raw materials and low price. While the severe volume expansion of SnO2 during lithium-ion extraction/intercalation limits its further application. To solve this problem, in this work the reduced graphene oxide (rGO) was introduced as volume buffer matrix of SnO2. Herein, SnO2/rGO composite is obtained through one-step hydrothermal method. Three-dimensional structure of rGO could effectively hinder the polymerization of SnO2 nanoparticles and provide more lithium storage sites attributed to high specific surface area and density defects. The initial discharge capacity of the composite cathode is 959 mA·h·g-1 and the capacity remained at 300 mA·h·g-1 after 1000 cycles at 1 C. It proved that the rGO added in the anode has a capacity contribution to the lithium-ion battery. It changes the capacity contribution mechanism from diffusion process dominance to surface driven capacitive contribution. Due to the addition of rGO, the anode material gains stable structure and great conductivity.
2022, 35: 84.
doi: 10.1186/s10033-022-00764-7
Abstract:
For hypereutectic Nb-Si based alloys, primary Nb5Si3 phases typically grow in a faceted mode during equilibrium or near-equilibrium solidification, which damages the ductility and toughness. To address this issue, here we artificially manipulate the growth morphology of Nb5Si3 using electron beam surface melting (EBSM) and subsequent annealing treatments. Results show that such a non-equilibrium solidification pathway enables the transition from faceted growth to non-faceted dendritic growth of Nb5Si3, along with evident microstructure refinement, generation of metastable β-Nb5Si3 phases and elimination of chemical segregation. The transformation from β-Nb5Si3 to α-Nb5Si3 and Nb solid solution (Nbss) particles is triggered by the annealing treatment at 1450 ℃ for 5 h. Also, we find the annealing-mediated formation of inherited Nb5Si3 dendrites that maintain the dendritic morphology of the original as-solidified β-Nb5Si3 dendrites. This work thus provides a feasible routine to obtain thermally stable and refined α-Nb5Si3 dendrites in hypereutectic Nb-Si based alloys.
For hypereutectic Nb-Si based alloys, primary Nb5Si3 phases typically grow in a faceted mode during equilibrium or near-equilibrium solidification, which damages the ductility and toughness. To address this issue, here we artificially manipulate the growth morphology of Nb5Si3 using electron beam surface melting (EBSM) and subsequent annealing treatments. Results show that such a non-equilibrium solidification pathway enables the transition from faceted growth to non-faceted dendritic growth of Nb5Si3, along with evident microstructure refinement, generation of metastable β-Nb5Si3 phases and elimination of chemical segregation. The transformation from β-Nb5Si3 to α-Nb5Si3 and Nb solid solution (Nbss) particles is triggered by the annealing treatment at 1450 ℃ for 5 h. Also, we find the annealing-mediated formation of inherited Nb5Si3 dendrites that maintain the dendritic morphology of the original as-solidified β-Nb5Si3 dendrites. This work thus provides a feasible routine to obtain thermally stable and refined α-Nb5Si3 dendrites in hypereutectic Nb-Si based alloys.
2022, 35: 96.
doi: 10.1186/s10033-022-00717-0
Abstract:
The resistance spot weldability of galvanized ultra-high-strength steels is not satisfied, the joints are prone to interfacial fracture and the weldable current range is narrow. To solve the problems, a novel method called resistance spot welding with double-sided cover sheets was introduced to weld a galvanized Q&P980 steel with the thickness of 1.2 mm. Two thin SPCC mild steel sheets were chosen as cover sheets and were placed symmetrically at both sides between the Q&P980 steels and the electrodes, then the RSW process was carried out. Compared with the traditional RSW method, the joints obtained by using the novel method achieved larger tensile shear strength and energy absorption, which increased by 26.9% and 52.6%, respectively. With increasing the welding current, the failure mode transferred from interfacial fracture to nugget pull-out fracture or base metal tearing fracture. By contrast, the joints always showed interfacial fracture without cover sheets. The improvement of the joint performance was mainly attributed to the enlargement of the nugget. With the help of finite element simulation, it was found that the cover sheets helped increase the contact area and reduced the current density during welding, which postponed the expulsion, and a larger area could be evenly heated. The application of the novel method can be easily extended to the resistance spot welding of other ultra-high-strength steels with various thicknesses.
The resistance spot weldability of galvanized ultra-high-strength steels is not satisfied, the joints are prone to interfacial fracture and the weldable current range is narrow. To solve the problems, a novel method called resistance spot welding with double-sided cover sheets was introduced to weld a galvanized Q&P980 steel with the thickness of 1.2 mm. Two thin SPCC mild steel sheets were chosen as cover sheets and were placed symmetrically at both sides between the Q&P980 steels and the electrodes, then the RSW process was carried out. Compared with the traditional RSW method, the joints obtained by using the novel method achieved larger tensile shear strength and energy absorption, which increased by 26.9% and 52.6%, respectively. With increasing the welding current, the failure mode transferred from interfacial fracture to nugget pull-out fracture or base metal tearing fracture. By contrast, the joints always showed interfacial fracture without cover sheets. The improvement of the joint performance was mainly attributed to the enlargement of the nugget. With the help of finite element simulation, it was found that the cover sheets helped increase the contact area and reduced the current density during welding, which postponed the expulsion, and a larger area could be evenly heated. The application of the novel method can be easily extended to the resistance spot welding of other ultra-high-strength steels with various thicknesses.
2022, 35: 110.
doi: 10.1186/s10033-022-00716-1
Abstract:
In this work, high-manganese aluminium bronze CuMn13Al7 samples were prepared by arc additive manufacturing technology. The phase composition, microstructure, and crystal structure of the high-manganese aluminium bronze CuMn13Al7 arc additive manufactured samples were analysed using direct-reading spectrometer, metallographic microscope, scanning electron microscope, and transmission electron microscope. The micro-hardness tester, tensile tester, impact tester, and electrochemical workstation were also used to test the performance of the CuMn13Al7 samples. By studying the microstructure and properties of the CuMn13Al7 samples, it was found that preparation of the samples by the arc additive manufacturing technology ensured good forming quality, almost no defects, and good metallurgical bonding inside the sample. The metallographic structure (α + β + point phase) mainly comprises the following: the metallographic structure in the equiaxed grain region has an obvious grain boundary α; the metallographic structure in the remelting region has no obvious grain boundary α; the thermal influence on the metallographic structure produced a weaker grain boundary α than the equiaxed grain region. The transverse and longitudinal cross sections of the sample had uniform microhardness distributions, and the average microhardness values were 190.5 HV0.1 and 192.7 HV0.1, respectively. The sample also had excellent mechanical properties: yield strength of 301 MPa, tensile strength of 633 MPa, elongation of 43.5%, reduction of area by 58%, Charpy impact value of 68 J/cm2 at – 20 ℃, and dynamic potential polarisation curve test results. Further, it was shown that the average corrosion potential of the sample was – 284.5 mV, and the average corrosion current density was 4.1×10–3 mA/cm2.
In this work, high-manganese aluminium bronze CuMn13Al7 samples were prepared by arc additive manufacturing technology. The phase composition, microstructure, and crystal structure of the high-manganese aluminium bronze CuMn13Al7 arc additive manufactured samples were analysed using direct-reading spectrometer, metallographic microscope, scanning electron microscope, and transmission electron microscope. The micro-hardness tester, tensile tester, impact tester, and electrochemical workstation were also used to test the performance of the CuMn13Al7 samples. By studying the microstructure and properties of the CuMn13Al7 samples, it was found that preparation of the samples by the arc additive manufacturing technology ensured good forming quality, almost no defects, and good metallurgical bonding inside the sample. The metallographic structure (α + β + point phase) mainly comprises the following: the metallographic structure in the equiaxed grain region has an obvious grain boundary α; the metallographic structure in the remelting region has no obvious grain boundary α; the thermal influence on the metallographic structure produced a weaker grain boundary α than the equiaxed grain region. The transverse and longitudinal cross sections of the sample had uniform microhardness distributions, and the average microhardness values were 190.5 HV0.1 and 192.7 HV0.1, respectively. The sample also had excellent mechanical properties: yield strength of 301 MPa, tensile strength of 633 MPa, elongation of 43.5%, reduction of area by 58%, Charpy impact value of 68 J/cm2 at – 20 ℃, and dynamic potential polarisation curve test results. Further, it was shown that the average corrosion potential of the sample was – 284.5 mV, and the average corrosion current density was 4.1×10–3 mA/cm2.
2022, 35: 137.
doi: 10.1186/s10033-022-00810-4
Abstract:
Laser cladding is a new surface repair method that can improve the wear and corrosion resistance of substrate surfaces. However, the cladding layer typically exhibits a rough surface, high hardness and large residual tensile stress, and thus requires further machining and finishing. Ultrasonic rolling (U-rolling) is a highly efficient finishing and strengthening process that combines ultrasonic technology with traditional rolling (T-rolling). In this study, an iron-based alloy was coated onto the surface of H13 die steel using laser cladding, and the surface of the cladding layer was polished using U-rolling. The effects of U-rolling on the surface quality, corrosion resistance and friction and wear properties of the laser-cladding layer were investigated and compared with those obtained by T-rolling. The surface roughness of the U-rolled sample was only 1/4 that of the T-rolled sample. The hardness and residual compressive stress of the laser cladding layer after U-rolling were higher than those after T-rolling. Similarly, the surface corrosion resistance of the laser cladding layer after U-rolling was higher than that after T-rolling. U-rolling changed the surface roughness, grain size, and residual stress of the material and thus affected the corrosion resistance of the laser cladding layer. The friction coefficient and wear rate of the U-rolled surface of the cladding layer were lower than those of the T-rolled surface. In addition, the tribological properties of the cladding layer were found to be related to the rolling direction. When the friction direction of the sample was the same as the rolling direction, its friction and wear performance were higher than those when the two directions were perpendicular.
Laser cladding is a new surface repair method that can improve the wear and corrosion resistance of substrate surfaces. However, the cladding layer typically exhibits a rough surface, high hardness and large residual tensile stress, and thus requires further machining and finishing. Ultrasonic rolling (U-rolling) is a highly efficient finishing and strengthening process that combines ultrasonic technology with traditional rolling (T-rolling). In this study, an iron-based alloy was coated onto the surface of H13 die steel using laser cladding, and the surface of the cladding layer was polished using U-rolling. The effects of U-rolling on the surface quality, corrosion resistance and friction and wear properties of the laser-cladding layer were investigated and compared with those obtained by T-rolling. The surface roughness of the U-rolled sample was only 1/4 that of the T-rolled sample. The hardness and residual compressive stress of the laser cladding layer after U-rolling were higher than those after T-rolling. Similarly, the surface corrosion resistance of the laser cladding layer after U-rolling was higher than that after T-rolling. U-rolling changed the surface roughness, grain size, and residual stress of the material and thus affected the corrosion resistance of the laser cladding layer. The friction coefficient and wear rate of the U-rolled surface of the cladding layer were lower than those of the T-rolled surface. In addition, the tribological properties of the cladding layer were found to be related to the rolling direction. When the friction direction of the sample was the same as the rolling direction, its friction and wear performance were higher than those when the two directions were perpendicular.
2022, 35: 140.
doi: 10.1186/s10033-022-00807-z
Abstract:
Bimetallic copper-steel composite could be an effective structural material to improve the performance of traditional nickel-aluminum bronze (NAB) ship propeller due to its high structural strength and corrosion resistance. In this work, the defect-free NAB coatings has been successfully fabricated by laser direct depositing technique on the 17-4PH stainless steel substrate. The phase constitution, microstructure characteristics and hardness properties were investigated in details. The XRD results showed that the coatings mainly consisted of α-Cu, Fe and intermetallic κ phases despite the diffraction peaks shifted more than 0.5°, which may due to the influence of the Ni, Fe and Al atoms dissolved into Cu-matrix. The microstructures of the coatings were affected significantly by laser energy density according to SEM and EDS results. The top region of the coating was more undercooled during solidification, therefore the grains at this region was much finer than that at the bottom region. The higher energy input would lead to coarser grains. Fe-rich dendrites and spherical particles were found in the Cu matrix, which could be a result of liquid separation. The hardness of the coating is in the range of 204 HV0.2–266 HV0.2 which is higher than traditional as- cast NAB. The uneven distribution of Fe-rich phases as well as the hard κ phases could be the main reasons for the fluctuations of the hardness value. Tensile fracture occurred at bronze side, not at transition zone, which shows there is a good interfacial bonding between the two metals produced by laser cladding.
Bimetallic copper-steel composite could be an effective structural material to improve the performance of traditional nickel-aluminum bronze (NAB) ship propeller due to its high structural strength and corrosion resistance. In this work, the defect-free NAB coatings has been successfully fabricated by laser direct depositing technique on the 17-4PH stainless steel substrate. The phase constitution, microstructure characteristics and hardness properties were investigated in details. The XRD results showed that the coatings mainly consisted of α-Cu, Fe and intermetallic κ phases despite the diffraction peaks shifted more than 0.5°, which may due to the influence of the Ni, Fe and Al atoms dissolved into Cu-matrix. The microstructures of the coatings were affected significantly by laser energy density according to SEM and EDS results. The top region of the coating was more undercooled during solidification, therefore the grains at this region was much finer than that at the bottom region. The higher energy input would lead to coarser grains. Fe-rich dendrites and spherical particles were found in the Cu matrix, which could be a result of liquid separation. The hardness of the coating is in the range of 204 HV0.2–266 HV0.2 which is higher than traditional as- cast NAB. The uneven distribution of Fe-rich phases as well as the hard κ phases could be the main reasons for the fluctuations of the hardness value. Tensile fracture occurred at bronze side, not at transition zone, which shows there is a good interfacial bonding between the two metals produced by laser cladding.

E-mail Alerts
E-mail Alerts
